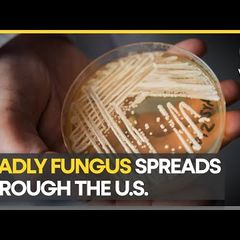

| |
Video News Review at 11 a.m. Daily
Current Video News:
https://www.inoreader.com/stream/user/1006407045/tag/YouTube%20subscriptions/view/html?cs=m&sb=y
Selected Articles Review From The News And Times -
https://thenewsandtimes.blogspot.com/
Current Selected Articles: https://www.inoreader.com/stream/user/1006407045/tag/user-favorites/view/html
All Current Articles: https://www.inoreader.com/stream/user/1006407045/tag/all-articles/view/html |
|
|
|
 | COVID origins intel to be declassified l GMA |
| President Joe Biden signed a bill on Monday that directs the government to declassify material on the... |
 ABC News ABC News | 2m | |
|
|
|
 | Republicans defend Trump ahead of possible indictment |
| Republicans decried a possible indictment of former president Donald Trump on March 19 and 20, at times... |
 Washington Post Washington Post | 4m | |
|
|
|
 | UnivisionNoticias's YouTube Videos: 🔴 EN VIVO: Empleados de escuelas de Los Ángeles... |
| ... |
 Puerto Rico News Videos from Michael_Novakhov (20 sites) Puerto Rico News Videos from Michael_Novakhov (20 sites) | 8m | |
|
|
|
 | UnivisionNoticias's YouTube Videos: 🔴 En vivo ViX: La Voz de la Mañana 10:00 A.M.,... |
| ... |
 Puerto Rico News Videos from Michael_Novakhov (20 sites) Puerto Rico News Videos from Michael_Novakhov (20 sites) | 8m | |
|
|
|
 | Moment skier with broken leg rescued from Spanish mountain in dangerous conditions |
| Despite the adverse weather conditions, specialists evacuated a person from Spanish mountain who suffered... |
 The Independent The Independent | 9m | |
|
|
|
 | Putin hails China's plan to settle 'acute crisis' in Ukraine during meeting with... |
| Russian president Vladimir Putin welcomed Chinese leader Xi Jinping to the Kremlin on Monday 20 March,... |
 The Independent The Independent | 9m | |
|
|
|
 | Putin welcomes Xi Kremlin with pomp |
| (21 Mar 2023) Russian President Putin warmly welcomed Chinese leader Xi Jinping to Kremlin sending powerful... |
 Associated Press Associated Press | 10m | |
|
|
|
 | Pioneros Culinarios: Un viaje a Hawaii para conocer sus lazos con los latinos |
| ¿Cowboys hispanos en Hawaii? Recorrimos playas, ciudades y bosques tropicales para descubrir esta y otras... |
 Univision Noticias Univision Noticias | 10m | |
|
|
|
 | Pioneros Culinarios: En busca del sueño americano en la fría y lejana Alaska |
| Conocemos en Alaska a un diácono de la Iglesia Católica, un guía de caza, la dueña de un carrito de tacos... |
 Univision Noticias Univision Noticias | 10m | |
|
|
|
 | Pioneros Culinarios: Louisiana se enriquece aún más con el sabor y aporte hispano |
| Música, gastronomía e inmigración son parte fundamental de Louisiana. Recorremos varias de sus ciudades... |
 Univision Noticias Univision Noticias | 10m | |
|
|
|
 | Culinary Pioneers: Hispanics bring fresh flavors to Louisiana's food scene |
| Music, gastronomy and immigration are three fundamental elements of the spirit of Louisiana. We tour... |
 Univision Noticias Univision Noticias | 10m | |
|
|
|
 | Culinary Pioneers: In search of the American Dream in remote Alaska |
| In Alaska, we meet a Catholic deacon, a hunting guide, a taco truck owner and a small business owner.... |
 Univision Noticias Univision Noticias | 10m | |
|
|
|
 | Culinary Pioneers: A trip to meet Latinos across the islands of Hawaii |
| Hispanic cowboys in Hawaii? We visit beaches, cities and tropical rainforests to discover the stories... |
 Univision Noticias Univision Noticias | 10m | |
|
|
|
 | Pioneros Culinarios: Hispanos que han llevado el sabor de nuestras raíces a lugares... |
| Recorremos Estados Unidos en busca de hispanos que hayan llevado el sabor de nuestras raíces a lugares... |
 Univision Noticias Univision Noticias | 10m | |
|
|
|
 | Culinary Pioneers: Trailer |
| Culinary Pioneers / Pioneros Culinarios- Playlist https://youtube.com/playlist?list=PLIsWuqSba1Bu3sxbr5JMz1r3yR9FlDwEN... |
 Univision Noticias Univision Noticias | 10m | |
|
|
|
 | 🔴 EN VIVO: Empleados de escuelas de Los Ángeles hablan sobre huelga y cierre de planteles |
| Pese a que el cierre de escuelas es definitivo, el Distrito Escolar Unificado de Los Ángeles tiene la... |
 Univision Noticias Univision Noticias | 10m | |
|
|
|
 | Как Минобороны пытается заманить россиян на войну? |
| Федеральный центр направил в регионы плановые показатели по новому набору добровольцев. Как Минобороны... |
| |
|
|
|
 | Law enforcement bracing for possible pro-Trump protests |
| Law enforcement agencies are preparing for the possibility of a Manhattan grand jury indicting former... |
| |
|
|
|
 | Стас Пьеха попал в больницу |
| Российский певец Стас Пьеха угодил под капельницу. Музыкант заверил поклонников, что его состояние «у... |
 Комсомольская Правда Комсомольская Правда | 12m | |
|
|
|
 | US Existing-Home Sales Rise by Most Since Mid-2020 |
| US sales of previously owned homes rose in February by the most since mid-2020. Guy Johnson and Alix... |
 Bloomberg TV Markets and Finance Bloomberg TV Markets and Finance | 12m | |
|
|
|
 | Bond Market Betting on Rapid Rate Cuts: Newedge's Dawson |
| Newedge Wealth CIO Cameron Dawson says the moves in 2-year Treasuries are "unprecedented" during an interview... |
 Bloomberg TV Markets and Finance Bloomberg TV Markets and Finance | 12m | |
|
|
|
 | Cajon Pass: Rain, snow bring dangerous driving conditions |
| Wind and a rain/snow mix hit Hesperia Tuesday morning creating dangerous driving conditions. Chains are... |
 CBS Los Angeles CBS Los Angeles | 13m | |
|
|
|
 | Colombo's Singhalese sports club ground hosted 144th Battle of the Blues last week... |
| Colombo's Singhalese sports club ground hosted the 144th the Royal-Thomian or the Battle of the Blues... |
| |
|
|
|
 | Euro 2024 qualifiers: Everything you need to know | Latest English News | WION |
| The long road to Euro 2024 begins this week as 53 nations aim for a place in Germany next summer. With... |
| |
|
|
|
 | Martina Navratilova reveals she is 'cancer-free' | Latest English News | WION |
| Tennis legend Martina Navratilova, who was diagnosed with breast and throat cancer, has declared that... |
| |
|
|
|
 | New floating LNG terminal in the Italian port of Piombino I WION Shorts |
| The "Golar Tundra" floating storage & regasification unit arrived in the Italian port of Piombino.... |
| |
|
|
|
 | President Wickremesinghe: Sri Lanka no longer a bankrupt nation |
| The International Monetary Fund has agreed to a three billion dollar bail-out for Sri Lanka. The... |
| |
|
|
|
 | Nvidia set to reveal new A.I. technologies at the company's GTC developer conference |
| CNBC's 'Squawk on the Street' anchors break down what's expected from Nvidia's annual conference. |
 CNBC Television CNBC Television | 14m | |
|
|
|
 | Cramer's Mad Dash: Meta upgraded as Reels, Instagram turn out to be real revenue... |
| CNBC's Jim Cramer discusses Meta's upgrade from the Street. |
 CNBC Television CNBC Television | 14m | |
|
|
|
 | Fed pausing rate hikes is the most 'appropriate' thing to do, says J.P. Morgan's... |
| Kelsey Berro, JPMorgan Asset Management fixed income portfolio manager, joins 'Squawk Box' to discuss... |
 CNBC Television CNBC Television | 14m | |
|
|
|
 | Opening Bell: March 21, 2023 |
| Watch the opening bell for the Nasdaq and the New York Stock Exchange from March 21, 2023. |
 CNBC Television CNBC Television | 14m | |
|
|
|
 | Market's realizing the bank system is stabilizing and we're on the road to recovery |
| RBC's Gerard Cassidy wraps up today's bank headlines. With CNBC's Melissa Lee and the Fast Money traders,... |
 CNBC Television CNBC Television | 14m | |
|
|
|
 | There's a huge degree of difference between SVB and the typical regional bank |
| Chris Kotowski, managing director and sr. research analyst with Oppenheimer, joins CNBC's Jon Fortt and... |
 CNBC Television CNBC Television | 14m | |
|
|
|
 | The amount of volatility in the bond market is historic, says Gilbert Garcia |
| Gilbert Garcia, managing partner at Garcia, Hamilton and Associates, joins Jon Fortt and the 'CNBC Special:... |
 CNBC Television CNBC Television | 14m | |
|
|
|
 | Cramer's First Take: If banks buy other banks, they do quite well |
| CNBC's Jim Cramer reports on why the regional banks are performing well before Tuesday's opening bell. |
 CNBC Television CNBC Television | 14m | |
|
|
|
 | The Fed should go ahead with 25 bps rate hike: Fmr. Richmond Fed President Jeffrey... |
| Jeffrey Lacker, former president of the Federal Reserve Bank of Richmond, joins CNBC's 'Squawk Box' to... |
 CNBC Television CNBC Television | 14m | |
|
|
|
 | Putin-Xi formal talks underway as Russia, China look to strengthen ties |
| CNBC's Eunice Yoon reports on a meeting between two leaders from some of the world's largest countries... |
 CNBC Television CNBC Television | 14m | |
|
|
|
 | The Fed will eventually backstop all deposits, says Argus' Kevin Heal |
| Kevin Heal, fixed income strategist and senior analyst at Argus Research, joins 'Squawk Box' to discuss... |
 CNBC Television CNBC Television | 14m | |
|
|
|
 | LIVE: President Biden delivers remarks at the White House Conservation in Action... |
| President Joe Biden delivers remarks about conservation efforts in the United States at the White House... |
 CNBC Television CNBC Television | 14m | |
|
|
|
 | ABC News's YouTube Videos: Signs banking crisis may be easing l GMA |
| ... |
 Trump News TV from Michael_Novakhov (10 sites) Trump News TV from Michael_Novakhov (10 sites) | 14m | |
|
|
|
 | ABC News's YouTube Videos: New fallout after Trump claims arrest is imminent l GMA |
| ... |
 Trump News TV from Michael_Novakhov (10 sites) Trump News TV from Michael_Novakhov (10 sites) | 14m | |
|
|
|
 | ABC News's YouTube Videos: Google offers early access to Bard, its conversational... |
| ... |
 Trump News TV from Michael_Novakhov (10 sites) Trump News TV from Michael_Novakhov (10 sites) | 14m | |
|
|
|
 | ABC News's YouTube Videos: Miami Beach votes against new curfew restriction after... |
| ... |
 Trump News TV from Michael_Novakhov (10 sites) Trump News TV from Michael_Novakhov (10 sites) | 14m | |
|
|
|
 | Pensions: Le Havre industrial zone and port blocked | AFP |
| In Le Havre, the bridges and roundabouts leading to the industrial zone and the port are blocked, while... |
| |
|
|
|
 | No freedom on the horizon for Bangkok's 'mall gorilla' | AFP |
| Seven storeys above a shop floor hawking cheap perfume and nylon underwear, Thailand's "shopping mall... |
| |
|
|
|
 | Zelensky tells ICC 'world must see no one is above justice' | AFP |
| Ukrainian President Volodymyr Zelensky implores the International Criminal Court to ensure "accountability"... |
| |
|
|
|
 | PUTINS KIREG: Wagner-Söldner in Not! Jetzt bettelt Prigoschin bei den Russen verzweifelt... |
| PUTINS KIREG: Wagner-Söldner in Not! Jetzt bettelt Prigoschin bei den Russen verzweifelt um Hilfe .. |
| |
|
|
|
 | Political analysts on possible arrest of Donald Trump |
| Dan Cassino, a political science professor, joined PIX11 Morning News to explain the historical case... |
| |
|
|
|
 | Get a look at falcon chicks with new camera in NJ |
| The Port Authority has partnered with EarthCam to provide a public view into the domestic lives of peregrine... |
| |
|
|
|
 | Chips on the menu as Taiwan and Germany meet to discuss semi-conductors and AI |
| A German government minister is in Taiwan for two days of talks on education and research that could... |
 euronews (in English) euronews (in English) | 16m | |
|
|
|
 | Dieselgate: Owners of vehicles with illegal defeat devices due compensation, EU top... |
| The ruling by the European Court of Justice is another blow to the German car industry, which has been... |
 euronews (in English) euronews (in English) | 16m | |
|
|
|
 | Japan's PM Fumio Kishida meets Ukraine's President Zelensky in Kyiv - BBC News |
| Japanese Prime Minister Fumio Kishida is making a surprise trip to Kyiv to meet with President Volodymr... |
| |
|
|
|
 | Finland retains title as world's happiest country • FRANCE 24 English |
| For the sixth year running, Finland was named the world's happiest country in an annual UN-sponsored... |
 FRANCE 24 English FRANCE 24 English | 18m | |
|
|
|
 | Racism, bias, and discrimination in Germany | DW News |
| Almost everyone in Germany is convinced that racism is a problem here, according to recent studies. Everyday... |
 DW (English) DW (English) | 19m | |
|
|
|
 | Noticias Telemundo En La Noche, 21 de marzo 2023 | Noticias Telemundo |
| Video oficial de Noticias Telemundo. Mira lo último en las principales historias del día, más allá de... |
 NOTICIAS TELEMUNDO NOTICIAS TELEMUNDO | 20m | |
|
|
|
 | Combating narco-subs and narco-terrorism in the U.S. and abroad |
| After two suspected "narco-subs" were found by law enforcement officials, new questions have been raised... |
| |
|
|
|
 | Russian military's alleged war crime caught on camera |
| A 2022 attack by Russian forces on Ukrainian civilians near Izium, Ukraine, was caught on camera and... |
| |
|
|
|
 | Photos Show Teen Killer Aiden Fucci's Home After He Fatally Stabbed Cheerleader |
| A crime scene technician took the stand at Aiden Fucci's sentencing trial and detailed searching the... |
 LawNewz Network LawNewz Network | 21m | |
|
|
|
 | Cleaning products that are also safe for the planet | Morning in America |
| Jacob Palmer shares different products and tips you can use for your spring cleaning that won't harm... |
 NewsNation Now NewsNation Now | 24m | |
|
|
|
 | Expert: Remote work did not lead to SVB collapse | Morning in America |
| After Silicon Valley Bank collapsed last week, some have pointed to its employees working from home as... |
 NewsNation Now NewsNation Now | 24m | |
|
|
|
 | Federal Reserve expected to raise interest rates Tuesday | Morning in America |
| Lydia Moynihan says many people are weighing in saying interest rates don't need to be raised, but the... |
 NewsNation Now NewsNation Now | 24m | |
|
|
|
 | Graham on Putin and Xi Meeting and Attacks on Trump |
| |
 USSenLindseyGraham USSenLindseyGraham | 24m | |
|
|
|
 | Una veintena de poetas recitan en el Museo del Prado por el Día de la Poesía |
| Carlos Chaguaceda, director de comunicación del Museo del Prado, ha afirmado que han abierto el Museo... |
 Europa Press Europa Press | 25m | |
|
|
|
 | Trump's Indictment & Our Two-Tiered Justice System | Dr. Kevin Roberts on The Charlie... |
| Heritage President Dr. Kevin Roberts joined "The Charlie Kirk Show" to delve into some of the most pressing... |
 The Heritage Foundation The Heritage Foundation | 25m | |
|
|
|
 | Ukraine says it destroyed Russian cruise missiles in Crimea |
| #shorts #crimea #ukrainewar #ukraine #russia --- Times Radio brings you the latest breaking news,... |
 Times Radio Times Radio | 26m | |
|
|
|
 | How Trump's indictment could backfire on Democrats |
| "It might rekindle their affection for Trump if they think he's the subject of a politicised indictment."... |
 Times Radio Times Radio | 26m | |
|
|
|
 | The Buy Nothing Project |
| Liesl Clark & Rebecca Rockefeller started the Buy Nothing Project where people give away unwanted... |
| |
|
|
|
 | Dean's A-List Interview: Kiefer Sutherland on new series "Rabbit Hole" |
| Actor Kiefer Sutherland sits down for an interview with WGN Entertainment Reporter Dean Richards |
| |
|
|
|
 | WGN viewer Thomas Malatia plays the Second Chance Grand Prize Game! |
| All March, we're giving viewers a second chance at the Grand Prize Game. |
| |
|
|
|
 | Через суд с Mercedes-Benz взыщут компенсации за "термоокно" |
| Владельцам Мерседесов причитается компенсация от автопроизводителя, который установил в их дизельных... |
 euronews (на русском) euronews (на русском) | 27m | |
|
|
|
 | Trump attorney Joe Tacopina: It is mind boggling we are at this point |
| Trump attorney Joe Tacopina breaks down the possible indictment of former President Trump over alleged... |
| |
|
|
|
 | The battle for wild camping on Dartmoor: 'This is a ransom note' |
| Dartmoor National Park was the only place in England where there was a right to wild camp without seeking... |
 The Guardian The Guardian | 29m | |
|
|
|
 | Tailandia convoca elecciones generales para el 14 de mayo |
| Bangkok (Tailandia), 21 mar (EFE/EPA).- La Comisión Electoral de Tailandia convocó este martes las elecciones... |
 AGENCIA EFE AGENCIA EFE | 29m | |
|
|
|
 | The Problem with Populism #shorts |
| The Problem with Populism --- Become a Member: https://www.davidpakman.com/membership Become a... |
 David Pakman Show David Pakman Show | 30m | |
|
|
|
 | Signs banking crisis may be easing |
| ABC News chief business correspondent Rebecca Jarvis gives an update on the banking fiasco and how it... |
| |
|
|
|
 | New fallout after Trump claims arrest is imminent l GMA |
| ABC News' Aaron Katersky reports on signs that the Manhattan district attorney is wrapping up an investigation... |
| |
|
|
|
 | Google offers early access to Bard, its conversational AI chatbot |
| The company invites its Pixel superfans to try out Bard and offer feedback. SUBSCRIBE to ABC News... |
| |
|
|
|
 | |
| Michael Novakhov retweeted: This CIA doctor's team investigated the mysterious... |
 Tweets by @mikenov Tweets by @mikenov | 32m | |
|
|
|
 | |
| Putin and Xi Jinping - 10:05 AM 3/21/2023 thenewsandtimes.blogspot.com/2023/03/putin-… |
 Tweets by @mikenov Tweets by @mikenov | 32m | |
|
|
|
 | What China's New Peacemaker Diplomacy Means for the U.S. | WSJ |
| Chinese President Xi Jinping met Russia's Vladimir Putin in Moscow, and is expected to speak with Ukraine's... |
 Wall Street Journal Wall Street Journal | 32m | |
|
|
|
 | LIVE: Protest outside New York City courthouse ahead of possible Trump indictment |
| Demonstrators gather outside a Manhattan court ahead of a possible indictment of Donald Trump over an... |
| |
|
|
|
 | LIVE: Treasury Secretary Yellen speaks to bankers in Washington |
| U.S. Treasury Secretary Janet Yellen addresses the American Bankers Association's annual Washington Summit.... |
| |
|
|
|
 | March 21, 2023: Trump possible arrest, China and Russia meet, France protests, Fox... |
| 1. New York City braces for a possible indictment of Donald Trump with workers erecting barriers around... |
| |
|
|
|
 | Semi slams into NJ state trooper vehicles, no one was hurt #shorts |
| Check out more Eyewitness News - http://abc7ny.com/ Find us on social media: FACEBOOK: https://www.facebook.com/ABC7NY/... |
 Eyewitness News ABC7NY Eyewitness News ABC7NY | 34m | |
|
|
|
 | JUST IN: McCarthy Fires Back At Reporter Asking About Trump On Day Of Possible Indictment |
| At a press briefing earlier this morning, Speaker McCarthy took a question about former President Trump's... |
 Forbes Under 30 Forbes Under 30 | 34m | |
|
|
|
 | Trump Blasts 'Most Disgusting Witch Hunt In The History Of Our Country' Before Possible... |
| In a video released to social media early this morning, former President Trump slammed the "witch hunt"... |
 Forbes Under 30 Forbes Under 30 | 34m | |
|
|
|
 | Chilean and Mapuche Women Reflect on the 2019-2020 Social Uprising |
| A group of Chilean and Mapuche women who heavily participated in the 2019-2020 Chilean Uprisings and... |
 Latino Rebels Latino Rebels | 38m | |
|
|
|
 | 🔴 En vivo ViX: La Voz de la Mañana 10:00 A.M., 21de marzo de 2023 |
| En @VIX ésta y más noticias 24 horas Noticias 24/7 en ViX: https://bit.ly/3LBhvTK #ViX en redes... |
 Univision Noticias Univision Noticias | 39m | |
|
|
|
 | vozdeamerica's YouTube Videos: La agenda: Jurado que investiga a Donald Trump estaría... |
| ... |
 Puerto Rico News Videos from Michael_Novakhov (20 sites) Puerto Rico News Videos from Michael_Novakhov (20 sites) | 39m | |
|
|
|
 | Lorry crashes at high speed into police cars in New Jersey 🚔🇺🇸 #shorts |
| Click here to subscribe to The Independent: https://bit.ly/Subscribe-to-Independent About The Independent:... |
 The Independent The Independent | 41m | |
|
|
|
 | Casey report: Suella Braverman says she will hold Mark Rowley and Sadiq Khan 'to... |
| Suella Braverman said she will hold Mark Rowley and Sadiq Khan 'to account' in a statement in parliament... |
 The Independent The Independent | 41m | |
|
|
|
 | Russia delivers enriched Uranium to France | Nuclear fuel shipments bankrolling Ukraine... |
| On Monday, Russia delivered enriched uranium to France. A cargo ship unloaded cylinders of uranium from... |
| |
|
|
|
 | World of Africa Live: A revolution in Africa? | Protests in South Africa, Kenya,... |
| Next on #WorldofAfrica with Erik Njoka + A revolution in Africa? Opposition parties stage simultaneous... |
| |
|
|
|
 | India's largest rocket LVM3 to perform second commercial mission on March 26 | WION... |
| The Indian space agency has announced that its largest rocket LVM3 will be launched at 9am on March 26... |
| |
|
|
|
 | Watch The Last Word With Lawrence O'Donnell Highlights: March 20 |
| Watch highlights from The Last Word with Lawrence O'Donnell. » Subscribe to MSNBC: http://on.msnbc.com/SubscribeTomsnbc... |
| |
|
|
|
 | Как ордер осложнит Путину жизнь. О чем Кремль просит Си? Арестуют ли Трампа |
| Включайте Дождь в 18.00 мск. В эфире Екатерина Котрикадзе и новый выпуск «Котрикадзе иностранных дел».... |
| |
|
|
|
 | MidweekPolitics's YouTube Videos: The Problem with Populism #shorts |
| ... |
 Trump News TV from Michael_Novakhov (10 sites) Trump News TV from Michael_Novakhov (10 sites) | 42m | |
|
|
|
 | msnbcleanforward's YouTube Videos: Watch The Last Word With Lawrence O'Donnell Highlights:... |
| ... |
 Trump News TV from Michael_Novakhov (10 sites) Trump News TV from Michael_Novakhov (10 sites) | 42m | |
|
|
|
 | msnbcleanforward's YouTube Videos: John Kirby: Putin needs Xi because he's running... |
| ... |
 Trump News TV from Michael_Novakhov (10 sites) Trump News TV from Michael_Novakhov (10 sites) | 42m | |
|
|
|
 | FoxNewsChannel's YouTube Videos: Peter Doocy challenges John Kirby: 'Why did Biden... |
| ... |
 Trump News TV from Michael_Novakhov (10 sites) Trump News TV from Michael_Novakhov (10 sites) | 42m | |
|
|
|
 | msnbcleanforward's YouTube Videos: Trump, DeSantis strike a John Birch key in what... |
| ... |
 Trump News TV from Michael_Novakhov (10 sites) Trump News TV from Michael_Novakhov (10 sites) | 42m | |
|
|
|
 | 2 NYPD vehicles, trash set on fire in NYC: police |
| Two unoccupied NYPD vehicles and a pile of trash were set on fire Monday night in Manhattan, spurring... |
| |
|
|
|
 | Man, 29, shot and killed in Brooklyn: NYPD |
| Police are searching for the suspect who shot and killed a 29-year-old man in Brooklyn last week, police... |
| |
|
|
|
 | ATTENTAT IN HATTENHOFEN: Unbekannter schießt auf FDP-Kommunalpolitiker – Motive völlig... |
| In Hattenhofen in Baden-Württemberg ist ein FDP-Kommunalpolitiker durch mehrere Schüsse verletzt worden.... |
| |
|
|
|
 | Cindy Hsu celebrates National Single Parent Day |
| According to the Pew Research Center, the U.S. has the world's highest rate of children living in a single... |
 CBS New York CBS New York | 45m | |
|
|
|
 | "Fish in a Tree" shares girl's journey with dyslexia |
| There's a new play now showing at New York City Children's Theater, called "Fish in a Tree." |
 CBS New York CBS New York | 45m | |
|
|
|
 | Hello Spring! 🌸 #spring #classicalmusic |
| Spring is finally here! Flowers are blooming, birds are chirping, and the sun is finally out ☀️ What... |
 HALIDONMUSIC HALIDONMUSIC | 50m | |
|
|
|
 | Perspectives on the Willow Project's Approval |
| The Wilson Center's Polar Institute gathered a collection of perspectives about the Biden Administration's... |
 WoodrowWilsonCenter WoodrowWilsonCenter | 50m | |
|
|
|
 | Met Police review: Home Secretary response 'is dangerously complacent'- Labour |
| Shadow Home Secretary Yvette Cooper has addressed the Commons following Baroness Casey's review of the... |
| |
|
|
|
 | Revealed: Boris Johnson's partygate defence |
| Boris Johnson's written partygate defence has been published, ahead of his appearance in front of MPs... |
| |
|
|
|
 | Ron DeSantis takes a shot at Trump, drawing laughter |
| Breaking his silence on Donald Trump's legal troubles, Florida Gov. Ron DeSantis criticized the Manhattan... |
| |
|
|
|
 | WATCH LIVE: Gwyneth Paltrow Ski Crash Trial — Anderson v. Paltrow |
| ctress Gwyneth Paltrow is set to face off with a retired doctor in a civil trial starting March 21 over... |
 LawNewz Network LawNewz Network | 52m | |
|
|
|
 | "It's all lies!" | Was Putin, Or His "Body Double", Heckled During... |
| Vladimir Putin's visit to the occupied Ukrainian city of Mariupol on March 19 was projected as spontaneous... |
| |
|
|
|
 | ראש הממשלה נתניהו ביקר בבסיס הגיוס מיטב - הבקו"ם, בתל השומר |
| ראש הממשלה בנימין נתניהו ושר הביטחון יואב גלנט ביקרו היום בלשכת הגיוס מיטב, שבתל השומר, כחלק מיום גיוס... |
| |
|
|
|
 | Putin and Xi Jinping - 10:05 AM 3/21/2023 |
| Putin and Xi Jinping - 10:05 AM 3/21/2023Ukraine war live updates: Russian mercenaries say Kyiv is preparing... |
 The News And Times The News And Times | 53m | |
|
|
|
 | Miami Beach Mayor: 'We don't want spring break' | Morning in America |
| Commissioners in Miami Beach, Florida voted 4-3 to reject a second curfew for this weekend, even a violence... |
 NewsNation Now NewsNation Now | 54m | |
|
|
|
 | El nuevo decreto de los Mossos incorpora efectivos para luchar contra la corrupción |
| El conseller de Interior de la Generalitat, Joan Ignasi Elena, ha explicado que el nuevo decreto de los... |
 Europa Press Europa Press | 55m | |
|
|
|
 | Torres afirma que la moción de censura es un "esperpento surrealista" |
| Declaraciones del presidente del Gobierno de Canarias, Ángel Víctor Torres, quien ha afirmado este martes... |
 Europa Press Europa Press | 55m | |
|
|
|
 | Tamames reprocha a Sánchez el uso del Código Penal para beneficiar a amigos |
| El economista Ramón Tamames ha reprochado al presidente del Gobierno, Pedro Sánchez, que el Gobierno... |
 Europa Press Europa Press | 55m | |
|
|
|
 | Las empresas abordan los retos de la comunicación corporativa y las estrategias ESG |
| Integrar la comunicación de las medidas medioambientales, sociales y de gobierno corporativo, conocidas... |
 Europa Press Europa Press | 55m | |
|
|
|
 | Кто же взорвал "Северный поток"? |
| ссылка на источник - https://www.svoboda.org/a/32326802.html Кто был заинтересован в подрыве газопроводов... |
 Радио Свобода Радио Свобода | 56m | |
|
|
|
 | Через суд с Mercedes-Benz взыщут компенсации за "термоокно" |
| Владельцам Мерседесов причитается компенсация от автопроизводителя, который установил в их дизельных... |
 euronews (на русском) euronews (на русском) | 58m | |
|
|
|
 | Tom gets his second chance at the 'Grand Prize Game' |
| Tom gets his second chance at the 'Grand Prize Game' |
| |
|
|
|
 | 3-year Kennedy Expressway project officially underway |
| A major years-long construction project on the Kennedy Expressway in Chicago is officially underway —... |
| |
|
|
|
 | España prepara su duelo ante Noruega |
| Las Rozas (Madrid), 21 mar (EFE).- La selección española de fútbol ha entrenado este martes a puerta... |
 AGENCIA EFE AGENCIA EFE | 1h | |
|
|
|
 | Miami Beach votes against new curfew restriction after fatal shootings |
| The City of Miami Beach voted against extending curfew restrictions, a day after the city imposed an... |
 ABC News ABC News | 1h | |
|
|
|
 | John Kirby: Putin needs Xi because he's running out of ammunition |
| National Security Council coordinator for strategic communications at the White House, John Kirby, joins... |
| |
|
|
|
 | Trump, DeSantis strike a John Birch key in what they say, says author |
| Author and professor Matthew Dallek joins Morning Joe to discus his new book 'Birchers: How the John... |
| |
|
|
|
 | JUST IN: McCarthy, House GOP Leaders Hold Press Briefing On Day Trump Claims He'll... |
| Speaker McCarthy and House Republican leaders hold a press briefing detailing their legislative agenda... |
 Forbes Under 30 Forbes Under 30 | 1h | |
|
|
|
 | "Whoever wins this deal, your lives will never be the same." Are the cast... |
| |
| |
|
|
|
 | Trump Awaiting Arrest: Donald Trump travels to Florida ahead of indictment | LiveNOW... |
| Subscribe to LiveNOW from FOX! https://www.youtube.com/livenowfox?sub_confirmation=1 Where to watch... |
 FOX 10 Phoenix FOX 10 Phoenix | 1h | |
|
|
|
 | Watch in full: Suella Braverman gives statement on Casey review into Met Police's... |
| Suella Braverman gave a statement in the house of commons on the Casey report into police racism, misogyny... |
 The Independent The Independent | 1h | |
|
|
|
 | Live: Treasury Secretary Janet Yellen speaks to bankers in Washington |
| U.S. Treasury Secretary Janet Yellen addresses American Bankers Association's annual Washington Summit.... |
 The Independent The Independent | 1h | |
|
|
|
 | Russian SU-35 fighter jet intercepts two US B-52 nuclear bombers over Baltic Sea |
| Dramatic footage shows the moment a Russian fighter jet intercepted two US B-52 nuclear bombers over... |
 The Independent The Independent | 1h | |
|
|
|
 | Live: Anti-Trump protest outside New York court ahead of possible indictment |
| Watch live as anti-Trump protest outside New York court ahead of possible indictment. Click here... |
 The Independent The Independent | 1h | |
|
|
|
 | Entrenamiento para la guerra en un mundo virtual |
| (21 Mar 2023) Los ejércitos modernos pronto podrían aprender a ir a la guerra utilizando juegos de computadora.... |
 Associated Press Associated Press | 1h | |
|
|
|
 | Chinese nationals killed by Russian mercenaries in Central Africa? | WION Originals |
| Chinese nationals were killed in cold-blood in the Central African Republic. Gunmen stormed a Chinese-operated... |
| |
|
|
|
 | Will Donald Trump be arrested? New York cops tighten security ahead of possible historic... |
| New York police have tightened security ahead of a possible historic indictment of Donald Trump over... |
| |
|
|
|
 | IMF approves $3 billion in financial assistance for debt-ridden Sri Lanka | WION... |
| The IMF has approved a $3 billion bailout programme to help debt-ridden Sri Lanka overcome its economic... |
| |
|
|
|
 | Ex-Pak PM Imran Khan gets protective bail in terror cases | WION Dispatch |
| Former Pakistan Prime Minister Imran Khan secured protective bail from the Lahore High Court in three... |
| |
|
|
|
 | The aftermath of fatal shooting on Miami Beach I WION Shorts |
| Aerial video shows the aftermath of a deadly shooting during Spring Break at Miami Beach. The shooting... |
| |
|
|
|
 | WION Live Broadcast: World Latest English News | English News | International News... |
| WION Live Broadcast: U.S. releases drone crash footage | English News | International News | WION .. |
| |
|
|
|
 | CBSNewsOnline's YouTube Videos: LIVE: Latest News, Breaking Stories and Analysis... |
| ... |
 Trump News TV from Michael_Novakhov (10 sites) Trump News TV from Michael_Novakhov (10 sites) | 1h | |
|
|
|
 | NYC Panera Bread giving away free coffee for a year |
| The eatery will give 500 lucky New Yorkers the deal. The offer is good at the Panera Bread on 86th Street... |
 PIX11 News PIX11 News | 1h | |
|
|
|
 | The Fed has to be 'extremely focused' on price stability, says TD Securities' Priya... |
| Michael Kantrowitz, chief investment strategist and head of portfolio strategies at Piper Sandler, and... |
 CNBC Television CNBC Television | 1h | |
|
|
|
 | Neuberger Berman's Daniel Flax on FAANG stocks |
| Dan Flax, Neuberger Berman senior research analyst, joins 'Squawk Box' to discuss what's happening in... |
 CNBC Television CNBC Television | 1h | |
|
|
|
 | LIVE: White House press secretary Karine Jean-Pierre holds a briefing with reporters... |
| White House press secretary Karine Jean-Pierre holds a briefing with reporters on Tuesday. » Subscribe... |
 CNBC Television CNBC Television | 1h | |
|
|
|
 | Nothing is more expensive than free money, says fmr. Fed Governor Kevin Warsh |
| Kevin Warsh, Hoover Institute distinguished fellow and former Federal Reserve governor, joins 'Squawk... |
 CNBC Television CNBC Television | 1h | |
|
|
|
 | Fanatics scores 10-year deal with NHL to replace Adidas as the league's official... |
| Fanatics CEO Michael Rubin and NHL commissioner Gary Bettman join 'Squawk Box' to discuss the recent... |
 CNBC Television CNBC Television | 1h | |
|
|
|
 | CNBC Fed Survey: 72% respondents say Fed will hike |
| CNBC's Steve Liesman reports on news from the CNBC Federal Reserve survey. For access to live and exclusive... |
 CNBC Television CNBC Television | 1h | |
|
|
|
 | Sec. Yellen to defend government intervention into the banking system at Washington... |
| CNBC's Kayla Tausche reports on upcoming remarks from Treasury Secretary Janet Yellen at the American... |
 CNBC Television CNBC Television | 1h | |
|
|
|
 | Xi's trip to Russia: What it means to Moscow's economy |
| Dewardric McNeal, Longview Global managing director and CNBC contributor, joins 'Squawk Box' to discuss... |
 CNBC Television CNBC Television | 1h | |
|
|
|
 | RUMMELMORD IN MÜNSTER: Polizei veröffentlicht Fahndungsfoto - Spur führt nach Osteuropa |
| RUMMELMORD IN MÜNSTER: Polizei veröffentlicht Fahndungsfoto - Spur führt nach Osteuropa Ein 31-jähriger... |
| |
|
|
|
 | Senator Tammy Duckworth on spreading democracy #gzeroworld #shorts |
| |
 GZERO Media GZERO Media | 1h | |
|
|
|
 | Trump anticipates arrest, calls on his supporters to protest |
| Former US President Donald Trump has called on his supporters to stage mass protests, claiming he is... |
 TRT World TRT World | 1h | |
|
|
|
 | 'Bloomberg Surveillance: Early Edition' Full (03/21/23) |
| Bloomberg Surveillance: Early Edition, live from London and New York. Francine Lacqua, Anna Edwards,... |
 Bloomberg TV Markets and Finance Bloomberg TV Markets and Finance | 1h | |
|
|
|
 | Первый за четверть века визит немецкого министра на Тайвань |
| В Китае осудили визит, назвав его «злонамеренным» ЧИТАТЬ ДАЛЕЕ : https://ru.euronews.com/2023/03/21/taiwan-germany-visit... |
 euronews (на русском) euronews (на русском) | 1h | |
|
|
|
 | Peter Doocy challenges John Kirby: 'Why did Biden let this happen?' |
| South Carolina Sen. Lindsey Graham joins 'Fox & Friends' to discuss the relationship between Russia... |
 Fox News Fox News | 1h | |
|
|
|
 | LIVE: Latest News on March 21, 2023 | Prime Time with John Dickerson |
| We're covering all of the day's top stories and more on "Prime Time with John Dickerson." #news... |
 CBS News CBS News | 1h | |
|
|
|
 | LIVE: Top Political News on March 21, 2023 | "Red & Blue" |
| "Red & Blue" reports on the top political stories of the day. #news #politics #livenews .. |
 CBS News CBS News | 1h | |
|
|
|
 | Mbappé 'set to be named new France captain' • FRANCE 24 English |
| Paris St Germain forward Kylian Mbappé is set to be named the French national team's new captain, with... |
 FRANCE 24 English FRANCE 24 English | 1h | |
|
|
|
 | Ruling party claims victory in Nigeria local elections amid vote-buying accusations... |
| Nigeria's ruling party has won the majority of governorships contested in last weekend's elections, results showed Tuesday, following a ballot marred ... |
 FRANCE 24 English FRANCE 24 English | 1h | |
|
|
|
 | Student killed, hundreds arrested in Kenya protests • FRANCE 24 English |
| A university student in Kenya was killed and more than 200 people arrested in nationwideprotests against... |
 FRANCE 24 English FRANCE 24 English | 1h | |
|
|
|
 | La agenda: Jurado que investiga a Donald Trump estaría cerca del final de su trabajo |
| El gran jurado de Nueva York que investiga el caso de Donald Trump parece estar cerca del final de su... |
 Voz de América Voz de América | 1h | |
|
|
|
 | How far will China go in its partnership with Russia? | DW News |
| Beijing has refused to condemn Russia's full-scale invasion of Ukraine and has instead sought to present... |
 DW (English) DW (English) | 1h | |
|
|
|
 | Noticias Telemundo Mediodía, 21 de marzo de 2023 | Noticias Telemundo |
| Video oficial de Noticias Telemundo. Mira lo último en las principales historias del día, más allá de... |
 NOTICIAS TELEMUNDO NOTICIAS TELEMUNDO | 1h | |
|
|
|
 | Met Police: Officers 'hideously abused their powers,' says Home Secretary |
| Home Secretary Suella Braverman addressed the Commons following Baroness Casey's review of the Met Police.... |
 Sky News Sky News | 1h | |
|
|
|
 | Watch live: NATO Secretary-General Jens Stoltenberg presents NATO Annual Report |
| The NATO Secretary General Jens Stoltenberg presents the NATO Annual Report for 2022 at NATO's headquarters... |
 Sky News Sky News | 1h | |
|
|
|
 | Vittert: Trump "does best when he's counterpunching" | Morning in America |
| A New York grand jury will not vote Tuesday on whether to indict former President Donald Trump, sources... |
 NewsNation Now NewsNation Now | 1h | |
|
|
|
 | Trump grand jury will not vote Tuesday, sources say | Morning in America |
| The Manhattan grand jury will not vote Tuesday on whether to indict former President Donald Trump over... |
 NewsNation Now NewsNation Now | 1h | |
|
|
|
 | Sánchez afea a Tamames aceptar ser candidato de los "herederos de Blas Piñar" |
| El presidente del Gobierno, Pedro Sánchez, ha afeado hoy al candidato a la moción de censura presentada... |
 Europa Press Europa Press | 1h | |
|
|
|
 | Kepa (guardameta del Chelsea) "feliz" de estar en la Selección |
| El guardameta del Chelsea, Kepa Arrizabalaga, regresa a una convocatoria de España y habla antes del... |
 Europa Press Europa Press | 1h | |
|
|
|
 | Dani Carvajal y el VAR: "No vamos a dudar del sistema en ningún momento" |
| El jugador del Real Madrid Dani Carvajal aseguró este martes que no van a "poner en duda el sistema"... |
 Europa Press Europa Press | 1h | |
|
|
|
 | Department of State Daily Press Briefing - March 21, 2023 - 2:00 PM |
| Department Press Briefing with Principal Deputy Spokesperson Vedant Patel, at the Department of State,... |
 U.S. Department of State U.S. Department of State | 1h | |
|
|
|
 | Wayne Newton is Broke Today #shorts #waynenewton |
| #shorts #broke #waynenewton Not all of our videos can be shown to a public YouTube audience. .. |
 Facts Verse Facts Verse | 1h | |
|
|
|
 | Mismo edificio pero nueva sede reformada para la Agencia Espacial Europea |
| París (Francia), 21 mar (EFE).- (Imagen: Christophe Petit-Tesson) La Agencia Espacial Europea (ESA) reestrena... |
 AGENCIA EFE AGENCIA EFE | 1h | |
|
|
|
 | Humza Yousaf: la independencia necesita una visión y no hablar de referéndums |
| Edimburgo (R.Unido), 21 mar (EFE).- (Imagen: Guillermo Garrido) Humza Yousaf, favorito en la carrera... |
 AGENCIA EFE AGENCIA EFE | 1h | |
|
|
|
 | 'Greater Israel' map provokes anger after minister's comments | Al Jazeera Newsfeed |
| There's been more condemnation of Israel's finance minister Bezalel Smotrich, after he stood behind a... |
 Al Jazeera English Al Jazeera English | 1h | |
|
|
|
 | Watch Rachel Maddow Highlights: March 20 |
| Watch highlights of Monday's The Rachel Maddow Show. » Subscribe to MSNBC: http://on.msnbc.com/SubscribeTomsnbc... |
| |
|
|
|
 | Ukraine war in maps: Kyiv is well positioned to regain the initiative and launch... |
| Ukraine war in maps: Kyiv is well positioned to regain the initiative and launch counteroffensives on... |
 euronews (in English) euronews (in English) | 1h | |
|
|
|
 | Stocks gain on hopes bank crisis is easing |
| Investors stepped cautiously into bank stocks, emboldened by the rescue of Credit Suisse, with share... |
 Reuters Reuters | 1h | |
|
|
|
 | Секретная копилка Путина на 55 млрд долларов | Илья Рождественский |
| Путинские друзья контролируют одну из крупнейших нефтяных компаний России. На её счетах — более четырех... |
 Штаб Навального Штаб Навального | 1h | |
|
|
|
 | Атака беспилотников в Джанкое | Новая волна репрессий | Как воруют мучители Навального |
| Ночью Крым атаковали беспилотники, в городе Джанкой ранен человек. В Москве силовики проводят обыски... |
 Штаб Навального Штаб Навального | 1h | |
|
|
|
 | UK Parliament committee publishes Boris Johnson's partygate evidence | WION Dispatch |
| British parliamentary committee has published evidence submitted by former prime minister Boris Johnson... |
| |
|
|
|
 | Meat shortages in Israel: Passovers around the corner, but meat isn't | WION Dispatch |
| Getting ready for Passover in Israel this holiday season might be a little harder this year due to some... |
| |
|
|
|
 | New IPCC report on climate change: UN Chief says humanity is on thin ice | Global... |
| The fourth and final instalment of the sixth assessment report by the intergovernmental panel on climate... |
| |
|
|
|
 | Russia flies two strategic bombers over Sea of Japan as Kishida visits Ukraine |... |
| Two Russian strategic bomber planes flew over the Sea of Japan for more than seven hours as Japanese... |
| |
|
|
|
 | UnivisionNoticias's YouTube Videos: En un minuto: La Casa Blanca pide calma ante... |
| ... |
 Puerto Rico News Videos from Michael_Novakhov (20 sites) Puerto Rico News Videos from Michael_Novakhov (20 sites) | 1h | |
|
|
|
 | vozdeamerica's YouTube Videos: Venezolanos emprenden "por necesidad" |
| ... |
 Puerto Rico News Videos from Michael_Novakhov (20 sites) Puerto Rico News Videos from Michael_Novakhov (20 sites) | 1h | |
|
|
|
 | ABC News's YouTube Videos: Bracing for potential trump indictment |
| ... |
 Trump News TV from Michael_Novakhov (10 sites) Trump News TV from Michael_Novakhov (10 sites) | 1h | |
|
|
|
 | ABC News's YouTube Videos: Start Here Podcast - March 21, 2023 | ABC News |
| ... |
 Trump News TV from Michael_Novakhov (10 sites) Trump News TV from Michael_Novakhov (10 sites) | 1h | |
|
|
|
 | Watch again: COP chiefs hold press conference to discuss global climate change action |
| Watch again as the heads of COP27 and COP28 hold a press conference on efforts to tackle climate change.... |
 The Independent The Independent | 1h | |
|
|
|
 | NYPD sets up barricades near Manhattan court ahead of possible Trump indictment |
| Footage shows the NYPD setting up barricades near a Manhattan courthouse as the city prepared for a possible... |
 The Independent The Independent | 1h | |
|
|
|
 | Penguins search for pebbles to woo females as mating season begins |
| Footage show male penguins searching for the perfect pebble to woo female birds with as mating season... |
 The Independent The Independent | 1h | |
|
|
|
 | Gang of balaclava-clad men armed with crowbars steal more than £3,000 from Surrey... |
| Surrey Police have released footage of men breaking into a Co-op shop and taking more than £3,000 in... |
 The Independent The Independent | 1h | |
|
|
|
 | Casey report: Suella Braverman says police betrayed 'public trust' |
| Suella Braverman said the Metropolitan police betrayed 'public trust' after Baroness Casey's report into... |
 The Independent The Independent | 1h | |
|
|
|
 | Boris Johnson seen for first time since Partygate defence dossier published |
| Former prime minister Boris Johnson leaves his house after accepting that he misled MPs but insisted... |
 The Independent The Independent | 1h | |
|
|
|
 | WATCH LIVE: Treasury Secretary Janet Yellen delivers remarks promising further support... |
| Stream your PBS favorites with the PBS app: https://to.pbs.org/2Jb8twG Find more from PBS NewsHour... |
 PBS NewsHour PBS NewsHour | 1h | |
|
|
|
 | Credit Suisse Bondholders Cry Foul Over $17 Billion Debt Wipeout |
| The takeover of Credit Suisse ends days of turmoil, which should be good news for investors -- but one... |
 TicToc by Bloomberg TicToc by Bloomberg | 1h | |
|
|
|
 | LIVE: Biden to announce new national monuments at conservation summit | NBC News |
| Watch live coverage as President Biden delivers remarks at the White House Conservation in Action Summit.... |
 NBC News NBC News | 1h | |
|
|
|
 | LIVE: White House holds press briefing | NBC News |
| Watch as White House Press Secretary Karine Jean-Pierre holds a press briefing. » Subscribe to NBC... |
 NBC News NBC News | 1h | |
|
|
|
 | Huge fire destroys church in New Jersey |
| More than 100 firefighters could not prevent a huge inferno from destroying the Fountain of Life Center... |
 NBC News NBC News | 1h | |
|
|
|
 | CHATGPT IN SCHULEN: Software für künstliche Intelligenz soll in Lehrpläne einfließen |
| CHATGPT IN SCHULEN: Software für künstliche Intelligenz soll in Lehrpläne einfließen Bildung in... |
| |
|
|
|
 | Man fatally shot outside Brooklyn store: NYPD |
| A 26-year-old man was gunned down outside Francena Mini Market at 1608 Sterling Place in Crown Heights,... |
 PIX11 News PIX11 News | 1h | |
|
|
|
 | Three suspects rob a Brooklyn deli at gunpoint: NYPD |
| Police are searching for three people in connection to the armed robbery of a Brooklyn deli Monday morning. |
 PIX11 News PIX11 News | 1h | |
|
|
|
 | Driver in Brooklyn crash that killed 2 arrested: NYPD |
| One of the drivers involved in a horrific Bensonhurst car crash that left two people dead and several... |
 PIX11 News PIX11 News | 1h | |
|
|
|
 | NYC subway station robbers put man in headlock: NYPD |
| A pair of crooks put a man in a headlock and robbed him on a Queens subway platform, police said in a... |
 PIX11 News PIX11 News | 1h | |
|
|
|
 | "The Young and the Restless" celebrates 50 years |
| There will be a special series of episodes to celebrate this Thursday on CBS2. |
 CBS New York CBS New York | 1h | |
|
|
|
 | Watch live: NATO Secretary General Jens Stoltenberg presents annual report for 2022... |
| NATO Secretary General Jens Stoltenberg presents the annual report for the year 2022. Subscribe:... |
 DW (English) DW (English) | 1h | |
|
|
|
 | China says will keep 'promoting political settlement' in Ukraine | AFP |
| As Chinese President Xi Jinping holds talks with his Russian counterpart Vladimir Putin in Moscow, foreign... |
| |
|
|
|
 | North Hollywood apartment complex fire consumes building |
| A massive fire is burning an apartment building on West Cumpston Street in North Hollywood between Camellia... |
 CBS Los Angeles CBS Los Angeles | 1h | |
|
|
|
 | Killer Cyclone Freddy, Drilling for Alaskan oil, Marine parks victims |
| A record-setting storm that lasts over a month kills hundreds. The US government's approval of an oil-drilling... |
 TRT World TRT World | 1h | |
|
|
|
 | More feared buried in Tarhouna mass graves |
| Between 2014 and 2020, the pro-Haftar Kani militia abducted hundreds of people from the Libyan town of... |
 TRT World TRT World | 1h | |
|
|
|
 | Treasury Secretary Janet Yellen discusses response to recent bank collapses | full... |
| Treasury Secretary Janet Yellen addressed the Biden administration's response to recent bank collapses... |
 CBS News CBS News | 1h | |
|
|
|
 | LIVE: Latest News, Breaking Stories and Analysis on March 21 | CBS News |
| The NYPD and other law enforcement agencies are prepping security plans in and around the Manhattan criminal... |
 CBS News CBS News | 1h | |
|
|
|
 | My life as a Palestinian fighter | Close Up |
| We gain rare access inside the Jenin Battalion, a new Palestinian armed group that's formed to fight... |
 Al Jazeera English Al Jazeera English | 1h | |
|
|
|
 | 'Go buy a suit': Senator wears Tame Impala shirt to doorstop interview |
| Independent Senator David Pocock "couldn't even put on a collared shirt" as he turned up to a doorstop... |
 SkyNewsAustralia SkyNewsAustralia | 1h | |
|
|
|
 | 'King Dan' Andrews confirms he won't make the Coronation a public holiday |
| The "reason" Victoria Premier Dan Andrews won't make the May 6 Coronation of King Charles a public holiday... |
 SkyNewsAustralia SkyNewsAustralia | 1h | |
|
|
|
 | Ongoing public transport issues faced by northern beaches residents to be a key concern... |
| Sky News host Jenna Clarke says the ongoing public transport issues faced by northern beaches residents,... |
 SkyNewsAustralia SkyNewsAustralia | 1h | |
|
|
|
 | Albanese could 'turn' around nuclear debate |
| Sky News host James Morrow says Prime Minister Anthony Albanese could be the one to bring nuclear energy... |
 SkyNewsAustralia SkyNewsAustralia | 1h | |
|
|
|
 | When the Chanting Stops |
| Protests following the murder of George Floyd in 2020 set the stage for people across the country to... |
| |
|
|
|
 | La integración de la ESG en la comunicación corporativa y la escucha activa, claves... |
| Integrar la comunicación de las medidas medioambientales, sociales y de gobierno corporativo (ESG) en... |
 Europa Press Europa Press | 1h | |
|
|
|
 | Salamanca convoca la segunda edición del Programa de Atracción del Talento |
| El alcalde de Salamanca, Carlos García Carbayo, ha presentado las bases del II programa de Atracción... |
 Europa Press Europa Press | 1h | |
|
|
|
 | El Fiscal General del Estado confía en que la circular sobre ley del sí es sí' esté... |
| El Fiscal General del Estado, Álvaro García Ortiz, ha reseñado que confía en que la nueva circular de... |
 Europa Press Europa Press | 1h | |
|
|
|
 | El juez Llarena confirma el procesamiento contra Puigdemont |
| El magistrado del Tribunal Supremo (TS) Pablo Llarena ha rechazado los recursos presentados tanto por... |
 Europa Press Europa Press | 1h | |
|
|
|
 | Generar confianza y combatir la desinformación: retos de la comunicación corporativa |
| Generar confianza en la empresa, innovar en los formatos de mensajes que se transmiten y combatir la... |
 Europa Press Europa Press | 1h | |
|
|
|
 | Tamames pide la palabra para interrumpir el discurso de Pedro Sánchez |
| El candidato de Vox para la moción de censura, el profesor Ramón Tamames, pide la palabra para interrumpir... |
 Europa Press Europa Press | 1h | |
|
|
|
 | Why Ukraine Fears A "Second Bakhmut" As Russia Pushes To Encircle Eastern... |
| Ukraine has said that the eastern town of Avdiivka could soon become a "second Bakhmut". Russia has launched... |
| |
|
|
|
 | Emotional return for freed French journalist Olivier Dubois • FRANCE 24 English |
| French journalist Olivier Dubois made an emotional return home on Tuesday following nearly two years in captivity in the Sahel, with President Emmanue... |
 FRANCE 24 English FRANCE 24 English | 1h | |
|
|
|
 | China's Xi says ties with Russia are a priority during Moscow trip • FRANCE 24 English |
| Chinese President Xi Jinping said Tuesday that China would prioritise ties with Russia, calling the two... |
 FRANCE 24 English FRANCE 24 English | 1h | |
|
|
|
 | In China's Yunnan province, forests provide haven for biodiversity • FRANCE 24 English |
| Located in south-western China, Yunnan province is the same size as Germany. It's home to almost 20,000... |
 FRANCE 24 English FRANCE 24 English | 1h | |
|
|
|
 | Biden signs bill on COVID origins declassification | Morning in America |
| President Biden signed a bipartisan bill Monday that directs the federal government to declassify as... |
 NewsNation Now NewsNation Now | 1h | |
|
|
|
 | Los Angeles school workers begin three-day walkout | Morning in America |
| Workers in America's second-largest school district began a three-day walkout Tuesday, shutting down... |
 NewsNation Now NewsNation Now | 1h | |
|
|
|
 | Met Police is "Institutionally Racist, Sexist and Broken": Key Findings... |
| 'Met Police is "Institutionally Racist, Sexist and Broken": Key Findings of Baroness Casey's Review'... |
| |
|
|
|
 | Boris Johnson admits he misled MPs over Partygate but insists it was 'unintentional' |
| "In a way, this 50 page dossier with very legalistic language might be treated by some as an attempt... |
 Times Radio Times Radio | 1h | |
|
|
|
 | Media is constantly being denied access to this administration: Failla |
| The 'Fox Across America' host weighs in after a shouting match erupted at Monday's White House press... |
 Fox News Fox News | 2h | |
|
|
|
 | El patrimonio iraquí, la milenaria víctima de la invasión estadounidense |
| Bagdad (Irak), 21 mar (EFE).- En abril de 2003, tras la toma de Bagdad por las tropas norteamericanas... |
 AGENCIA EFE AGENCIA EFE | 2h | |
|
|
|
 | Man found fatally shot in head in NYCHA building stairwell in Sheepshead Bay, Brooklyn |
| A man was found fatally shot inside the stairwell of a Brooklyn public housing complex. The man... |
 Eyewitness News ABC7NY Eyewitness News ABC7NY | 2h | |
|
|
|
 | Man injured after being pushed into side of moving 'R' train in Brooklyn |
| Police in Brooklyn are searching for a man who pushed another man into the side of a moving subway train.... |
 Eyewitness News ABC7NY Eyewitness News ABC7NY | 2h | |
|
|
|
 | Joe: There is no post-truth world when it comes to the court system |
| Four members of the Oath Keepers were convicted of conspiring to obstruct an official proceeding in connection... |
| |
|
|
|
 | Sri Lanka to get first slice of IMF bailout funds |
| Sri Lanka will get the first $330 million tranche of an International Monetary Fund bailout in the next... |
 Reuters Reuters | 2h | |
|
|
|
 | Latest weapons in use by the Zelensky's Ukraine against Russian invasion | Russia-Ukraine... |
| Ukrainian Military Arsenal Live: Have a look at military vehicles and equipment used by the Ukrainian... |
| |
|
|
|
 | Chinese city launches State-Sponsored Dating App | Latest English News |
| The app, called "Palm Guixi", includes a platform for organising blind dates, China Youth Daily, a state-run... |
| |
|
|
|
 | London's Met Police is racist, misogynistic and homophobic, says new report | Latest... |
| According to a damning report, the London's Metropolitan Police is institutionally racist, sexist and... |
| |
|
|
|
 | En un minuto: La Casa Blanca pide calma ante posibles protestas si Trump es detenido |
| En otras noticias, la Fed celebra a partir de este martes su más esperada reunión de los últimos tiempos;... |
 Univision Noticias Univision Noticias | 2h | |
|
|
|
 | Латвия запретила советские фильмы - Новодворская |
| |
 borovonovodvo borovonovodvo | 2h | |
|
|
|
 | Сталинград Коммунисты ВПК - Новодворская |
| |
 borovonovodvo borovonovodvo | 2h | |
|
|
|
 | Удар по Джанкою. Китайское счастье Путина. "Мемориал" кошмарят обысками.... |
| Ведущие программы Татьяна Фельгенгауэр и Александр Плющев вместе с русской редакцией DW выбирают темы,... |
 DW (Russian) DW (Russian) | 2h | |
|
|
|
 | msnbcleanforward's YouTube Videos: Joe: There is no post-truth world when it comes... |
| ... |
 Trump News TV from Michael_Novakhov (10 sites) Trump News TV from Michael_Novakhov (10 sites) | 2h | |
|
|
|
 | bbcnews's YouTube Videos: Warnings against 'reckless' weight loss surgery abroad... |
| ... |
 Trump News TV from Michael_Novakhov (10 sites) Trump News TV from Michael_Novakhov (10 sites) | 2h | |
|
|
|
 | "SÜDOSTLINK"-STROMTRASSEN: "Keine Unentschlossenheit mehr beim St |
| "SÜDOSTLINK"-STROMTRASSEN: "Keine Unentschlossenheit mehr beim Stromnetzausbau" - Robert Habeck Bundeswirtschaftsminister... |
| |
|
|
|
 | Biden issues first veto of presidency to block new investment rule |
| President Biden on Monday issued his first veto since taking office, rejecting a bipartisan measure that... |
 NBC News NBC News | 2h | |
|
|
|
 | This Morning's Top Headlines – March 21 | Morning News NOW |
| A New York grand jury weights whether to indict former President Trump over an alleged hush money payment... |
 NBC News NBC News | 2h | |
|
|
|
 | Unrest follows no-confidence vote in French government |
| More than 200 people were arrested across France on Monday evening, police said, after spontaneous protests... |
 NBC News NBC News | 2h | |
|
|
|
 | Biden signs bill to declassify Covid origins intelligence |
| As government agencies continue to investigate the origins of Covid-19, President Biden signed a bill... |
 NBC News NBC News | 2h | |
|
|
|
 | Grand jury weighs possible Trump indictment in Stormy Daniels hush money payment |
| As a New York grand jury weighs whether to indict former President Trump over an alleged hush money payment... |
 NBC News NBC News | 2h | |
|
|
|
 | NY Federal Judge: JPMorgan can be sued over Jefferey Epstein sex-trafficking claims |
| CNBC's Andrew Ross Sorkin reports on news from a New York federal judge. |
 CNBC Television CNBC Television | 2h | |
|
|
|
 | Sotheby's is launching a new auction series where mansions are sold like art |
| CNBC's Robert Frank reports on a new auction series at Sotheby's. |
 CNBC Television CNBC Television | 2h | |
|
|
|
 | Banks and Wall Street firms are essentially bundles of risk, says Ellevest CEO Sallie... |
| Sallie Krawcheck, Ellevest co-founder and CEO, joins CNBC's 'Squawk Box' to discuss how this current... |
 CNBC Television CNBC Television | 2h | |
|
|
|
 | Thieves break in and steal more than £3,000 from Surrey Co-op |
| Click here to subscribe to The Independent: https://bit.ly/Subscribe-to-Independent About The Independent:... |
 The Independent The Independent | 2h | |
|
|
|
 | Bracing for potential trump indictment |
| Police in several cities are on alert for potential unrest in case former President Donald Trump is indicted,... |
 ABC News ABC News | 2h | |
|
|
|
 | Start Here Podcast - March 21, 2023 | ABC News |
| #trump #climatechange #supremecourt A potential indictment of former President Trump galvanizes the... |
 ABC News ABC News | 2h | |
|
|
|
 | Man shoved into side of moving train in BK: NYPD |
| A 36-year-old man was pushed into the side of a moving R train in a subway station in Sunset Park on... |
 PIX11 News PIX11 News | 2h | |
|
|
|
 | Japan PM Kishida visits Bucha as part of Ukraine visit | AFP |
| Japan's Prime Minister Fumio Kishida visits Bucha, where Russian forces were accused of massacring civilians... |
| |
|
|
|
 | Exiled Russians Build New Life In Mongolia |
| Hundreds of thousands of Russians fled their country after it announced conscription for its war in Ukraine,... |
 Radio Free Europe/Radio Liberty Radio Free Europe/Radio Liberty | 2h | |
|
|
|
 | Chinese Leader Xi Holds Second Day Of Talks In Moscow |
| Chinese President Xi Jinping met with Russian Prime Minister Mikhail Mishustin on March 21 during the... |
 Radio Free Europe/Radio Liberty Radio Free Europe/Radio Liberty | 2h | |
|
|
|
 | Amazon planea eliminar 9,000 puestos de trabajo más #Shorts | Noticias Telemundo |
| Short oficial de Noticias Telemundo. En un comunicado interno, el director ejecutivo de la compañía,... |
 NOTICIAS TELEMUNDO NOTICIAS TELEMUNDO | 2h | |
|
|
|
 | Dos hermanos estadounidenses están desaparecidos en México #Shorts | Noticias Telemundo |
| Short oficial de Noticias Telemundo. Hugo Yarset, de 9, y Aranza Monfort, de 16 años, fueron reportados... |
 NOTICIAS TELEMUNDO NOTICIAS TELEMUNDO | 2h | |
|
|
|
 | En video: un incendio masivo devora una iglesia de Nueva Jersey #Shorts | Noticias... |
| Short oficial de Noticias Telemundo. Cuadrillas de bomberos combatían este lunes las gigantescas llamas,... |
 NOTICIAS TELEMUNDO NOTICIAS TELEMUNDO | 2h | |
|
|
|
 | Una exnovia de Bad Bunny lo demanda por $40 millones #Shorts | Noticias Telemundo |
| Short oficial de Noticias Telemundo. Carliz de la Cruz Hernández, cuya voz diciendo "Bad Bunny, baby"... |
 NOTICIAS TELEMUNDO NOTICIAS TELEMUNDO | 2h | |
|
|
|
 | BREAKING: Stormont brake 'practically useless' - group of Brexit-backing MPs |
| The European Research Group (ERG) has said the Stormont brake, a key feature of the new agreement which... |
 Sky News Sky News | 2h | |
|
|
|
 | Group Empowers Young African Women to Coach Basketball for Living |
| African Grassroots Hoops says with the sport growing rapidly on the continent, there's plenty of opportunity... |
 VOA News VOA News | 2h | |
|
|
|
 | Robot Detects Leaks, Saves Water |
| With much of the world grappling with a shortage of clean drinking water, a French company has developed... |
 VOA News VOA News | 2h | |
|
|
|
 | Watch Live: Killer Teen Sentencing -- FL v. Aiden Fucci -- Day One |
| Last month, 16-year-old Aiden Fucci pleaded guilty to murdering 13-year-old former classmate Tristyn... |
 LawNewz Network LawNewz Network | 2h | |
|
|
|
 | WATCH LIVE: Ice Cream Man Double Murder Retrial — FL v. Michael Keetley — Day 12 |
| Former ice cream truck driver Michael Keetley is facing a retrial for allegedly shooting six people on... |
 LawNewz Network LawNewz Network | 2h | |
|
|
|
 | WATCH LIVE: Obsessed Ex-Boyfriend Murder Trial — WI v. Zachariah Anderson - Day 15 |
| Wisconsin man Zachariah Anderson faces trial for charges in connection with the disappearance and death... |
 LawNewz Network LawNewz Network | 2h | |
|
|
|
 | Pesutto scores victory in bid to expel MP |
| Sky News host Jenna Clarke says the Liberal Party's decision to reject a delay in the vote to expel Moira... |
 SkyNewsAustralia SkyNewsAustralia | 2h | |
|
|
|
 | 'Put it away': Molly Meldrum exposes himself at Rod Stewart concert |
| Sky News host Paul Murray says Molly Meldrum should "put it away" after the music critic exposed himself... |
 SkyNewsAustralia SkyNewsAustralia | 2h | |
|
|
|
 | 'No one' raises an eyebrow at 'drug-addled' Hunter Biden |
| While Donald Trump claims he could soon be arrested, "no one raises an eyebrow" at the "drug-addled"... |
 SkyNewsAustralia SkyNewsAustralia | 2h | |
|
|
|
 | Trump indictment is a political 'witch hunt' |
| Compact Magazine Founder Sohrab Ahmari says the Manhattan District Attorney's attempts to indict Donald... |
 SkyNewsAustralia SkyNewsAustralia | 2h | |
|
|
|
 | Former minister Kim Carr express concerns over AUKUS pact |
| Sky News host Jenna Clarke says Labor's deep concerns about the AUKUS pact, expressed by federal MPs,... |
 SkyNewsAustralia SkyNewsAustralia | 2h | |
|
|
|
 | Critical 10 days ahead for Indigenous Voice to Parliament and Albanese government |
| Sky News host Jenna Clarke says the coming 10 days could prove critical for the future of an Indigenous... |
 SkyNewsAustralia SkyNewsAustralia | 2h | |
|
|
|
 | Ex-PMs Rudd and Turnbull have 'lost the plot' blaming media for their political failures |
| Former prime ministers Malcolm Turnbull and Kevin Rudd always "lash out" at News Corp for "their failures"... |
 SkyNewsAustralia SkyNewsAustralia | 2h | |
|
|
|
 | Labor's 'first break out' as MP criticises AUKUS project |
| Sky News Political Editor Andrew Clennell discusses Labor's "first break out" as Labor MP Josh Wilson... |
 SkyNewsAustralia SkyNewsAustralia | 2h | |
|
|
|
 | 'I think everyone would do that': Perrottet calls NSW Health Minister when wife needed... |
| The Daily Telegraph Tim Blair discusses Dominic Perrottet speaking with Health Minister Brad Hazzard... |
 SkyNewsAustralia SkyNewsAustralia | 2h | |
|
|
|
 | Miami Beach officials opt out of second spring break curfew | Morning in America |
| Miami Beach officials opted out of imposing a second curfew for spring breakers next weekend, saying... |
 NewsNation Now NewsNation Now | 2h | |
|
|
|
 | Homenaje a Elcano en el Muelle de Nueva York (Sevilla) para recordar la primera vuelta... |
| El presidente de la Autoridad Portuaria de Sevilla (APS), Rafael Carmona; el alcalde de Sevilla, Antonio... |
 Europa Press Europa Press | 2h | |
|
|
|
 | Tamames cita a Guerra para arremeter contra Sánchez por sus pactos con los que atacan... |
| El economista y profesor Ramón Tamames, candidato de Vox para su moción de censura, ha recurrido este... |
 Europa Press Europa Press | 2h | |
|
|
|
 | Hospital del Mar usa colorante para detectar células malignas en cirugías de metástasis... |
| El Hospital del Mar de Barcelona ha puesto en marcha un programa quirúrgico que utiliza un colorante,... |
 Europa Press Europa Press | 2h | |
|
|
|
 | 20 years on, Abu Ghraib survivor recalls torture by US forces | Al Jazeera Newsfeed |
| Twenty years after the Iraq War began, memories of torture by US soldiers have barely faded for Ali Shallal... |
 Al Jazeera English Al Jazeera English | 2h | |
|
|
|
| |
| news.google.com/rss/articles/C… |
 Tweets by @mikenov Tweets by @mikenov | 2h | |
|
|
|
 | Live: House Republicans speak to press |
| House Republicans hold a press briefing. #FoxNews Subscribe to Fox News! https://bit.ly/2vaBUvAS... |
 Fox News Fox News | 2h | |
|
|
|
 | 'TONE DEAF': 'Ted Lasso' cast visits White House amid crises |
| Fox News contributor Joe Concha joined 'Fox & Friends First' to discuss why he believes it is 'tone... |
 Fox News Fox News | 2h | |
|
|
|
 | Libya reignites debate over couscous with UNESCO bid | Al Jazeera Newsfeed |
| "It's part of our identity, our culture, our heritage and we're proud of it." Libyan couscous chefs are... |
 Al Jazeera English Al Jazeera English | 2h | |
|
|
|
 | Watch The ReidOut With Joy Reid Highlights: March 20 |
| Tune into The Reidout weekdays at 7 p.m. ET on MSNBC. » Subscribe to MSNBC: http://on.msnbc.com/SubscribeTomsnbc... |
| |
|
|
|
 | 6@6: Does squinting help us see better? |
| Have you ever wondered why squinting helps you see something more clearly? Contrary to the thought you... |
 WGN News WGN News | 2h | |
|
|
|
 | Firefighters rescued after ceiling collapses in house fire on Far Southeast Side |
| Four firefighters were injured while battling a house fire on the Far Southeast Side |
 WGN News WGN News | 2h | |
|
|
|
 | WION Sports Extra: Is Antonio Conte's time up at Tottenham hotspur? |
| Antonio Conte's reign as Tottenham Hotspur manager is nearing its end. The Italian's contract was due... |
| |
|
|
|
 | Russia's most lethal weapons in Ukraine: Tanks to hypersonic missiles | Russia-Ukraine... |
| Russia-Ukraine war live: Have a look at the new generations of weapons in which Russia says it is investing... |
| |
|
|
|
 | Festive spirit eludes bankrupt Pakistan | WION Speed News |
| Here we bring you a quick round-up of all latest news and top headlines from all across the globe. ... |
| |
|
|
|
 | Protesters burn trash French govt survives no-confidence vote I WION Shorts |
| Protesters set piles of rubbish on fire in central Paris on March 20. Protesters went in rage after the... |
| |
|
|
|
 | Lo mejor de La Voz de la Mañana del martes 21 de marzo de 2023 |
| Este martes crece la expectativa y la incertidumbre en Nueva York y Washington por las posibles protestas... |
 Univision Noticias Univision Noticias | 2h | |
|
|
|
 | У Путина сильная депрессия из-за ордера на арест | Валерий Соловей |
| В эфире политолог Валерий Соловей. Обсуждаем ордер на арест Путина и его поездку в Мариуполь, а говорим... |
 Штаб Навального Штаб Навального | 2h | |
|
|
|
 | ABC News's YouTube Videos: Automakers accused of failing to address spike in car... |
| ... |
 Trump News TV from Michael_Novakhov (10 sites) Trump News TV from Michael_Novakhov (10 sites) | 2h | |
|
|
|
 | ABC News's YouTube Videos: Dentist charged with poisoning wife |
| ... |
 Trump News TV from Michael_Novakhov (10 sites) Trump News TV from Michael_Novakhov (10 sites) | 2h | |
|
|
|
 | ABC News's YouTube Videos: Strike shuts down LA schools |
| ... |
 Trump News TV from Michael_Novakhov (10 sites) Trump News TV from Michael_Novakhov (10 sites) | 2h | |
|
|
|
 | msnbcleanforward's YouTube Videos: Watch All In With Chris Hayes Highlights: March... |
| ... |
 Trump News TV from Michael_Novakhov (10 sites) Trump News TV from Michael_Novakhov (10 sites) | 2h | |
|
|
|
 | Surveillance video shows Irvo Otieno's final moments |
| The Washington Post has published surveillance video showing the final moments of Irvo Otieno, the Black... |
 NBC News NBC News | 2h | |
|
|
|
 | On This Day - 20 March 2021 |
| (21 Mar 2023) In 1997, Jennifer Lopez's biographical drama "Selena" - about Tejano singer Selena Quintanilla... |
 Associated Press Associated Press | 2h | |
|
|
|
 | XI BESUCHT PUTIN: "War eine Illusion zu denken, China könnte auf der Seite des... |
| XI BESUCHT PUTIN: "War eine Illusion zu denken, China könnte auf der Seite des Westens tätig werden"... |
| |
|
|
|
 | UnivisionNoticias's YouTube Videos: Lo mejor de La Voz de la Mañana del martes 21... |
| ... |
 Puerto Rico News Videos from Michael_Novakhov (20 sites) Puerto Rico News Videos from Michael_Novakhov (20 sites) | 2h | |
|
|
|
 | Watch again: Eurosceptic ERG group of Conservatives announce verdict on Sunak's EU... |
| Watch again as the European Research Group of Conservative MPs hold a press conference to announce their... |
 The Independent The Independent | 2h | |
|
|
|
 | Venezolanos emprenden "por necesidad" |
| El más reciente estudio Global Entrepreneurship Monitor (GEM Venezuela 2022), de la Universidad Católica... |
 Voz de América Voz de América | 2h | |
|
|
|
 | Signs of spring at Brooklyn Botanic Garden |
| What does the warm winter weather mean for this year's cherry blossom watch? |
 CBS New York CBS New York | 2h | |
|
|
|
 | Donors pledge seven billion euros for earthquake victims | DW News |
| It has been over a month since a pair of massive earthquakes shook Turkey and northern Syria, killing... |
 DW (English) DW (English) | 2h | |
|
|
|
 | Markina Brown's Weather Forecast (March 21) |
| Steady moderate to heavy rain Tuesday morning, high winds and widespread flood watch in effect through... |
 CBS Los Angeles CBS Los Angeles | 2h | |
|
|
|
 | LAUSD workers walk the picket line Tuesday morning |
| Striking LAUSD support staff workers with SEIU Local 99 and UTLA teachers walked a picket line outside... |
 CBS Los Angeles CBS Los Angeles | 2h | |
|
|
|
 | Buscan en Nuevo México trabajadores para dar cariño a osos #Shorts | Noticias Telemundo |
| Short oficial de Noticias Telemundo. El Gobierno de Nuevo México busca trabajadores para un puesto muy... |
 NOTICIAS TELEMUNDO NOTICIAS TELEMUNDO | 2h | |
|
|
|
 | Un estudiante mata a tiros a un compañero en Texas #Shorts | Noticias Telemundo |
| Short oficial de Noticias Telemundo. Las autoridades escolares informaron que todo comenzó fuera del... |
 NOTICIAS TELEMUNDO NOTICIAS TELEMUNDO | 2h | |
|
|
|
 | Empleados del distrito escolar de Los Ángeles van a huelga #Shorts | Noticias Telemundo |
| Short oficial de Noticias Telemundo. A partir de este martes a las 4:30 am y hasta el jueves, auxiliares... |
 NOTICIAS TELEMUNDO NOTICIAS TELEMUNDO | 2h | |
|
|
|
 | Las noticias de la mañana, martes 21 de marzo de 2023 | Noticias Telemundo |
| Video oficial de Noticias Telemundo. Aumentan medidas de seguridad en Nueva York ante la posible presentación... |
 NOTICIAS TELEMUNDO NOTICIAS TELEMUNDO | 2h | |
|
|
|
 | Boris Johnson accepts he misled parliament over partygate |
| Boris Johnson has said he accepts he misled parliament over partygate but insists his statements were... |
 Sky News Sky News | 2h | |
|
|
|
 | European Research Group members hold news conference on Windsor Framework agreement |
| Members of the ERG hold a news conference in the Thatcher Room in Portcullis House to announce the outcome... |
 Sky News Sky News | 2h | |
|
|
|
 | Sass is genetic 💁♀️ #Better #iPlayer |
| Everyone has their own version of right and wrong. A corrupt copper and a Leeds gangster are bound together... |
| |
|
|
|
 | First Republic shares fall 50% despite $30B rescue |
| Asia-Pacific markets are rising on the back of a global banking relief rally after the $3.2B takeover... |
 TRT World TRT World | 2h | |
|
|
|
 | Си Цзиньпин пригласил Путина и Мишустина посетить Китай |
| Как подчеркнул на встрече премьер-министр России, несмотря на неблагоприятную внешнюю конъюнктуру и усиливающиеся... |
 euronews (на русском) euronews (на русском) | 2h | |
|
|
|
 | People are 'so keen all the time' to drum up climate fear and anxiety |
| People are "so keen all the time" to drum up climate change fear and anxiety, says Sky News host Chris... |
 SkyNewsAustralia SkyNewsAustralia | 2h | |
|
|
|
 | RBA could pause rate rises within fortnight |
| Sky News host Jenna Clarke says the Reserve Bank's potential pause in monetary tightening may temporarily... |
 SkyNewsAustralia SkyNewsAustralia | 2h | |
|
|
|
 | If Trump is arrested he will be a 'hero' and 'guarantee' his presidential win: Farage |
| Former Brexit Leader and GB News Host Nigel Farage says he "hopes" Donald Trump is arrested as it will... |
 SkyNewsAustralia SkyNewsAustralia | 2h | |
|
|
|
 | 'Beastly': Harry and Meghan 'not entitled' to balcony at Coronation |
| King Charles "absolutely must not" give in to Harry and Meghan's demand to appear on the balcony at the... |
 SkyNewsAustralia SkyNewsAustralia | 2h | |
|
|
|
 | Matt Kean has 'gone so far left' people 'feel betrayed' |
| NSW One Nation Candidate Steve Busch discusses NSW Treasurer and Energy Minister Matt Kean Matt Kean's... |
 SkyNewsAustralia SkyNewsAustralia | 2h | |
|
|
|
 | Carbon tax will 'wipe out' critical Australian industries |
| A tax on carbon emissions will "wipe out" the steel, aluminium, and copper industries within Australia,... |
 SkyNewsAustralia SkyNewsAustralia | 2h | |
|
|
|
 | PM will 'ride the tiger' on 'gutsy' AUKUS deal: Bob Katter |
| Federal MP Bob Katter says the AUKUS deal was a "gutsy performance" by Prime Minister Anthony Albanese.... |
 SkyNewsAustralia SkyNewsAustralia | 2h | |
|
|
|
 | NSW Labor's electric campaign bus breaks down |
| Sky News host Liz Storer says the breakdown of NSW Labor's electric campaign bus, which ran out of battery... |
 SkyNewsAustralia SkyNewsAustralia | 2h | |
|
|
|
 | Reserve Bank to consider pausing next interest rate rise |
| The case to pause interest rate rises will be considered again when the Reserve Bank board meets in two... |
 SkyNewsAustralia SkyNewsAustralia | 2h | |
|
|
|
 | Disgruntled reporter interrupts White House briefing |
| Sky News host Paul Murray reviews the time a disgruntled reporter interrupted a White House briefing... |
 SkyNewsAustralia SkyNewsAustralia | 2h | |
|
|
|
 | 'Diesel to the rescue': NSW Labor's campaign electric runs flat |
| The Daily Telegraph Tim Blair says "it's always diesel to the rescue" after Labor's campaign electric... |
 SkyNewsAustralia SkyNewsAustralia | 2h | |
|
|
|
 | UN climate report a 'political' document to encourage governments to act a 'certain... |
| The Australian Environment Editor Graham Lloyd says the United Nations' climate report is merely a political... |
 SkyNewsAustralia SkyNewsAustralia | 2h | |
|
|
|
 | World's Most Inspirational Intense Orchestral Music | Best Epic Heroic Orchestral... |
| World's Most Inspirational Intense Orchestral Music | Best Epic Heroic Orchestral Music - Epic Music... |
 War Epic Music War Epic Music | 2h | |
|
|
|
 | Automakers accused of failing to address spike in car thefts |
| Attorneys general in 23 states said Hyundai and Kia are to blame for not including anti-theft features... |
 ABC News ABC News | 2h | |
|
|
|
 | Dentist charged with poisoning wife |
| Police in Colorado said the man poisoned his wife's protein shakes. ABC News' Andrew Dymburt reports. |
 ABC News ABC News | 2h | |
|
|
|
 | The legacy of the Soviet Gulag with 'Varlam' author Michael Prazan • FRANCE 24 English |
| The Gulag is synonymous with some of the worst mass human rights abuses of the 20th century, and also... |
 FRANCE 24 English FRANCE 24 English | 2h | |
|
|
|
 | Macron welcomes home French journalist Olivier Dubois held hostage in the Sahel •... |
| French President Emmanuel Macron welcomed freed journalist Olivier Dubois at midday on Tuesday on his... |
 FRANCE 24 English FRANCE 24 English | 2h | |
|
|
|
 | Ukraine Gets Ammunition Boost Against Russia As EU Approves €2 Billion Plan, US Pledges... |
| EU ministers have reached a deal to supply Ukraine with a million rounds of artillery shells over the... |
| |
|
|
|
 | More Americans are moving to Texas: Why? | Morning in America |
| More Americans are moving to Texas than any other state, with close to half a million people moving there... |
 NewsNation Now NewsNation Now | 2h | |
|
|
|
 | Forensic pathologist analyzes decision to examine Stephen Smith's body | Morning... |
| Dr. Priya Banerjee says to examine a body that has been buried for 8 years is difficult, but some new... |
 NewsNation Now NewsNation Now | 2h | |
|
|
|
 | Trump indictment? Voters divided ahead of 2024 bid | Morning in America |
| Amid the announcement that a New York grand jury won't vote Tuesday on whether to indict former President... |
 NewsNation Now NewsNation Now | 2h | |
|
|
|
 | Trump investigation: Impact of an indictment on Trump's political future | Morning... |
| The Manhattan grand jury will not vote Tuesday on whether to indict former President Donald Trump over... |
 NewsNation Now NewsNation Now | 2h | |
|
|
|
 | Jinping-Putin meeting sends united message to western countries | Morning in America |
| Russian President Vladimir Putin warmly welcomed Chinese leader Xi Jinping to the Kremlin on Monday,... |
 NewsNation Now NewsNation Now | 2h | |
|
|
|
 | Big tech in defensive mode as banks wobble |
| Amid banking worries, investors are looking for a safe haven and Keith Gangl of Gradient Investments... |
 Reuters Reuters | 2h | |
|
|
|
 | Pedro Sánchez y Santiago Abascal protagonizan el primer rifirrafe de la moción de... |
| La presidenta del Congreso, la socialista Meritxell Batet, ha abierto este martes el debate de la moción... |
 Europa Press Europa Press | 2h | |
|
|
|
 | Belarra dice que la moción se desarrolla de forma "predecible" |
| La ministra de Asuntos Sociales y Agenda 2030, Ione Belarra, quien ha manifestado que la moción de censura... |
 Europa Press Europa Press | 2h | |
|
|
|
 | 15 kilos de drogas incautados en Italia con las fotos de la mafia siciliana |
| Roma(Italia), 21 mar (EFE).- Los Carabinieros (policía militarizada) de Sicilia (sur de Italia) se han... |
 AGENCIA EFE AGENCIA EFE | 2h | |
|
|
|
 | Навороты танка Т-90М «Прорыв» |
| Командир танкового экипажа «Крепыш» показал приборы новейшей боевой машины. Он говорит, что техника устраивает... |
 Комсомольская Правда Комсомольская Правда | 3h | |
|
|
|
 | Алкоголь, соучастие в убийстве и психбольница: тяжелая судьба актера Игоря Петренко |
| Игорь Петренко никогда не скрывал, что в его жизни было много ошибок. В 15 он стал соучастником убийства,... |
 Комсомольская Правда Комсомольская Правда | 3h | |
|
|
|
 | Кортеж Си Цзиньпина в Москве |
| Десятки машин и мотоциклы. Так по Москве предвигается делегация из Китая. Председатель КНР Си Цзиньпин... |
 Комсомольская Правда Комсомольская Правда | 3h | |
|
|
|
 | Watch All In With Chris Hayes Highlights: March 20 |
| Get the latest news and commentary from Chris Hayes weekdays at 8 p.m. ET on MSNBC. » Subscribe to... |
| |
|
|
|
 | New IPCC report on climate change | Latest English News | WION |
| The fourth and final instalment of the sixth assessment report by the intergovernmental panel on climate... |
| |
|
|
|
 | Trump attends an event at Mar-a-Lago I WION Shorts |
| Former president Donald Trump was spotted at an event at his Mar-a-Lago resort on March 19. Trump urged... |
| |
|
|
|
 | The world's first AI art gallery opens in Amsterdam |
| The world's first AI art gallery opens in Amsterdam but has sparked controversy in the art world. .. |
 euronews (in English) euronews (in English) | 3h | |
|
|
|
 | Latest news bulletin | March 21st – Midday |
| Catch up with the most important stories from around Europe and beyond - latest news, breaking news,... |
 euronews (in English) euronews (in English) | 3h | |
|
|
|
 | French pension reform: outrage in Paris post no-confidence votes |
| Protesters are trying to pressure lawmakers to bring down the government and doom the unpopular retirement... |
 euronews (in English) euronews (in English) | 3h | |
|
|
|
 | Крым атаковали беспилотники. Обыски у сотрудников «Мемориала». Военкоматы ищут добровольцев |
| Включайте новости на Дожде в 15.00 мск. В эфире Анна Монгайт. В этом выпуске: В Москве силовики... |
 tvrainru tvrainru | 3h | |
|
|
|
 | JTF 2: Canada's elite special forces unit gets a $1.4 B upgrade to their training... |
| Speaking to journalists in Ottawa on Tuesday, Minister of National Defence Anita Anand made an announcement... |
 Global News Global News | 3h | |
|
|
|
 | FLUCHT INS EDELMETALL: Goldpreis überschreitet 2000-Dollar-Marke |
| FLUCHT INS EDELMETALL: Goldpreis überschreitet 2000-Dollar-Marke Die anhaltende Verunsicherung an... |
| |
|
|
|
 | Freedom Mortgage CEO: Housing affordability is going to continue to be a major concern |
| Stanley Middleman, CEO of Freedom Mortgage, one of the nation's largest non-bank mortgage lenders and... |
 CNBC Television CNBC Television | 3h | |
|
|
|
 | Katz: Investors can selectively buy into this bank turmoil and sell-off |
| David Katz of Matrix Asset Advisors says a silver lining from the turmoil in the banking sector is the... |
 CNBC Television CNBC Television | 3h | |
|
|
|
 | Porcelli: The Fed should not raise rates in March, but will likely hike by 25 bps |
| RBC Capital Markets Chief Economist Tom Porcelli explains his expectations for the March FOMC meeting.... |
 CNBC Television CNBC Television | 3h | |
|
|
|
 | Shah: Real assets and alternatives provide inflation mitigation and stability |
| Seema Shah, Chief Global Strategist at Principal Asset Management, discusses her investment thesis. For... |
 CNBC Television CNBC Television | 3h | |
|
|
|
 | Warnings against 'reckless' weight loss surgery abroad - BBC News |
| Seven British patients who travelled to Turkey for weight loss surgery died after operations there, a... |
 BBC News BBC News | 3h | |
|
|
|
 | Live: COP chiefs hold press conference to discuss global climate change action |
| Watch live as the heads of COP27 and COP28 hold a press conference on efforts to tackle climate change.... |
 The Independent The Independent | 3h | |
|
|
|
 | Live: Eurosceptic ERG group of Conservatives announce verdict on Sunak's EU deal |
| Watch live as the European Research Group of Conservative MPs hold a press conference to announce how... |
 The Independent The Independent | 3h | |
|
|
|
 | Know before you go: Tuesday, March 21 |
| Chris Wragge, Mary Calvi and Elise Finch have the latest news and weather headlines from CBS2. |
 CBS New York CBS New York | 3h | |
|
|
|
 | Grand marshal named for Veteran's Day Parade |
| The CEO of the Wounded Warrior project, retired U.S. Army Lt. Gen. Mike Linnington, was named Monday... |
 CBS New York CBS New York | 3h | |
|
|
|
 | NYC braces for possible arrest of Trump, protests |
| Preparations have been made in Lower Manhattan for the possible arrest of former President Donald Trump... |
 PIX11 News PIX11 News | 3h | |
|
|
|
 | Global banking: Is history about to repeat itself? |
| After the failure of three US banks, another on life support, and the swift demise of Credit Suisse,... |
 Sky News Sky News | 3h | |
|
|
|
 | At a French munitions factory, the race is on to send shells to Ukraine • FRANCE... |
| With EU ministers reaching a deal to supply Ukraine with a million rounds of shells to bolster its defences... |
 FRANCE 24 English FRANCE 24 English | 3h | |
|
|
|
 | Fears of unrest as possible Trump arrest nears • FRANCE 24 English |
| United States law enforcement say they are preparing for potential unrest over the possible historic... |
 FRANCE 24 English FRANCE 24 English | 3h | |
|
|
|
 | Ingraham: The new world order is beginning to take shape |
| Fox News host Laura Ingraham discusses how the Biden administration's foreign policy is leading to a... |
 Fox News Fox News | 3h | |
|
|
|
 | Unfulfilled reforms spark demonstrations in Kenya |
| Kenya is rattled by protests with demonstrators accusing the government of graft and failing to implement... |
 TRT World TRT World | 3h | |
|
|
|
 | Полиция Лондона "сбилась с курса": член палаты лордов обвинила Скотленд-Ярд... |
| Докладчик независимой комиссии выступила с самыми серьёзными обвинениями в адрес лондонской полиции за... |
 euronews (на русском) euronews (на русском) | 3h | |
|
|
|
 | Новости дня | 21 марта — дневной выпуск |
| Узнавайте о самых важных событиях в Европе и за ее пределами - последние новости, срочные новости, мир,... |
 euronews (на русском) euronews (на русском) | 3h | |
|
|
|
 | Strike shuts down LA schools |
| The union representing custodians, bus drivers and cafeteria workers is vowing to picket for three days,... |
 ABC News ABC News | 3h | |
|
|
|
 | ABC went from talking about 'failing ratings' to 'pushing for more funding' |
| The ABC have gone from talking about "failing ratings" last night to "pushing for more funding and higher... |
 SkyNewsAustralia SkyNewsAustralia | 3h | |
|
|
|
 | 'So beautiful': Matt Kean receives 'lovey puff pieces' and awkward photos from media |
| "There's him in the backyard looking to the future. There's him delivering a budget being not really... |
 SkyNewsAustralia SkyNewsAustralia | 3h | |
|
|
|
 | Biden orders release of intelligence on COVID origins |
| U.S. President Joe Biden signed a bill that requires declassification of information related to the origins... |
 Reuters Reuters | 3h | |
|
|
|
 | Villanueva y Almendralejo celebrarán partidos del Europeo sub-19 |
| Las localidades pacenses de Villanueva de la Serena y Almendralejo acogerán, entre los días 22 y 28 de... |
 Europa Press Europa Press | 3h | |
|
|
|
 | 🔴 En vivo ViX: La Voz de la Mañana 7:00 A.M., 21de marzo de 2023 |
| En @VIX ésta y más noticias 24 horas Noticias 24/7 en ViX: https://bit.ly/3LBhvTK #ViX en redes... |
 Univision Noticias Univision Noticias | 3h | |
|
|
|
 | Почему Филипп Киркоров скрывает свои отношения от журналистов?#shorts #киркоров... |
| Читай нас на сайте: https://www.kp.ru/ И присоединяйся к нам в соцсетях: ➡️Rutube https://rutube.ru/u/kpru/... |
 Комсомольская Правда Комсомольская Правда | 3h | |
|
|
|
 | Boris Johnson thinks Partygate hearing is 'petty' | Andrew Gimson |
| "He thinks that this is a really petty attempt to do him down and that he's already been punished." ... |
 Times Radio Times Radio | 3h | |
|
|
|
 | The five pillars of Islam | AFP |
| Islam is based on five key practices, known as pillars; one of these is ramadan, the month of fasting.... |
| |
|
|
|
 | Trump ally Robert Costello testifies in Stormy Daniels hush money case |
| Jon Sale, the former assistant special Watergate prosecutor, describes Robert Costello, a fellow attorney... |
| |
|
|
|
 | India rejects UAE request for more air traffic rights | Latest English News | WION |
| India is not looking at increasing air traffic rights for the United Arab Emirates, said Civil Aviation... |
| |
|
|
|
 | Twenty years after US invaded Iraq, Congress wants its war powers back | Latest English... |
| Twenty years after the US and its allies invaded Iraq, the United States Congress now wants its war powers... |
| |
|
|
|
 | Xi Jinping in Russia: Putin, Xi Jinping discuss Ukraine peace proposal | Russia-Ukraine... |
| Russian President Vladimir Putin said on Monday that China's Ukraine "peace plan" could be discussed... |
| |
|
|
|
 | Ferrari hit by ransomware attack, customer details compromised | Latest English News... |
| Ferrari NV said it was hit by a ransomware attack that exposed information on the Italian sports car... |
| |
|
|
|
 | What Happened To The Car JFK Was Assassinated In? |
| While it's safe to assume everyone has heard about the tragic assassination of U.S. President John F.... |
| |
|
|
|
 | 🎙 Честное слово с Майклом Наки |
| Политолог и журналист Майкл Наки сегодня у нас в гостях. В 17:00, как всегда, начинаем «Честное слово»... |
 Штаб Навального Штаб Навального | 3h | |
|
|
|
 | msnbcleanforward's YouTube Videos: Biden issues first veto of his presidency |
| ... |
 Trump News TV from Michael_Novakhov (10 sites) Trump News TV from Michael_Novakhov (10 sites) | 3h | |
|
|
|
 | msnbcleanforward's YouTube Videos: Watch The Beat with Ari Melber Highlights: March... |
| ... |
 Trump News TV from Michael_Novakhov (10 sites) Trump News TV from Michael_Novakhov (10 sites) | 3h | |
|
|
|
 | Biden issues first veto of his presidency |
| President Joe Biden on Monday issued his first veto since taking office, rejecting a bipartisan measure... |
| |
|
|
|
 | Watch The Beat with Ari Melber Highlights: March 20 |
| Watch the top news stories and highlights from The Beat with Ari Melber, airing weeknights at 6 p.m.... |
| |
|
|
|
 | ShowBiz Minute: XXXTentacion, Paltrow, Reddick |
| (21 Mar 2023) Jury convicts 3 of murder in death of rapper XXXTentacion; Gwyneth Paltrow to stand trial... |
 Associated Press Associated Press | 3h | |
|
|
|
 | EU-ARTILLERIE FÜR UKRAINE: Die geplante Munitionslieferung nur "ein Teil des... |
| Die EU will der Ukraine in den kommenden zwölf Monaten eine Million neue Artilleriegeschosse für den... |
| |
|
|
|
 | 'Maybe That's A Good Lesson': John Roberts Swipes At Biden Admin Over Student Debt... |
| In February, Chief Justice John Roberts questioned lawyers in Biden v. Nebraska, which would determine... |
 Forbes Under 30 Forbes Under 30 | 3h | |
|
|
|
 | Trump indictment would make GOP nomination more likely | World In :60 | GZERO Media |
| Republicans believe an indictment will make it more likely that Trump gets the nomination. Subscribe... |
 GZERO Media GZERO Media | 3h | |
|
|
|
 | UnivisionNoticias's YouTube Videos: 🔴 En vivo ViX: La Voz de la Mañana 7:00 A.M.,... |
| ... |
 Puerto Rico News Videos from Michael_Novakhov (20 sites) Puerto Rico News Videos from Michael_Novakhov (20 sites) | 3h | |
|
|
|
 | Sky News Breakfast: Damning report into Britain's biggest police force |
| On Sky News Breakfast with Kay Burley: - A damning report has found "institutional racism, misogyny... |
 Sky News Sky News | 3h | |
|
|
|
 | Met Police review: A 'gift' to commissioner, but will he act on findings? |
| Baroness Louise Casey described her report as a "gift" to the leadership of the Metropolitan Police,... |
 Sky News Sky News | 3h | |
|
|
|
 | Watch live: Hostage journalist welcomed by French President Macron after almost 2... |
| Freed French hostage journalist Olivier Dubois, who was held hostage in Mali for nearly two years, is... |
 Sky News Sky News | 3h | |
|
|
|
 | Daily Podcast: Are we teetering on the edge of a banking crisis? |
| Credit Suisse, one of Switzerland's largest banks, has been swallowed up by its rival UBS for £1bn. ... |
 Sky News Sky News | 3h | |
|
|
|
 | Met Police report is 'very difficult reading', says Home Secretary Suella Braverman |
| Met Police report is 'very difficult reading', says Home Secretary Suella Braverman The Casey report... |
 Sky News Sky News | 3h | |
|
|
|
 | Absolute savagery Watch brand-new #TheWheel on #iPlayer |
| Michael McIntyre hosts a game show packed with huge stars, big laughs and a giant spinning wheel. Can... |
| |
|
|
|
 | Olivier Dubois freed: 'Captivity of Olivier a turning-point for Mali and journalism... |
| French President Emmanuel Macron is to welcome freed journalist Olivier Dubois at midday on Tuesday on... |
 FRANCE 24 English FRANCE 24 English | 3h | |
|
|
|
 | Thousands in the Philippines at risk from oil spill |
| Authorities in the Philippines warn February's oil spill southwest of the capital has exposed tens of... |
 TRT World TRT World | 3h | |
|
|
|
 | Новые акции протеста во Франции - но Макрон также не сдается… |
| Президент Франции не будет распускать парламент, проводить перестановки в правительстве или назначать... |
 euronews (на русском) euronews (на русском) | 3h | |
|
|
|
 | Новости дня | 21 марта — утренний выпуск |
| Узнавайте о самых важных событиях в Европе и за ее пределами - последние новости, срочные новости, мир,... |
 euronews (на русском) euronews (на русском) | 3h | |
|
|
|
 | California braces for another powerful storm on Tuesday | Early Morning |
| California is expected to get large amounts of snow and rainfall. Los Angeles and San Diego areas are... |
 NewsNation Now NewsNation Now | 3h | |
|
|
|
 | How did UBS acquire Credit Suisse for $3 billion during banking crisis? | Early Morning |
| Dr. Peter Morici breaks down how the current banking crisis affected this takeover by UBS. #EarlyMorning... |
 NewsNation Now NewsNation Now | 3h | |
|
|
|
 | We should 'stick to requiring' the government to fund both Yes and No campaigns |
| Sky News Political Editor Andrew Clennell says we must "stick" to requiring the government to fund both... |
 SkyNewsAustralia SkyNewsAustralia | 3h | |
|
|
|
 | 'Can't be ignored': Hunter Biden scandal gets 'worse and worse' by the day |
| The White House is hoping all of the recent "Trump headline nonsense" will "drown out" the Hunter Biden... |
 SkyNewsAustralia SkyNewsAustralia | 3h | |
|
|
|
 | Climate activists 'always updating' the ticking time bomb doom |
| The Daily Telegraph Tim Blair says climate activists are always updated "when the doom is going to happen"... |
 SkyNewsAustralia SkyNewsAustralia | 3h | |
|
|
|
 | NSW schools face 'enrolment crisis' over funding neglect |
| NSW One Nation Leader Mark Latham says "there will be an enrolment crisis" in New South Wales schools... |
 SkyNewsAustralia SkyNewsAustralia | 3h | |
|
|
|
 | 'Few' scientists would say climate change is an 'existential threat': Richard Lindzen |
| Atmospheric Physicist Richard Lindzen says "relatively few" scientists would say climate change is an... |
 SkyNewsAustralia SkyNewsAustralia | 3h | |
|
|
|
 | ABC ought to be 'waving red flags' and 'singing the Internationale' at the end of... |
| The ABC ought to be "waving red flags and singing the Internationale" at the end of their reports after... |
 SkyNewsAustralia SkyNewsAustralia | 3h | |
|
|
|
 | Bruselas da un ultimátum a España para corregir los daños en Doñana antes de acudir... |
| La Comisión Europea ha enviado un ultimátum a España para que ponga en marcha las medidas necesarias... |
 Europa Press Europa Press | 3h | |
|
|
|
 | Aena continúa la reparación de la pista del aeropuerto de Vigo |
| Aena continúa con los trabajos de reparación de la pista del aeropuerto de Peinador, después de que en... |
 Europa Press Europa Press | 3h | |
|
|
|
 | Sánchez pide a Abascal que "pida perdón" por llamar "locas" a... |
| El presidente del Gobierno, Pedro Sánchez, ha pedido al presidente de Vox, Santiago Abascal, que "pida... |
 Europa Press Europa Press | 3h | |
|
|
|
 | La Xunta sale en defensa del sector pesquero frente al "nuevo despotismo ilustrado"... |
| La conselleira do Mar, Rosa Quintana, ha asegurado que la Xunta "va a actuar" y hará "una intensa labor... |
 Europa Press Europa Press | 3h | |
|
|
|
 | Протестная романтика |
| Романтические вечера у французов теперь проходят так. В ресторане музыка, вино и устрицы, а за окном... |
 Комсомольская Правда Комсомольская Правда | 3h | |
|
|
|
 | Metropolitan Police 'broken' and have lost public faith | Baroness Casey |
| "When Sarah Everard was abducted, raped and murdered by a serving police officer, it wasn't their equivalent... |
 Times Radio Times Radio | 3h | |
|
|
|
 | Why Musk's Global Empire Is a US Government Headache |
| Billionaire Elon Musk has control of five companies that reach across the transportation, aerospace,... |
 Bloomberg TV Markets and Finance Bloomberg TV Markets and Finance | 4h | |
|
|
|
 | Credit Suisse Staff Looking for Jobs Are in the 'Hundreds': Recruiter |
| Will Tan, Managing Director at Principle Partners, says he's fielded hundreds of calls from Credit Suisse... |
 Bloomberg TV Markets and Finance Bloomberg TV Markets and Finance | 4h | |
|
|
|
 | Vanguard Plans to Complete Business Exit From China |
| Vanguard Group Inc. will shutter its remaining business in China after a retreat two years ago, abandoning... |
 Bloomberg TV Markets and Finance Bloomberg TV Markets and Finance | 4h | |
|
|
|
 | Snoop Dogg Launches "Premium Lifestyle Coffee Brand" inspired by his trip... |
| American rapper Snoop Dogg is adding yet another business venture to his growing list, this time expanding... |
| |
|
|
|
 | Visitors & locals fill up energy at the Mexican pyramid I WION Shorts |
| Thousands visited Mexico's Teotihuacan ruins on March 20 to welcome the spring equinox. Spring equinox... |
| |
|
|
|
 | ВОЙНА. ДЕНЬ 391. ВЗРЫВЫ В КРЫМСКОМ ДЖАНКОЕ/ ПРИГОЖИН МОЛИТ ШОЙГУ О ПОМОЩИ/ ПОМОЩЬ... |
| Поддержать канал и выход новых роликов: https://www.patreon.com/macknack Накануне крымский Джанкой... |
 MackNack MackNack | 4h | |
|
|
|
 | CBSNewsOnline's YouTube Videos: LIVE: Top Stories and Breaking News on March 21 |... |
| ... |
 Trump News TV from Michael_Novakhov (10 sites) Trump News TV from Michael_Novakhov (10 sites) | 4h | |
|
|
|
 | bbcnews's YouTube Videos: Russia's President Putin to listen to China's peace plan... |
| ... |
 Trump News TV from Michael_Novakhov (10 sites) Trump News TV from Michael_Novakhov (10 sites) | 4h | |
|
|
|
 | Ukrainian soldiers outside Kyiv destress with horse therapy |
| In a cosy barn on the outskirts of Kyiv, equine-assisted treatment is being offered to Ukrainian soldiers... |
 euronews (in English) euronews (in English) | 4h | |
|
|
|
 | Teachers protesting in Bolivia against education reform pepper-sprayed by police |
| Teachers protesting in Bolivia against education reform were pepper-sprayed outside the Ministry of Education... |
 euronews (in English) euronews (in English) | 4h | |
|
|
|
 | When can we blame climate change? The tricky science of attribution |
| Join this channel to get access to perks: https://www.youtube.com/channel/UCSrZ3UV4jOidv8ppoVuvW9Q/join... |
 euronews (in English) euronews (in English) | 4h | |
|
|
|
 | Latest news bulletin | March 21st – Morning |
| Catch up with the most important stories from around Europe and beyond - latest news, breaking news,... |
 euronews (in English) euronews (in English) | 4h | |
|
|
|
 | DEBATTE NACH AMOKLAUF IN HAMBURG: Braucht Deutschland schärfere Waffengesetzte? |
| Es ist eine Zahl, die doch verwundert vielleicht sogar erschreckt: Insgesamt sind fünf Millionen Waffen... |
| |
|
|
|
 | President Biden and The First Lady Host an Arts and Humanities Award Ceremony |
| The White House |
 The White House The White House | 4h | |
|
|
|
 | Press Briefing by Press Secretary Karine Jean-Pierre |
| The White House |
 The White House The White House | 4h | |
|
|
|
 | President Biden Delivers Remarks at the White House Conservation in Action Summit |
| Washington, DC |
 The White House The White House | 4h | |
|
|
|
 | Sandler and Aniston reunite in "Murder Mystery 2" |
| (21 Mar 2023) Adam Sandler and Jennifer Aniston discuss why they love working together as they release... |
 Associated Press Associated Press | 4h | |
|
|
|
 | Met Police: Sadiq Khan says Commissioner has his confidence after damning report |
| London Mayor Sadiq Khan has said he accepts "full responsibility" after a review found the Met police... |
 Sky News Sky News | 4h | |
|
|
|
 | Nathaniel Moran Grills Education Official On Redactions On Documents Given To Congress |
| At a House Judiciary Committee hearing earlier this month, Rep. Nathaniel Moran (R-TX) spoke about compliance... |
 Forbes Under 30 Forbes Under 30 | 4h | |
|
|
|
 | PART 2 Seth Harp: Drugs, death and Fort Bragg |
| Jack Murphy continues his conversation with investigative journalist Seth Harp about their shared coverage... |
 Stars and Stripes Stars and Stripes | 4h | |
|
|
|
 | Sun sticks around, temperatures push 60 in NY, NJ |
| High pressure will remain over the New York and New Jersey region for one more day before sliding offshore... |
 PIX11 News PIX11 News | 4h | |
|
|
|
 | Japan's Fumio Kishida heads to Kyiv to meet Volodymyr Zelenskyy |
| Prime Minister Fumio Kishida is on his way by train to Kyiv for talks with Ukrainian President Volodymyr... |
 Al Jazeera English Al Jazeera English | 4h | |
|
|
|
 | Sánchez acusa a VOX de aportar un "plus de brutalidad" al PP |
| El presidente del Gobierno, Pedro Sánchez, ha acusado hoy a Vox de extender el odio en el país y aportar... |
 Europa Press Europa Press | 4h | |
|
|
|
 | Sánchez afea que Vox critique por un "garbanzo negro" cuando estuvo en... |
| El presidente del Gobierno, Pedro Sánchez, ha afeado al líder de Vox, Santiago Abascal, que ponga el... |
 Europa Press Europa Press | 4h | |
|
|
|
 | Trump calls for protests ahead of 'likely' arrest |
| Former US President Donald Trump says he expects to be arrested on Tuesday. It's in connection with alleged... |
 TRT World TRT World | 4h | |
|
|
|
 | LIVE: Top Stories and Breaking News on March 21 | CBS News Mornings |
| Get ahead on the latest news by streaming the most important national and global stories on CBS News... |
 CBS News CBS News | 4h | |
|
|
|
 | We have a 'dangerous' situation with Russia and China: Newt Gingrich |
| Fox News contributor Newt Gingrich discusses the strengthening alliance between China and Russia and... |
 Fox News Fox News | 4h | |
|
|
|
 | 'Life and death' ambulance issues only move votes if union 'scandalise' them |
| Sky News host Paul Murray says issues with NSW Ambulance are a matter of "life and death" but are not... |
 SkyNewsAustralia SkyNewsAustralia | 4h | |
|
|
|
 | Global emissions: China can do 'whatever it wants' until 2030 before treated as Australia |
| Sky News host Paul Murray says international bodies have been "compromised" by China and its sheer lobbying... |
 SkyNewsAustralia SkyNewsAustralia | 4h | |
|
|
|
 | Donald Trump's indictment seen as a 'political prosecution' |
| Filmmaker Ami Horowitz discusses Manhattan District Attorney Alvin Bragg's investigation on former president... |
 SkyNewsAustralia SkyNewsAustralia | 4h | |
|
|
|
 | Report finds London police racist, misogynist and homophobic, recommends 'complete... |
| The London police forces, Britain's largest, is institutionally racist, misogynist and homophobic and... |
 FRANCE 24 English FRANCE 24 English | 4h | |
|
|
|
 | From Paris to the countryside: Urban exodus, three years after lockdown • FRANCE... |
| In March 2020, Paris emptied as the first Covid-19 lockdown was announced. City dwellers fled and sought... |
 FRANCE 24 English FRANCE 24 English | 4h | |
|
|
|
 | 'Racist, sexist and homophobic': Damning report slams London's Metropolitan Police... |
| IN THE PRESS – Tuesday, March 21: We look at press reaction to the French government narrowly surviving... |
 FRANCE 24 English FRANCE 24 English | 4h | |
|
|
|
 | Paris pension reform strike: Garbage, rats and fake news go viral • FRANCE 24 English |
| Images of Paris drowning in rubbish and rat infestations are making headlines around the world. But not... |
 FRANCE 24 English FRANCE 24 English | 4h | |
|
|
|
 | El Ibex 35 sube el 1,42 %tras la apertura y supera los 8.900 puntos por el auge de... |
| Madrid, 21 mar (EFE).- (Imágenes, edición y locución: Ama Bornay) El Ibex 35 sube el 1,42 % tras la apertura... |
 AGENCIA EFE AGENCIA EFE | 4h | |
|
|
|
 | Seúl realiza maniobras navales para honrar a sus caídos ante Corea del Norte |
| Mar Amarillo.- 21 mar (EFE).- La Marina surcoreana inició hoy unas grandes maniobras para honrar a sus... |
 AGENCIA EFE AGENCIA EFE | 4h | |
|
|
|
 | Tories support may continue only if they avoid Johnson: Experts | Latest English... |
| The Conservative Party would be finished if Boris Johnson staged a comeback, a leading elections expert... |
| |
|
|
|
 | India's defence exports cross $1.5 billion as it remains world's top arm and weapon... |
| The defence export in the country as per latest data has crossed Rs 13000 crores or $1.5 billion. The... |
| |
|
|
|
 | Former UK PM Johnson submits 50-page dossier laying out his defence | Latest World... |
| The privilege committee is investigating the former UK Prime Minister Boris Johnson partygate denial.... |
| |
|
|
|
 | Pensions: demonstrators carry out free toll operation in Moselle | AFP |
| Demonstrators against the pension reform carry out a free toll operation at the Saint-Avold toll in Moselle,... |
| |
|
|
|
 | LIVE: NBC News NOW - March 21 |
| NBC News NOW is live, reporting breaking news and developing stories in real time. We are on the scene,... |
 NBC News NBC News | 4h | |
|
|
|
 | XI ZU BESUCH BEI PUTIN: Beginn der offiziellen Gespräche – Thema Ukraine wird zum... |
| Mitten in seinem Krieg gegen die Ukraine hat Russlands Präsident Wladimir Putin Chinas Staats- und Parteichef... |
| |
|
|
|
 | AP Top Stories March 21 a.m. |
| (21 Mar 2023) Here's the latest for Tuesday March 21st: New York police prepare for possible Trump charges;... |
 Associated Press Associated Press | 4h | |
|
|
|
 | Driver in Brooklyn crash that killed 2 arrested: NYPD |
| One of the drivers involved in a horrific Bensonhurst car crash that left two people dead and several... |
 PIX11 News PIX11 News | 4h | |
|
|
|
 | First Alert Weather: Beautiful start to spring |
| CBS2's Elise Finch has the latest weather forecast. |
 CBS New York CBS New York | 4h | |
|
|
|
 | NYPD bracing for possible Trump protests |
| The former president claims he could be arrested Tuesday and called on his supporters to protest. CBS2's... |
 CBS New York CBS New York | 4h | |
|
|
|
 | Witness challenges Michael Cohen in Trump investigation |
| Cohen is the star witness in the Manhattan district attorney's case against the former president, who... |
 CBS New York CBS New York | 4h | |
|
|
|
 | US: Blaze engulfs church complex in New Jersey |
| A huge blaze has engulfed a church complex in the US state of New Jersey. Numerous fire crews attend... |
 Sky News Sky News | 4h | |
|
|
|
 | Blaze engulfs church complex in New Jersey |
| A huge blaze has engulfed a church complex in New Jersey. Numerous fire crews attend a raging inferno... |
 Sky News Sky News | 4h | |
|
|
|
 | Baroness Casey: 'Standards for police officers to hold are above the rest of us' |
| The damning report into details of racism and homophobia within the Met Police came from Baroness Louise... |
 Sky News Sky News | 4h | |
|
|
|
 | Met Police: 'It's a wake-up call to us all' - Labour on Casey review |
| Shadow Policing Minister Sarah Jones has paid tribute to the Casey review into the Met Police, saying... |
 Sky News Sky News | 4h | |
|
|
|
 | France protests: Violence in Paris and Lyon as government survives confidence vote |
| Violence has continued in several cities across France, as part of a wave of demonstrations over the... |
 Sky News Sky News | 4h | |
|
|
|
 | Pediatricians Caught in a Political Crossfire |
| After Roe v. Wade legalized abortion 50 years ago, abortion clinics and providers saw waves of violence,... |
| |
|
|
|
 | Estados Unidos vigilará a China "muy de cerca" ante la visita de Xi Jinping... |
| La Casa Blanca ha asegurado que China será vigilada "muy de cera" por Estados Unidos y otros países vecinos,... |
 Europa Press Europa Press | 4h | |
|
|
|
 | Wait, what? 😵💫 #BBCGhosts #iPlayer |
| A cash-strapped young couple inherit a rickety country mansion, only to find it teeming with needy ghosts.... |
| |
|
|
|
 | Russia's President Putin to listen to China's peace plan to end war in Ukraine -... |
| Xi Jinping and Vladimir Putin have entered a second day of talks as part of the Chinese president's state... |
 BBC News BBC News | 4h | |
|
|
|
 | МВФ спасает Шри-Ланку и выделяет ей $3 млрд |
| Из-за пандемии доходы страны от туризма и экспорта резко сократились. Шри-Ланка столкнулась с серьезным... |
 euronews (на русском) euronews (на русском) | 4h | |
|
|
|
 | Chris Minns' main opponent is Albanese's 'broken promises' |
| Sky News host Chris Kenny says if Labor wins the NSW election there will be Labor governments "coast... |
 SkyNewsAustralia SkyNewsAustralia | 4h | |
|
|
|
 | Labor's 'broken political promises' shows they 'fail to deliver' on their commitments |
| Sky News host Chris Kenny says Labor's "broken political promises" show they "fail to deliver" on their... |
 SkyNewsAustralia SkyNewsAustralia | 4h | |
|
|
|
 | Voters not keen on Kean: Important for policies to cater to everyone and not one... |
| Sky News Political Editor Andrew Clennell says it's important for policies to cater to everyone and not... |
 SkyNewsAustralia SkyNewsAustralia | 4h | |
|
|
|
 | Ron DeSantis slams Trump's prediction of his arrest as a 'manufactured circus' |
| Media Writer for The Australian Sophie Elsworth says it was a "smart move" for Florida Governor Ron DeSantis... |
 SkyNewsAustralia SkyNewsAustralia | 4h | |
|
|
|
 | Michael Cohen's former legal adviser throws doubt on his credibility |
| Attorney Robert Costello joins 'Tucker Carlson Tonight' after appearing before Trump grand jury in New... |
 Fox News Fox News | 4h | |
|
|
|
 | Holocaust survivor recalls cart of bodies 80 years on |
| Eighty-four-year-old Rina Revah was nearly four when she was sent to a concentration camp in northern... |
 Reuters Reuters | 5h | |
|
|
|
 | Massive fire destroys New Jersey church I WION Shorts |
| A major fire burned a large church in Burlington, New Jersey to the ground on March 20. More than 100... |
| |
|
|
|
 | Macron Government Survives Two No-Confidence Votes |
| The French government dodged two no-confidence motions late Monday enabling President Emmanuel Macron's... |
 Bloomberg TV Markets and Finance Bloomberg TV Markets and Finance | 5h | |
|
|
|
 | ❗️ НОВОСТИ | АТАКА БЕСПИЛОТНИКОВ В КРЫМУ | МИЛЛИОН СНАРЯДОВ УКРАИНЕ |
| 391 день войны. Ночью Крым атаковали беспилотники, в городе Джанкой ранен человек. Евросоюз поставит... |
 Штаб Навального Штаб Навального | 5h | |
|
|
|
 | ABC News's YouTube Videos: Iraq 20 years later: 3 vets reflect on the war they fought... |
| ... |
 Trump News TV from Michael_Novakhov (10 sites) Trump News TV from Michael_Novakhov (10 sites) | 5h | |
|
|
|
 | TRUMP WIRD FESTGENOMMEN? New York rüstet sich für Randale – Anhänger bereit für heftige... |
| Die US-Millionenmetropole New York bereitet sich für den Fall einer Anklage des früheren US-Präsidenten... |
| |
|
|
|
 | EU greenlights €2 billion Ukraine ammunition but doubts remain over ability to deliver... |
| Ukraine roughly needs 1 million ammunition rounds, primarily the 155 mm kind, over the next year. .. |
 euronews (in English) euronews (in English) | 5h | |
|
|
|
 | IMF approves a €3 billion bailout plan for bankrupt Sri Lanka |
| The International Monetary Fund said Tuesday it is assessing Sri Lanka's governance in the first case... |
 euronews (in English) euronews (in English) | 5h | |
|
|
|
 | Reeves, Fishburne mourn Reddick |
| (21 Mar 2023) At the Los Angeles premiere of "John Wick: Chapter 4," stars including Keanu Reeves and... |
 Associated Press Associated Press | 5h | |
|
|
|
 | President Xi meets Russian PM ahead of talks with Putin | AFP |
| Images show Chinese president Xi Jinping meeting Russian Prime Minister Mikhail Mishustin on the second,... |
| |
|
|
|
 | UnivisionNoticias's YouTube Videos: El temerario intento de un sospechoso de huir... |
| ... |
 Puerto Rico News Videos from Michael_Novakhov (20 sites) Puerto Rico News Videos from Michael_Novakhov (20 sites) | 5h | |
|
|
|
 | Casey report: Mark Rowley refuses to describe Met Police as 'institutionally' racist |
| The head of the Metropolitan Police has accepted that there is racism, misogyny and homophobia in the... |
 The Independent The Independent | 5h | |
|
|
|
 | David Attenborough plants tree in honour of Queen Elizabeth |
| Sir David Attenborough has planted an oak tree in honour of Her late Majesty, Queen Elizabeth II. .. |
 The Independent The Independent | 5h | |
|
|
|
 | Parapléjicos amplía los conocimientos en rehabilitación a profesionales |
| Aplicaciones de realidad virtual, exoesqueletos robotizados o nuevas técnicas de estimulación craneal... |
 Europa Press Europa Press | 5h | |
|
|
|
 | La enfermedad cardiovascular, principal causa de mortalidad para las mujeres |
| Enfermedad cardiovascular y ser mujer. Una de cada tres muere cada año por esta patología, ocurriendo... |
 Europa Press Europa Press | 5h | |
|
|
|
 | Tamames no aplaude el discurso con el que Abascal ha abierto el debate en el Congreso |
| El economista Ramón Tamames, candidato de la moción de censura promovida por Vox, no ha aplaudido el... |
 Europa Press Europa Press | 5h | |
|
|
|
 | Abascal da por caducado a Sánchez y carga contra Feijóo |
| El líder de Vox, Santiago Abascal, ha dado este martes por "caducado" al presidente del Gobierno, Pedro... |
 Europa Press Europa Press | 5h | |
|
|
|
 | IPCC report: Here's how we can defuse the 'ticking time bomb' of climate change |
| The report confirms that humans are responsible for virtually all global heating in the last 200 years.... |
 euronews (in English) euronews (in English) | 5h | |
|
|
|
 | "No Proof Of China Arming Russia", Polish PM Likens Putin To Hitler, "Wagner... |
| A mysterious explosion in Crimea damaged a Russian cargo train carrying Kalibr missiles in Crimea on... |
| |
|
|
|
 | Climate change isn't 'particularly dangerous': Richard Lindzen |
| Atmospheric Physicist Richard Lindzen says climate change isn't "particularly dangerous" as climate alarmism... |
 SkyNewsAustralia SkyNewsAustralia | 5h | |
|
|
|
 | 'What are you talking about, Joe?': Biden says he's a 'student' of Persian culture |
| US President Joe Biden has revealed he's apparently a "keen student of Persian culture", says Sky News... |
 SkyNewsAustralia SkyNewsAustralia | 5h | |
|
|
|
 | Biden family 'facing a little scrutiny' as media 'finally' asks questions |
| The Biden family is finally "facing a little scrutiny" for its shady business dealings, says Sky News... |
 SkyNewsAustralia SkyNewsAustralia | 5h | |
|
|
|
 | 'Still at stalemate': 'Tense' negotiations behind the scenes ahead of King's coronation |
| Prince Harry and Meghan Markle have not decided whether they'll attend King Charles' coronation as "tense... |
 SkyNewsAustralia SkyNewsAustralia | 5h | |
|
|
|
 | Afghanistan war crimes investigator tapped to lead federal corruption watchdog |
| The judge who led the investigation into the alleged war crimes of Australian soldiers in Afghanistan... |
 SkyNewsAustralia SkyNewsAustralia | 5h | |
|
|
|
 | Bret Baier and Martha MacCallum discuss possible Trump indictment | Guy Benson Show |
| Bret Baier and Martha MacCallum discuss possible Trump indictment | Guy Benson Show Subscribe to... |
 Fox News Fox News | 5h | |
|
|
|
 | Depurar agua con lodos de potabilizadora reduce presencia de fósforo un 80 % |
| Valencia, 21 mar (EFE). (Imágenes: Ángel Herrera).- Reducir la presencia de nutrientes en las aguas residuales... |
 AGENCIA EFE AGENCIA EFE | 5h | |
|
|
|
 | АМЕРИКА |
| Ежедневная информационная программа в прямом эфире из студии в Вашингтоне. |
 Настоящее Время Настоящее Время | 5h | |
|
|
|
 | ВЕЧЕР |
| Самые интересные и важные события дня. |
 Настоящее Время Настоящее Время | 5h | |
|
|
|
 | Переговоры Путина и Си. Встреча Зеленского и Кисиды. Взрывы в Джанкое. Обыск в & |
| ◾️В Кремле проходит официальная часть перегоров Владимира Путина с китайским лидером Си Цзиньпинем. Обсуждают,... |
 Настоящее Время Настоящее Время | 5h | |
|
|
|
 | Переговоры Зеленского с премьером Японии, Путина – с лидером Китая | НОВОСТИ |
| О неожиданном визите Фумио Кисиды в Украину стало известно утром. Днем ранее премьер-министр Японии посещал... |
 Настоящее Время Настоящее Время | 5h | |
|
|
|
 | Дерипаска подал в суд на меня | Мария Певчих |
| Олигарх Дерипаска подал в суд на главу отдела расследований ФБК Марию Певчих. Миллиардер подал иск о... |
 Штаб Навального Штаб Навального | 5h | |
|
|
|
 | BACHMUT BRENNPUNKT NR. 1 - Wagner-Chef Prigoschin: „Die Flanken sind gefährdet" |... |
| BACHMUT BRENNPUNKT NR. 1 - Wagner-Chef Prigoschin in Sorge: „Die Flanken sind gefährdet" Wagner-Chef... |
| |
|
|
|
 | El temerario intento de un sospechoso de huir en patineta que terminó con su arresto |
| La policía de Los Ángeles difundió imágenes de cámaras corporales y de patrullas que muestran a un sospechoso... |
 Univision Noticias Univision Noticias | 5h | |
|
|
|
 | Massive fire destroys South New Jersey church |
| (21 Mar 2023) Firefighters battled a massive blaze at a church in Burlington County, New Jersey on Monday... |
 Associated Press Associated Press | 5h | |
|
|
|
 | Paris: tensions between police and youth in late night clashes | AFP |
| Images of late night clashes in Paris, where many people including large groups of youth and young adults... |
| |
|
|
|
 | The Upside of Stress: A Slight Change of Plans with Dr. Maya Shankar | How To! Podcast |
| This week we present a special episode from A Slight Change of Plans hosted by Dr. Maya Shankar, a cognitive... |
 Slate Video Slate Video | 5h | |
|
|
|
 | UBS Credit Outlook Cut to Negative on Credit Suisse Deal |
| UBS Group AG's credit outlook was cut to negative from stable by S&P Global Ratings and Moody's Investors... |
 Bloomberg TV Markets and Finance Bloomberg TV Markets and Finance | 5h | |
|
|
|
 | Атака дронов на Джанкой. Авдеевка – "второй Бахмут" |
| Джанкой в аннексированном Крыму атаковали дроны. На фоне ожесточённых окопных боёв в Донбассе ЕС и США... |
 euronews (на русском) euronews (на русском) | 5h | |
|
|
|
 | Трамп ждёт уголовных обвинений и призывает к протестам |
| Завершается рассмотрение дела о выплате 130 тыс долларов порноактрисе за молчание из фонда предвыборной... |
 euronews (на русском) euronews (на русском) | 5h | |
|
|
|
 | PP dice que la moción la puede hacer la mayoría de los españoles |
| La portavoz del PP en el Congreso de los Diputados, Cuca Gamarra, ha afirmado este martes previamente... |
 Europa Press Europa Press | 5h | |
|
|
|
 | Cs acusa a Vox de fomentar el desapego a las instituciones con la moción |
| El portavoz de Ciudadanos en el Congreso de los Diputados, Edmundo Bal, ha manifestado sentir "tristeza"... |
 Europa Press Europa Press | 5h | |
|
|
|
 | PSOE destaca la seriedad de la moción de censura |
| El portavoz del PSOE en el Congreso de los Diputados, Patxi López, ha destacado la seriedad institucional... |
 Europa Press Europa Press | 5h | |
|
|
|
 | Tamames confirma cambios en el discurso de la moción |
| El candidato de Vox a la presidencia del Gobierno en la moción de censura presentada por Vox, Ramón Tamames,... |
 Europa Press Europa Press | 5h | |
|
|
|
 | La Policía desarticula una organización que estafó 300.000 euros al Ayuntamiento... |
| La Policía Nacional ha desarticulado una organización criminal que estaría detrás de la estafa de 'phishing'... |
 Europa Press Europa Press | 5h | |
|
|
|
 | ERC no se toma a "broma" la moción y espera que sea un debate "rico... |
| El portavoz de ERC, Gabriel Rufián, espera que no sea un autohomenaje de Tamames y sea un debate "rico... |
 Europa Press Europa Press | 5h | |
|
|
|
 | PDeCAT afirma que la moción de censura es "prescindible" y degrada las... |
| El portavoz de PDeCAT, Ferran Bel, ha señalado a las puertas del Congreso que se debate una moción de... |
 Europa Press Europa Press | 5h | |
|
|
|
 | Bal (Cs) califica la moción de censura de "circo" y "poco seria" |
| El portavoz adjunto de Cs en el Congreso, Edmundo Bal, ha señalado que la moción de censura de Ramón... |
 Europa Press Europa Press | 5h | |
|
|
|
 | Baldoví (Compromís) se toma la moción con "seriedad" |
| El portavoz de Compromís, Joan Baldoví, ha dicho que algunos quieren utilizar el Congreso para conseguir... |
 Europa Press Europa Press | 5h | |
|
|
|
 | Aragonés se presenta ante la misión europea que investiga Pegasus criticando al Gobierno |
| El presidente de la Generalitat de Cataluña, Pere Aragonés, ha acudido este martes a la Oficina del Parlamento... |
 Europa Press Europa Press | 5h | |
|
|
|
 | UK Metropolitan Police institutionally racist, sexist and homophobic, new report... |
| Baroness Casey's review found that the department hasn't treated violence against women and girls as... |
 euronews (in English) euronews (in English) | 5h | |
|
|
|
 | French pension reform: outrage in Paris post no-confidence votes |
| Protesters are trying to pressure lawmakers to bring down the government and doom the unpopular retirement... |
 euronews (in English) euronews (in English) | 5h | |
|
|
|
 | Donald Trump has urged his supporters to rally ahead of possible indictment |
| The NYC police department bumps up security measures as Donald Trump has urged his supporters to rally... |
 euronews (in English) euronews (in English) | 5h | |
|
|
|
 | A juicio por el asesinato y agresión sexual a un niño en Lardero |
| Logroño, 21 mar (EFE), (Imagen: Fernando Díaz).- La Audiencia Provincial de Logroño acoge desde este... |
 AGENCIA EFE AGENCIA EFE | 5h | |
|
|
|
 | Силовики «погостили» у Саши Митрошиной |
| 120 миллионов рублей налогов не заплатила блогер Саша Митрошина. Силовики возбудили уголовное дело и... |
 Комсомольская Правда Комсомольская Правда | 5h | |
|
|
|
 | Time is the 'key element': Mark Latham on weight loss prior to election campaign |
| One Nation NSW Leader Mark Latham says time is the "key element" to weight loss, speaking about his change... |
 SkyNewsAustralia SkyNewsAustralia | 5h | |
|
|
|
 | Perrottet admits to calling NSW Health Minister when his wife needed an ambulance |
| NSW Premier Dominic Perrottet has admitted to calling Brad Hazzard when his wife needed an ambulance... |
 SkyNewsAustralia SkyNewsAustralia | 5h | |
|
|
|
 | MPs using burner phones to connect with youth voters 'should know better' |
| Sky News host Paul Murray says while MPs "should know better", they are using burner phones to reach... |
 SkyNewsAustralia SkyNewsAustralia | 5h | |
|
|
|
 | Labor MP speaks out against AUKUS project over nuclear waste concerns |
| Fremantle MP Josh Wilson has become the first government MP to speak out publicly against Albanese's... |
 SkyNewsAustralia SkyNewsAustralia | 5h | |
|
|
|
 | Labor must 'depoliticise' the Voice if they want 'bipartisan support' |
| Institute of Public Affairs John Roskam says the Labor government needs to "depoliticise" the Voice to... |
 SkyNewsAustralia SkyNewsAustralia | 5h | |
|
|
|
 | Australia needs to 'remember' it 'keeps the lights on in Tokyo' |
| The Australian government needs to "remember" it "keeps the lights on in Tokyo", says Financial Review... |
 SkyNewsAustralia SkyNewsAustralia | 5h | |
|
|
|
 | Indictment might make Trump a 'martyr' after key witness discredited |
| Freshwater Strategy Director Leo Shanahan says if Trump is arrested it "makes him a martyr of the cause"... |
 SkyNewsAustralia SkyNewsAustralia | 5h | |
|
|
|
 | Comienza una primavera que se prevé cálida |
| Madrid, 21 mar (EFE).- La primavera, que comenzó ayer a las 22:24 hora oficial peninsular, se prevé cálida,... |
 AGENCIA EFE AGENCIA EFE | 5h | |
|
|
|
 | West 'shuns' Putin into relying on China |
| "Russia has been shunned by the West. So it's turning east and it's turning to its dependency on China."... |
 Times Radio Times Radio | 6h | |
|
|
|
 | Russia delivers enriched Uranium to France | Latest World News | English News | Top... |
| On Monday, Russia delivered enriched uranium to France. A cargo ship unloaded cylinders of uranium from... |
| |
|
|
|
 | Cargo ship unloads cylinders of Uranium at the French port of Dunkirk | Latest World... |
| On Monday, Russia delivered enriched uranium to France. A cargo ship unloaded cylinders of uranium from... |
| |
|
|
|
 | Russia delivers enriched Uranium to France | Nuclear fuel shipments bankrolling Ukraine... |
| On Monday, Russia delivered enriched uranium to France. A cargo ship unloaded cylinders of uranium from... |
| |
|
|
|
 | Russia's most lethal weapons in Ukraine: Tanks to hypersonic missiles | Russia-Ukraine... |
| Russia-Ukraine war live: Have a look at the new generations of weapons in which Russia says it is investing... |
| |
|
|
|
 | Lightship L1 Electric RV - This Holiday Home Can Propel Itself | WION Pitstop |
| Amid a sea of electric car and two-wheeler manufacturers, a team of former Tesla engineers has been silently... |
| |
|
|
|
 | Iraq war 20 years on: Iraqis say disbanding army was a mistake |
| Two decades on, Iraqis are still criticising how the United States invaded their country without a plan.... |
 Al Jazeera English Al Jazeera English | 6h | |
|
|
|
 | DR Congo: Cholera spreads among displaced people |
| More than 800,000 people have been forced from their homes in eastern Democratic Republic of the Congo... |
 Al Jazeera English Al Jazeera English | 6h | |
|
|
|
 | Potential Trump indictment today, cities prepare for possible protests & more | LiveNOW... |
| Subscribe to LiveNOW from FOX! https://www.youtube.com/livenowfox?sub_confirmation=1 Where to watch... |
 FOX 10 Phoenix FOX 10 Phoenix | 6h | |
|
|
|
 | STEPHAN WEIL: Kritik an Habecks Heizungsverbot – Frist sei zu kurz gesetzt | WELT... |
| Niedersachsens Ministerpräsident Stephan Weil (SPD) kritisiert im Interview mit WELT die Pläne von Bundeswirtschaftsminister... |
| |
|
|
|
 | Iraq 20 years later: 3 vets reflect on the war they fought | Nightline |
| Twenty years after they were first deployed to Iraq, three Marines speak candidly about their experiences... |
 ABC News ABC News | 6h | |
|
|
|
 | Strike expected to close schools in Los Angeles |
| (21 Mar 2023) Tens of thousands of workers in the Los Angeles Unified School District planned to walk... |
 Associated Press Associated Press | 6h | |
|
|
|
 | John Wick returns: 'Sell the character, sell the pain' |
| (21 Mar 2023) Actor Keanu Reeves and director Chad Stahelski discuss the thinking behind the ambitious... |
 Associated Press Associated Press | 6h | |
|
|
|
 | Atlanta's Battle Over "Cop City" | What Next | Daily News and Analysis... |
| The Atlanta Police Foundation's $90 million police training facility, a mock-urban space with a nightclub,... |
 Slate Video Slate Video | 6h | |
|
|
|
 | Casey report: Met Police institutionally racist, misogynist, and homophobic |
| A damning review has found that the Metropolitan Police failed to protect the public from police officers... |
 The Independent The Independent | 6h | |
|
|
|
 | Доброволец обнял дочку после долгой разлуки |
| Житель города Радужный прямо с поезда побежал в детский сад, чтобы обнять дочь, которую не видел с сентября... |
 Комсомольская Правда Комсомольская Правда | 6h | |
|
|
|
 | 'How Do You Deal With That?': Sonia Sotomayor Questions Lawyer In Student Debt Cancellation... |
| In February, Justice Sonia Sotomayor questioned lawyers in Biden v. Nebraska, which would determine whether... |
 Forbes Under 30 Forbes Under 30 | 6h | |
|
|
|
 | Brazil court to rule on producing cannabis locally |
| A Brazilian appeals court has agreed to rule on whether the cannabis industry can plant in the country,... |
 Reuters Reuters | 6h | |
|
|
|
 | LIVE: Josep Borrell gives speech on EU defense and security policy |
| EU foreign policy chief Josep Borrell gives a speech at the inaugural Schuman Security and Defence Forum... |
 Reuters Reuters | 6h | |
|
|
|
 | 🔴📡 Lionel Scaloni, ofrece una conferencia de prensa en vísperas del amistoso ante... |
| El seleccionador argentino, Lionel Scaloni, ofrece una conferencia de prensa en vísperas del amistoso... |
 AGENCIA EFE AGENCIA EFE | 6h | |
|
|
|
 | 'Beijing is trying to suggest that China may be a new type of peacemaker in the world'... |
| According to Rana Mitter, Professor of history of modern China at Oxford University, Beijing is trying... |
 FRANCE 24 English FRANCE 24 English | 6h | |
|
|
|
 | World's biggest bank finds rock bags instead of nickels |
| London Metal exchange has cancelled all nickel trading for another week after the world's biggest bank... |
 SkyNewsAustralia SkyNewsAustralia | 6h | |
|
|
|
 | National apology for forced adoptions one of the 'finest moments' in parliamentary... |
| Prime Minister Anthony Albanese says the national apology for forced adoptions was one of the "finest... |
 SkyNewsAustralia SkyNewsAustralia | 6h | |
|
|
|
 | Protests as French govt survives no-confidence vote | AJ #shorts |
| "We don't see a future." There have been protests in cities across France after President Emmanuel Macron's... |
 Al Jazeera English Al Jazeera English | 6h | |
|
|
|
 | Booknotes+ Podcast: Nathan Masters, "Crooked" |
| 100 years ago, these names were in American newspapers on many days: Harry Daugherty, Jess Smith, Roxie... |
| |
|
|
|
 | Китаю невыгодна смена режима в России | Андрей Смоляков |
| Председатель КНР Си Цзиньпин прилетел в Москву по приглашению Путина, а Китай потребовал от суда в Гааге,... |
 Штаб Навального Штаб Навального | 6h | |
|
|
|
 | Путин приехал в Мариуполь |
| Кремль утверждает, что Путин впервые приехал в оккупированный Донбасс. Утром 19 марта государственное... |
 Штаб Навального Штаб Навального | 6h | |
|
|
|
 | „Spagat zwischen Westen und Russland": Was hat Xi Jinping für Wladimir Putin im Gepäck? |
| Ukraine-Krieg, multipolare Weltordnung und Rohstoffe mit Kriegsrabatt - so könnte die Agenda an Tag zwei... |
| |
|
|
|
 | Latest weapons in use by the Ukrainian military against Russian invasion | Russia-Ukraine... |
| Ukrainian Military Arsenal Live: Have a look at military vehicles and equipment used by the Ukrainian... |
| |
|
|
|
 | Will Donald Trump be arrested? New York cops tighten security ahead of possible historic... |
| New York police have tightened security ahead of a possible historic indictment of Donald Trump over... |
| |
|
|
|
 | New Yorkers call out Alvin Bragg's Trump probe |
| Fox News correspondent Sara Carter has the latest on the possible indictment of the former president... |
 Fox News Fox News | 6h | |
|
|
|
 | Outside the Kremlin on day two of Xi Jinping's visit to Russia to meet Vladimir Putin |
| Shots of the Kremlin as Chinese President Xi Jinping visits Russia. Xi Jinping has carried out a series... |
 Sky News Sky News | 6h | |
|
|
|
 | Pimco, Invesco Face Biggest Losses on Risky CS Bonds |
| Pimco and Invesco are among the largest holders of Credit Suisse's so-called Additional Tier 1 bonds... |
 Bloomberg TV Markets and Finance Bloomberg TV Markets and Finance | 6h | |
|
|
|
 | "Победа со вкусом поражения": протестное движение во Франции не ослабевает |
| Левые партии будут и дальше добиваться отмены пенсионной реформы. В четверг запланированы крупная забастовка... |
 euronews (на русском) euronews (на русском) | 6h | |
|
|
|
 | Energy trade dispute: Mexican president promises energy independence |
| US climate envoy John Kerry is visiting Mexico to look at ways the region can speed up the transition... |
 Al Jazeera English Al Jazeera English | 6h | |
|
|
|
 | 'Hilarious': New York Times article tries to make Judaism 'politically correct' |
| A New York Times article has hilariously attempted to retrofit Judaism and the Bible to make it "politically... |
 SkyNewsAustralia SkyNewsAustralia | 6h | |
|
|
|
 | 'Too soft': Meghan and Harry's 'entitled' behaviour is 'nothing new' |
| King Charles has been "too soft" on Prince Harry and Meghan Markle, with their entitled and horrible... |
 SkyNewsAustralia SkyNewsAustralia | 6h | |
|
|
|
 | 'War' erupts in Victorian Liberal Party over Moira Deeming expulsion |
| A war has erupted in the Victorian Liberal Party over the expulsion of Moira Deeming after she helped... |
 SkyNewsAustralia SkyNewsAustralia | 6h | |
|
|
|
 | 'Blackmailing' from independents accompanies Labor's $10 billion housing package |
| Financial Review Senior Correspondent Aaron Patrick says there is "posturing" and "blackmailing" from... |
 SkyNewsAustralia SkyNewsAustralia | 6h | |
|
|
|
 | Donald Trump can still be elected president if he's indicted |
| Freshwater Strategy Director Leo Shanahan says it's clear former president Donald Trump is likely to... |
 SkyNewsAustralia SkyNewsAustralia | 6h | |
|
|
|
 | Losing the Trump charge case could make Biden administration look 'terrible' |
| Financial Review Senior Correspondent Aaron Patrick says if the Biden administration goes after Trump... |
 SkyNewsAustralia SkyNewsAustralia | 6h | |
|
|
|
 | NSW Premier backs 'long-term economic plan' ahead of NSW election |
| NSW Premier Dominic Perrottet has backed the Liberals and Nationals' long-term economic plan to continue... |
 SkyNewsAustralia SkyNewsAustralia | 6h | |
|
|
|
 | Chinese nationals flooding the US border 'isn't making headlines like it should be' |
| The major amount of Chinese migrants caught at the southern border in the US "isn't making headlines... |
 SkyNewsAustralia SkyNewsAustralia | 6h | |
|
|
|
 | 👊 Бойко о главном | Китай продлит княжение Путина | Гестапо в барах Москвы | Россия... |
| Сергей Бойко, депутат горсовета Новосибирска, комментирует главные новости из регионов России — председатель... |
 Штаб Навального Штаб Навального | 7h | |
|
|
|
 | KOMMUNEN AN DEN KAPAZITÄTSGRENZEN: Mehr Hilfe bei Unterbringung von Flüchtlingen... |
| KOMMUNEN AN DEN KAPAZITÄTSGRENZEN: Mehr Hilfe bei Unterbringung von Flüchtlingen gefordert Alle... |
| |
|
|
|
 | Macron to give television interview as anger simmers over pension reform • RFI English |
| French President Emmanuel Macron will give a televised interview on Wednesday, his office announced,... |
 FRANCE 24 English FRANCE 24 English | 7h | |
|
|
|
 | Met Police: Still 'toxic individuals' in the force, says Commissioner |
| Met Police Commissioner Sir Mark Rowley says he accepts the findings of the Casey Review, but won't use... |
 Sky News Sky News | 7h | |
|
|
|
 | Analysts: US Shifting Sahel Conflict Strategy to One of Containment |
| US Special Operations Africa chief hints at a greater focus on Ghana for security efforts Originally... |
 VOA News VOA News | 7h | |
|
|
|
 | Ghana Border Towns Say Weapons Leaking from Burkina Faso |
| Burkina Faso's struggle against Islamist militants has raised security concerns in neighboring Ghana.... |
 VOA News VOA News | 7h | |
|
|
|
 | Former US President Donald Trump Tells Supporters He'll Be Arrested |
| Manhattan district attorney could indict Trump over 2016 Stormy Daniels payment Originally published... |
 VOA News VOA News | 7h | |
|
|
|
 | Debate de la moción de censura en el Congreso de los Diputados |
| Debate de la moción de censura en el pleno del Congreso de los Diputados en el que Santiago Abascal y... |
 Europa Press Europa Press | 7h | |
|
|
|
 | ГААГСКИЕ ТЁРКИ |
| Артур Смольянинов вписался за двойника Владимира Путина. В новом выпуске Гражданина Поэта Дмитрий Быков... |
 GrazhdaninPoet GrazhdaninPoet | 7h | |
|
|
|
 | 'Anything could happen' if neither Liberal nor Labor has a majority in NSW election |
| "Anything could happen" if neither the Liberal nor Labor Party manages to get a majority in the upcoming... |
 SkyNewsAustralia SkyNewsAustralia | 7h | |
|
|
|
 | Perrottet run for NSW Premier 'might be drying up' |
| Freshwater Strategy Director says Dominic Perrottet's run for New South Wales Premier "might be drying... |
 SkyNewsAustralia SkyNewsAustralia | 7h | |
|
|
|
 | Perrottet promises $250 off 'every energy bill' for households |
| New South Wales Premier Dominic Perrottet says the Liberal party's energy policy will include $250 off... |
 SkyNewsAustralia SkyNewsAustralia | 7h | |
|
|
|
 | 'No popular hunger' for Nikki Haley: She represents a 'throwback' to the pre-Trump... |
| Republican presidential candidate Nikki Haley is practically "running for Vice President" because she... |
 SkyNewsAustralia SkyNewsAustralia | 7h | |
|
|
|
 | Amazon announces a further 9,000 jobs cuts in latest round of layoffs |
| Amazon has announced it will cut another 9,000 jobs in the latest round of layoffs in the technology... |
 SkyNewsAustralia SkyNewsAustralia | 7h | |
|
|
|
 | Bailing out banks is almost 'incentivising' bad behaviour |
| Sky News host Rita Panahi says she is not a fan of bailing out banks and almost "incentivising" bad behaviour... |
 SkyNewsAustralia SkyNewsAustralia | 7h | |
|
|
|
 | Labor 'wise' not counting their 'chickens before they've roosted': Bruce Hawker on... |
| The NSW Labor party is "wise" to not count their "chickens before they've roosted" four days from the... |
 SkyNewsAustralia SkyNewsAustralia | 7h | |
|
|
|
 | Borderless Poetry: Watch our new series dedicated to the sounds and beauty of words |
| Euronews Culture is celebrating World Poetry Day by launching Borderless Poetry, a series of soothing,... |
 euronews (in English) euronews (in English) | 7h | |
|
|
|
 | XI BESUCHT PUTIN: Misstrauen aus den USA - "Man glaubt nicht an den chinesischen... |
| Der russische Präsident Wladimir Putin und sein chinesischer Kollege Xi Jinping haben bei einem Treffen... |
| |
|
|
|
 | FoxNewsChannel's YouTube Videos: Fox News presses the White House on China's budding... |
| ... |
 Trump News TV from Michael_Novakhov (10 sites) Trump News TV from Michael_Novakhov (10 sites) | 7h | |
|
|
|
 | Путин стыдно шутит |
| Путин встретился с предпринимателями и рассказал им, как отлично российская экономика справляется с санкциями.... |
 Штаб Навального Штаб Навального | 7h | |
|
|
|
 | Russia delivers enriched Uranium to France; 'Seventh delivery since Ukraine war began'... |
| On Monday, Russia delivered enriched uranium to France. A cargo ship unloaded cylinders of uranium from... |
| |
|
|
|
| Reports: Fungus Candida Auris has infected at least 2,377 in the U.S. | Latest World... |
| The disease that has a mortality rate of 60 has now spread to more than 35 states in the U.S and 40 countries... |
| |
|
|
|
 | Putin to Xi Jinping in Moscow: Russia, China have 'plenty of common objectives' |... |
| Russian President Vladimir Putin said on Monday that China's Ukraine "peace plan" could be discussed... |
| |
|
|
|
 | Путин теряет Африку и Латинскую Америку. Баунов о последствиях ордера на арест Путина |
| Анна Монгайт обсудила с Александром Бауновым последствия ордера на арест Путина, выданного международным... |
 tvrainru tvrainru | 7h | |
|
|
|
 | Fox News presses the White House on China's budding relationship with Russia |
| Fox News White House correspondent Peter Doocy presses John Kirby on national security concerns amid... |
 Fox News Fox News | 7h | |
|
|
|
 | How Mysterious Explosions In Bulgaria Are Connected To Russia's War In Ukraine |
| A string of mysterious explosions and a poisoning have targeted Bulgaria's arms industry, which has been... |
 Radio Free Europe/Radio Liberty Radio Free Europe/Radio Liberty | 7h | |
|
|
|
 | UnivisionNoticias's YouTube Videos: Clientes cuestionan que en muchos negocios la... |
| ... |
 Puerto Rico News Videos from Michael_Novakhov (20 sites) Puerto Rico News Videos from Michael_Novakhov (20 sites) | 7h | |
|
|
|
 | Protesters set fires in France as government survives no-confidence vote |
| Heaps of garbage left uncollected for days due to strikes were set alight by angry protesters in Paris... |
 Reuters Reuters | 7h | |
|
|
|
 | $7.5B raised for Türkiye, Syria quake recovery |
| An international donors conference has raised $7.5B for earthquake recovery and reconstruction projects... |
 TRT World TRT World | 7h | |
|
|
|
 | Albanese lashes out at media after question about Labor MPs breaking ranks on AUKUS |
| Prime Minister Anthony Albanese has lashed out against journalists to "have a bit of respect" after being... |
 SkyNewsAustralia SkyNewsAustralia | 8h | |
|
|
|
 | Treasury budget called into question over commodity forecasts missing targets |
| Treasurer Jim Chalmers and the Treasury Budget forecasts must be called into question over last October's... |
 SkyNewsAustralia SkyNewsAustralia | 8h | |
|
|
|
 | Businesses suffer as 'cost crisis' force labour shortages |
| Australian Chamber of Commerce and Industry CEO Andrew McKellar says businesses suffer from the "cost... |
 SkyNewsAustralia SkyNewsAustralia | 8h | |
|
|
|
 | RENTEN-RANDALE: Frankreich tobt wegen umstrittener Rentenreform - Über 140 Festnahmen |
| Umstrittene Rentenreform verabschiedet | Mehr als 140 Festnahmen bei Protesten in Paris | Regierung übersteht... |
| |
|
|
|
 | UK scientists are growing genetically edited wheat to reduce cancer risk from burnt... |
| Following a successful experiment, the UK is expected to give a green light to genetically edited wheat.... |
 euronews (in English) euronews (in English) | 8h | |
|
|
|
 | UK MP's report on Met police accuses officers of misogyny, racism |
| A damning report by an independent member of Britain's House of Lords has found that London's Metropolitan... |
 Al Jazeera English Al Jazeera English | 8h | |
|
|
|
 | Kenyan police fire tear gas, arrest opposition figures at protest |
| Kenyan police say a student was killed after officers opened fire during clashes with anti-government... |
 Al Jazeera English Al Jazeera English | 8h | |
|
|
|
 | Massive blaze destroys New Jersey church |
| Plumes of smoke could be seen from several miles around a church in Burlington, New Jersey that was burned... |
 Reuters Reuters | 8h | |
|
|
|
 | Heroes' welcome for Cuba's baseball team despite loss |
| Cubans celebrated the national baseball team in a ceremony after its semi-final run at the World Baseball... |
 Reuters Reuters | 8h | |
|
|
|
 | "Дни замороженного мертвого парня" в Колорадо |
| Команды бегунов в гриме и костюмах участвуют в "забегах в гробах" во время фестиваля Frozen Dead Guy... |
 euronews (на русском) euronews (на русском) | 8h | |
|
|
|
 | Австралия: реку очистят от тонн дохлой рыбы |
| Рыба начала умирать в реке Дарлинг возле города Менинди в штате Новый Южный Уэльс в пятницу. По словам... |
 euronews (на русском) euronews (на русском) | 8h | |
|
|
|
 | Shoots and scores: How director Ben Affleck explores the Nike / Michael Jordan partnership... |
| Director and actor Ben Affleck was at the South By Southwest festival to premiere his new film 'Air',... |
 euronews (in English) euronews (in English) | 8h | |
|
|
|
 | Light showers begins to fall as 12th atmospheric river arrives to Southern California |
| Light rain began to fall over Southern California as the 12th atmospheric river arrives to the region. |
 CBS Los Angeles CBS Los Angeles | 8h | |
|
|
|
 | What to consider before cutting the cord and converting to streaming |
| Cutting the cord may seem cheaper on paper, but experts say there are more aspects consumers should consider... |
 CBS Los Angeles CBS Los Angeles | 8h | |
|
|
|
 | Hour-by-hour look at looming precipitation |
| With just hours until heavy rain begins to fall across the Southland, Evelyn Taft takes a look at an... |
 CBS Los Angeles CBS Los Angeles | 8h | |
|
|
|
 | Kishida heads to Ukraine for talks with Zelenskyy |
| (21 Mar 2023) Japan's Prime Minister Fumio Kishida landed in Poland and was heading to Kyiv early Tuesday... |
 Associated Press Associated Press | 8h | |
|
|
|
 | 🔴Заявления для прессы Владимира Путина и Си Цзиньпина: прямая трансляция |
| Президент России Владимир Путин и его китайский коллега Си Цзиньпин выступают с заявлениями для представителей... |
 Комсомольская Правда Комсомольская Правда | 8h | |
|
|
|
 | 🔴Встреча Михаила Мишустина и Си Цзиньпина в Москве: прямая трансляция |
| Премьер-министр России Михаил Мишустин и председатель КНР Си Цзиньпин проводят двусторонние переговоры... |
 Комсомольская Правда Комсомольская Правда | 8h | |
|
|
|
 | 'Tragic' for universities to have 'bought into the idea' of being safe: Richard Dawkins |
| British evolutionary biologist and author Richard Dawkins says universities are places where people should... |
 SkyNewsAustralia SkyNewsAustralia | 8h | |
|
|
|
 | Ukraine calls for Russia to remove forces as they are 'not ready to negotiate' lives |
| Ukraine's People's Party Member Galyna Mykhailiuk says Ukraine is "not ready to negotiate" with people's... |
 SkyNewsAustralia SkyNewsAustralia | 8h | |
|
|
|
 | 'Let it be on the assets not on the people': Concerns raised for flooding in Doomadgee |
| Burke Shire Council Mayor Ernie Camp says the flood damages in the Doomadgee Aboriginal Shire Council... |
 SkyNewsAustralia SkyNewsAustralia | 8h | |
|
|
|
 | ASX 200 finished the day up on Tuesday |
| Sky News Business Reporter Edward Boyd says the ASX 200 finished the day up on Tuesday. |
 SkyNewsAustralia SkyNewsAustralia | 8h | |
|
|
|
 | Perrottet's advantage is his 'track record' with being able to work with the crossbench |
| NSW Premier Dominic Perrottet's advantage is his "track record" of being able to work with the crossbench,... |
 SkyNewsAustralia SkyNewsAustralia | 8h | |
|
|
|
 | Doctors will be on 'high alert' as people speak out about trans medical procedures |
| The Australian's Media Writer Sophie Elsworth says lawyers will be "very busy" and doctors should be... |
 SkyNewsAustralia SkyNewsAustralia | 8h | |
|
|
|
 | CHINESISCH-RUSSISCHE BEZIEHUNGEN: "China war schon immer der stärkere Partner" |
| Russlands Präsident Wladimir Putin hat zum Auftakt des Staatsbesuchs des chinesischen Präsidenten Xi... |
| |
|
|
|
 | msnbcleanforward's YouTube Videos: Trump indictment would only be a problem if he... |
| ... |
 Trump News TV from Michael_Novakhov (10 sites) Trump News TV from Michael_Novakhov (10 sites) | 8h | |
|
|
|
 | Clientes cuestionan que en muchos negocios la propina ya es un cobro obligatorio |
| Como premio a un buen servicio, es tradicional que los clientes de restaurantes dejen una propina que... |
 Univision Noticias Univision Noticias | 8h | |
|
|
|
 | Donald Trump: Political witch-hunt against leading Republican candidate | Latest... |
| New York police have tightened security ahead of a possible historic indictment of Donald Trump over... |
| |
|
|
|
 | Putin to Xi: Russia, China have 'plenty of common objectives' | Latest World News... |
| Russian President Vladimir Putin said on Monday that China's Ukraine "peace plan" could be discussed... |
| |
|
|
|
 | Xi Jinping: China values relationship with Russia | Latest World News | English News... |
| Russian President Vladimir Putin said on Monday that China's Ukraine "peace plan" could be discussed... |
| |
|
|
|
 | Biden signs bill on Covid origins declassification; China has denied a lab leak |... |
| Joe Biden has signed a bill that requires the declassification of information related to the origins... |
| |
|
|
|
 | 'A bit scared': OpenAI CEO says ChatGPT may wipe out current jobs | Trending on WION |
| Here, we bring you the news that is trending across WION's social media platforms - The AI powered ChatGPT... |
| |
|
|
|
 | Why you should be worried if Credit Suisse COLLAPSES | WION Business Watch |
| Credit Suisse is being taken over by UBS. Both are giant Swiss banks, but their investment banking arms... |
| |
|
|
|
 | Luxury car maker Lamborghini aims to REDUCE EMISSION by 50 per cent | WION Business... |
| Lamborghini will deploy hybrid technology in India in its models by 2024. The super-sports car maker... |
| |
|
|
|
 | Россиян попросят скинуться на ПВО |
| В Брянской области предложили закупать ПВО за счёт предпринимателей и местных жителей. Один из депутатов... |
 Штаб Навального Штаб Навального | 8h | |
|
|
|
 | California sheriff torches Gov. Newsom for leaving prison system in 'disarray' |
| A California sheriff blasted Gov. Gavin Newsom for leaving the state's prison system in "complete disarray"... |
 Fox News Fox News | 8h | |
|
|
|
 | Expertos creen se puede frenar la emergencia climática | Noticias Telemundo |
| Video oficial de Noticias Telemundo. El último informe de la ONU sobre el cambio climático concluye que... |
 NOTICIAS TELEMUNDO NOTICIAS TELEMUNDO | 8h | |
|
|
|
 | Tear gas, arrests as Kenya opposition stages protests | AFP |
| Kenyan riot police fire tear gas and water cannon against demonstrators joining a day of action called... |
| |
|
|
|
 | NCIS: Hawaii - Not Usually Surprised |
| Agent Holman goes to a spa with Kate in an attempt see how she's holding up. |
| |
|
|
|
 | NCIS: Hawaii - Money Always Wins |
| Agent Holman is caught in the crossfire as a deal goes sideways while attempting to gather evidence on... |
| |
|
|
|
 | Community shaken after student killed in shooting at Texas high school |
| A student has died after being shot by a fellow student at a high school in Arlington, Texas. The teenage... |
 NBC News NBC News | 8h | |
|
|
|
 | Will Australians get a public holiday for King Charles' coronation? |
| The coronation of King Charles III will be held on May 6. But will Australia get an extra public holiday... |
 news.com.au news.com.au | 8h | |
|
|
|
 | 'Creates An Enormous Lack Of Certainty For Our Farmers': Nick Langworthy Slams Biden... |
| At a House Rules Committee hearing on Tuesday, Rep. Nick Langworthy (R-NY) spoke about WOTUS. Fuel... |
 Forbes Under 30 Forbes Under 30 | 8h | |
|
|
|
 | UnivisionNoticias's YouTube Videos: El castigo que merecen los verdaderos culpables... |
| ... |
 Puerto Rico News Videos from Michael_Novakhov (20 sites) Puerto Rico News Videos from Michael_Novakhov (20 sites) | 8h | |
|
|
|
 | Trump indictment would only be a problem if he and GOP make it one (and they're trying) |
| Rachel Maddow explains that while Americans and the U.S. system of government is able to function smoothly... |
| |
|
|
|
 | Park Patrol shot at after inadvertently interrupting drug deal |
| The park rangers inadvertently interrupted the apparent drug deal during one of their daily park patrols. |
 CBS Los Angeles CBS Los Angeles | 8h | |
|
|
|
 | US aid worker, French journalist freed in Niger |
| (21 Mar 2023) An American aid worker held by Islamic extremists in West Africa and a French journalist... |
 Associated Press Associated Press | 8h | |
|
|
|
 | Медведев оказался шпионом / Ну и новости! |
| 00:00 Ну и новости! 01:13 Ордер орде не страшен 03:11 В Китае выбрали президента РФ 05:08 Не ссориться,... |
 Stepan Nexta Stepan Nexta | 9h | |
|
|
|
 | Meghan Markle claiming she didn't know the Royal Family was 'idiotic' |
| It was "idiotic" for Meghan Markle to claim she didn't know anything about the Royal Family when she... |
 SkyNewsAustralia SkyNewsAustralia | 9h | |
|
|
|
 | Shadow Treasurer slips up on mortgage question in Parliament |
| Shadow Treasurer Angus Taylor slipped up in Parliament by saying half of all mortgage holders will be... |
 SkyNewsAustralia SkyNewsAustralia | 9h | |
|
|
|
 | Royal Family 'bowing down' to Meghan and Harry's demands |
| The Royal Family "bowing down" to Prince Harry and Meghan Markle's demands is causing the Duke and Duchess... |
 SkyNewsAustralia SkyNewsAustralia | 9h | |
|
|
|
 | Xi Jinping and Vladimir Putin have a 'cozy relationship' |
| The Australian's Media Writer Sophie Elsworth says the meeting between Russian President Vladimir Putin... |
 SkyNewsAustralia SkyNewsAustralia | 9h | |
|
|
|
 | It would be a 'good thing' for Biden to address parliament during May visit |
| The Australian's Foreign Editor Greg Sheridan says it would be a "very good thing" for US President Joe... |
 SkyNewsAustralia SkyNewsAustralia | 9h | |
|
|
|
 | Meghan Markle 'fundamentally disrespected' Queen Elizabeth |
| Actor Brian Cox slammed Meghan Markle in a recent interview, saying the Duchess of Sussex sees herself... |
 SkyNewsAustralia SkyNewsAustralia | 9h | |
|
|
|
 | XI BEI PUTIN - Ziemlich beste Freunde? Auch Ukraine-Krieg Thema der Gespräche | WELT... |
| XI BEI PUTIN - Ziemlich beste Freunde? Auch Ukraine-Krieg Thema der Gespräche | WELT Newsstream Russlands... |
| |
|
|
|
 | DEUTSCHLAND: "Es ist dramatisch!" Milchbauern unter Bedrängnis! Produktion... |
| DEUTSCHLAND: "Es ist dramatisch!" Milchbauern unter Bedrängnis! Produktion steigt - Nachfrage sinkt ... |
| |
|
|
|
 | msnbcleanforward's YouTube Videos: U.S. takes politician indictments in stride; Trump... |
| ... |
 Trump News TV from Michael_Novakhov (10 sites) Trump News TV from Michael_Novakhov (10 sites) | 9h | |
|
|
|
 | msnbcleanforward's YouTube Videos: Trump's life-long record would make an indictment... |
| ... |
 Trump News TV from Michael_Novakhov (10 sites) Trump News TV from Michael_Novakhov (10 sites) | 9h | |
|
|
|
 | El castigo que merecen los verdaderos culpables del sismo bancario que sacude al... |
| El temblor financiero no solo ha puesto en riesgo millones de dólares en ahorros de los estadounidenses,... |
 Univision Noticias Univision Noticias | 9h | |
|
|
|
 | Amazon announces fresh round of layoffs, to cut 9,000 jobs in coming weeks | WION... |
| Amazon has revealed plans to cut around 9,000 jobs from its cloud services, advertising and Twitch units... |
| |
|
|
|
 | U.S. takes politician indictments in stride; Trump case should be no different: Maddow |
| Rachel Maddow reviews how regularly politicians at all levels of government in the United States are... |
| |
|
|
|
 | Time Now to Re-establish Bullish Positions in Oil: Hynes |
| Daniel Hynes, senior commodity strategist at Australia & New Zealand Banking Group Ltd., discusses... |
 Bloomberg TV Markets and Finance Bloomberg TV Markets and Finance | 9h | |
|
|
|
 | Seeds Have Been Sown for a US Credit Crunch: Poole |
| Isaac Poole, global chief investment officer and portfolio manager at Oreana Financial Services, discusses... |
 Bloomberg TV Markets and Finance Bloomberg TV Markets and Finance | 9h | |
|
|
|
 | Sri Lanka obtiene un rescate de 3.000 millones de dólares del FMI |
| Colombo (Sri Lanka), 21 mar (EFE/EPA).- El Fondo Monetario Internacional (FMI) aprobó un esperado rescate... |
 AGENCIA EFE AGENCIA EFE | 9h | |
|
|
|
 | Trump's life-long record would make an indictment unsurprising |
| Rachel Maddow points out all of the legal baggage Donald Trump brought to the office of the presidency,... |
| |
|
|
|
 | Ben Cline Asks DOJ Official Point Blank How Many Members Of His Staff Are Working... |
| At a House Judiciary Committee hearing earlier this month, Rep. (-) spoke about compliance with committee... |
 Forbes Under 30 Forbes Under 30 | 9h | |
|
|
|
 | UnivisionNoticias's YouTube Videos: Abuela de Ana Basaldua cuenta cómo siempre se... |
| ... |
 Puerto Rico News Videos from Michael_Novakhov (20 sites) Puerto Rico News Videos from Michael_Novakhov (20 sites) | 9h | |
|
|
|
 | UnivisionNoticias's YouTube Videos: Estrategia, propaganda o realidad: tensión y... |
| ... |
 Puerto Rico News Videos from Michael_Novakhov (20 sites) Puerto Rico News Videos from Michael_Novakhov (20 sites) | 9h | |
|
|
|
 | Weather watches and warnings issued with winter storm on the way |
| With the 12th atmospheric river of the winter season rolling into Southern California, the National Weather... |
 CBS Los Angeles CBS Los Angeles | 9h | |
|
|
|
 | PUTIN EMPFÄNGT XI: "Das Grauen für China wäre es, wenn es in Russland zu einem... |
| PUTIN EMPFÄNGT XI: "Das Grauen für China wäre es, wenn es in Russland zu einem Systemwechsel kommt" ... |
| |
|
|
|
 | Government acting to 'take the sting' out of rising power prices: Albanese |
| Prime Minister Anthony Albanese says the government is conscious of how rising electricity costs are... |
 SkyNewsAustralia SkyNewsAustralia | 9h | |
|
|
|
 | Biden signs bipartisan bill to declassify COVID-19 origins intelligence |
| President Joe Biden has signed a bipartisan bill ordering the federal government to declassify any intelligence... |
 SkyNewsAustralia SkyNewsAustralia | 9h | |
|
|
|
 | AUKUS will produce 20,000 'high paying, secure' jobs for Australians |
| Minister for Defence Industry Pat Conroy says the AUKUS rollout will produce about 20,000 "high-paying,... |
 SkyNewsAustralia SkyNewsAustralia | 9h | |
|
|
|
 | 'No surprise' Labor's electric campaign bus breaks down 'just like their budget':... |
| NSW Labor's net-zero, electric campaign bus has broken down as a result of not being charged. "It's... |
 SkyNewsAustralia SkyNewsAustralia | 9h | |
|
|
|
 | 'Not too late': World must 'up the game' to prevent global warming |
| Climate Change and Energy Minister Chris Bowen says the world is not doing enough to prevent global warming,... |
 SkyNewsAustralia SkyNewsAustralia | 9h | |
|
|
|
 | Greens must choose between making 'progress' or a 'point' with safeguard mechanism |
| Climate Change and Energy Minister Chris Bowen has given the Greens a choice with the government's proposed... |
 SkyNewsAustralia SkyNewsAustralia | 9h | |
|
|
|
 | Gospel music pioneer's history found in University of Pittsburgh archive |
| (21 Mar 2023) When the University of Pittsburgh bought Charles Henry Pace's gospel music archive in the... |
 Associated Press Associated Press | 9h | |
|
|
|
 | Paul Newman's camp heals after fire |
| (21 Mar 2023) Amarey Brookshire was devastated when she heard about the fire at the Hole in the Wall... |
 Associated Press Associated Press | 9h | |
|
|
|
 | Samsung not guilty of trademark infringement | WION Business Watch |
| Samsung Electronics Co Ltd convinced a Los Angeles federal jury that its Galaxy S10 phones do not violate... |
| |
|
|
|
 | Sri Lankan president vows to get economy back on track | Latest English News |
| Sri Lanka has secured a $3billion bailout from the International Monetary Fund (IMF) as it faces its... |
| |
|
|
|
 | Credit Suisse: European markets open in red, gains remain low | WION Business Watch |
| U.S. stocks climbed Monday on hopes for stability in the banking sector after regulators engineered a... |
| |
|
|
|
 | Million of U.S. vehicles are prone to theft | WION Business Watch |
| More than 20 U.S. state attorneys general on Monday urged Hyundai Motor and Kia Corp to do more to address... |
| |
|
|
|
 | Abuela de Ana Basaldua cuenta cómo siempre se opuso a que su nieta se inscribiera... |
| María Auxilio Zarco, abuela de la soldado Ana Fernanda Basaldúa, hallada muerta en la base militar de... |
 Univision Noticias Univision Noticias | 9h | |
|
|
|
 | Estrategia, propaganda o realidad: tensión y expectativa ante posibilidad de que... |
| El expresidente Donald Trump convocó a protestas tras asegurar a través de la plataforma Truth Social... |
 Univision Noticias Univision Noticias | 9h | |
|
|
|
 | Habla la maestra baleada por un alumno de 6 años | Noticias Telemundo |
| Video oficial de Noticias Telemundo. Abigail Zwerner, la maestra de 25 años baleada en la escuela por... |
 NOTICIAS TELEMUNDO NOTICIAS TELEMUNDO | 9h | |
|
|
|
 | Estos clientes serán más afectados por la quiebra de bancos | Telemundo Deportes |
| Video oficial de Noticias Telemundo. La incertidumbre generada por la caída de los bancos Sillicon Valley... |
 NOTICIAS TELEMUNDO NOTICIAS TELEMUNDO | 9h | |
|
|
|
 | U.S. aid worker and French journalist freed after being held hostage for years |
| U.S. aid worker Jeff Woodke and French journalist Olivier Dubois arrive at Niamey airport after they... |
 NBC News NBC News | 9h | |
|
|
|
 | Protesters in Paris torch trash over pension reform |
| Protesters set piles of garbage on fire in central Paris after President Emmanuel Macron's government... |
 Reuters Reuters | 9h | |
|
|
|
 | 'Is Wage Growth Universally Bad In Your View?': Sean Casten Presses Jerome Powell |
| Fuel your success with Forbes. Gain unlimited access to premium journalism, including breaking news,... |
 Forbes Under 30 Forbes Under 30 | 9h | |
|
|
|
 | A-Train Fatal | BROOKLYN, NY |
| BROOKLYN - Male in 20s fatally struck by southbound A-train 12:11 am Saturday at Broadway Junction train... |
 LOUDLABS NEWS LOUDLABS NEWS | 9h | |
|
|
|
 | 'Ted Lasso' cast make a special visit to the White House |
| The cast of "Ted Lasso" make a special visit to the White House to promote mental health. » Subscribe... |
| |
|
|
|
 | French students protest against pension reforms | AFP |
| Hundreds of students gather in central Paris on Monday night to demonstrate against French President... |
| |
|
|
|
 | Protesters demand South African President Ramaphosa to step down | AFP |
| South Africa's opposition holds rallies under tight security in a bid to force out President Cyril Ramaphosa... |
| |
|
|
|
 | This is a strike at the rule of law: David Schoen |
| Former Trump lawyer David Schoen shares his thoughts on the attempt to indict former President Trump... |
 Fox News Fox News | 9h | |
|
|
|
 | Gov. Newsom showcases lithium production in Imperial County |
| Imperial County, which has long been one of California's most neglected and forgotten corners, has gotten... |
 CBS Los Angeles CBS Los Angeles | 9h | |
|
|
|
 | Weather fatigue setting in on Angelenos with yet another storm looming |
| Nicole Comstock reports from Pasadena, where she spoke with a number of residents who are fed up with... |
 CBS Los Angeles CBS Los Angeles | 9h | |
|
|
|
 | Local fire departments preparing swift water rescue teams with heavy rain on the... |
| With yet another winter storm looming, local fire departments are busy warning residents to stay away... |
 CBS Los Angeles CBS Los Angeles | 9h | |
|
|
|
 | msnbcleanforward's YouTube Videos: 'Ted Lasso' cast make a special visit to the White... |
| ... |
 Trump News TV from Michael_Novakhov (10 sites) Trump News TV from Michael_Novakhov (10 sites) | 10h | |
|
|
|
 | msnbcleanforward's YouTube Videos: GOP rallies to defend Trump |
| ... |
 Trump News TV from Michael_Novakhov (10 sites) Trump News TV from Michael_Novakhov (10 sites) | 10h | |
|
|
|
 | MidweekPolitics's YouTube Videos: Alex Jones' Trump arrest conspiracy theory is NUTS |
| ... |
 Trump News TV from Michael_Novakhov (10 sites) Trump News TV from Michael_Novakhov (10 sites) | 10h | |
|
|
|
 | FoxNewsChannel's YouTube Videos: Gutfeld: The Hunter Biden investigation just took... |
| ... |
 Trump News TV from Michael_Novakhov (10 sites) Trump News TV from Michael_Novakhov (10 sites) | 10h | |
|
|
|
 | Israel Judicial Reforms: Opposition vows to take judicial reforms to Supreme Court... |
| Israeli Prime Minister Benjamin Netanyahu announced a softening of his judicial overhaul plan on Monday... |
| |
|
|
|
 | UK: New York cops tighten security ahead of possible historic indictment | Latest... |
| New York police have tightened security ahead of a possible historic indictment of Donald Trump over... |
| |
|
|
|
 | Did Trump pay adult-film star to not discuss the encounter? New York braces for drama... |
| New York police have tightened security ahead of a possible historic indictment of Donald Trump over... |
| |
|
|
|
 | Climate time bomb is ticking, expect more floods, cyclones and droughts: UN Chief... |
| U.N. Secretary General Antonio Guterres warned that the climate time bomb is ticking as he urged rich... |
| |
|
|
|
 | Australian nuclear subs production line to be a 'significant' centre of engineering |
| Defence Minister Richard Marles says the nuclear submarine production line to be established in Australia... |
 SkyNewsAustralia SkyNewsAustralia | 10h | |
|
|
|
 | PM won't be 'ecstatic' over Labor MPs breaking ranks on AUKUS |
| Prime Minister Anthony Albanese won't be ecstatic after Fremantle Labor MP Josh Wilson broke ranks with... |
 SkyNewsAustralia SkyNewsAustralia | 10h | |
|
|
|
 | 'Hang in there': Albanese claps back at Liberal MP Karen Andrews |
| Prime Minister Anthony Albanese has hit back at Liberal MP Karen Andrews for her claims the Labor government... |
 SkyNewsAustralia SkyNewsAustralia | 10h | |
|
|
|
 | Albanese pays tribute to NRL 'legend' John Sattler |
| Prime Minister Anthony Albanese took a moment during parliamentary Question Time to remember and pay... |
 SkyNewsAustralia SkyNewsAustralia | 10h | |
|
|
|
 | Doomadgee's 'major infrastructure' services still down following floods |
| Doomadgee Aboriginal Shire Council CEO Troy Fraser says "major infrastructure" services took a hit in... |
 SkyNewsAustralia SkyNewsAustralia | 10h | |
|
|
|
 | Peter Dutton supports Voice machinery bill without funding for Yes or No case |
| Opposition leader Peter Dutton appears set to support the government's Voice referendum machinery Bill... |
 SkyNewsAustralia SkyNewsAustralia | 10h | |
|
|
|
 | Matt Kean's personal vote slumps in Liberal 'safe seat' of Hornsby |
| Sky News Political Editor Andrew Clennell reveals NSW Treasurer and Energy Minister Matt Kean is facing... |
 SkyNewsAustralia SkyNewsAustralia | 10h | |
|
|
|
 | 'Everyone's terrified': Prince Harry and Meghan becoming 'more outrageous' |
| News Corp columnist Louise Roberts says Prince Harry and Meghan Markle are becoming "increasingly more... |
 SkyNewsAustralia SkyNewsAustralia | 10h | |
|
|
|
 | US Studies Ways to Guarantee All Bank Deposits if Crisis Grows |
| US officials are said to be studying ways that might temporarily expand FDIC to all deposits, a move... |
 Bloomberg TV Markets and Finance Bloomberg TV Markets and Finance | 10h | |
|
|
|
 | Беженцы из России и Украины: как они живут рядом в Берлине? |
| Власти района Лихтенберг на востоке Берлина активно поддерживают тех, кто бежал от войны. Речь как об... |
 DW (Russian) DW (Russian) | 10h | |
|
|
|
 | México cayó ante Japón en el Clásico Mundial de Béisbol | Telemundo Deportes |
| Video oficial de Noticias Telemundo. Aunque no pudo vencer a Japón y avanzar a la final, el equipo mexicano... |
 NOTICIAS TELEMUNDO NOTICIAS TELEMUNDO | 10h | |
|
|
|
 | Operation Iraqi Freedom: 20 years later |
| Twenty years ago this week the U.S. carried out its first airstrikes and begin its ground invasion of... |
| |
|
|
|
 | Xi Jinping Visits Putin After The Russian President's Arrest Warrant |
| Xi Jinping has landed in Russia's capital, showing crucial support for Vladimir Putin - though he could... |
 news.com.au news.com.au | 10h | |
|
|
|
 | 'Ted Lasso' Cast Visits White House to Discuss Mental Health |
| Jason Sudeikis and other members of the "Ted Lasso" cast appeared at a White House press briefing Monday... |
 news.com.au news.com.au | 10h | |
|
|
|
 | Xi Jinping Visits Putin After The Russian President's Arrest Warrant |
| Xi Jinping has landed in Russia's capital, showing crucial support for Vladimir Putin - though he could... |
 news.com.au news.com.au | 10h | |
|
|
|
 | 'Biden's Been The Weakest President Since Jimmy Carter': Graham Predicts China Will... |
| At an event on Saturday, Sen. Lindsey Graham (R-SC) slammed President Biden for foreign policy "weakness"... |
 Forbes Under 30 Forbes Under 30 | 10h | |
|
|
|
 | White House Asked If They're Concerned About Threat Of Violence Ahead Of Trump's... |
| During Monday's White House Press Briefing, Karine Jean-Pierre spoke about former President Donald Trump... |
 Forbes Under 30 Forbes Under 30 | 10h | |
|
|
|
 | GOP rallies to defend Trump |
| Republicans rush to defend Trump as he faces a possible indictment in a hush money case. But Gov. Ron... |
| |
|
|
|
 | White House urges Xi to press Putin on Ukraine |
| The White House urged Chinese President Xi Jinping to use his visit to Moscow this week to tell Russian... |
| |
|
|
|
 | Balance of Power Full Show (03/20/2023) |
| On "Balance of Power" on Monday March 20th 2023: Cornell University Professor of Law Robert Hockett on... |
 Bloomberg TV Markets and Finance Bloomberg TV Markets and Finance | 10h | |
|
|
|
 | LAUSD, unions fail to reach agreement to prevent strike |
| On Monday afternoon, Superintendent Alberto Carvalho announced that schools will close in anticipation... |
 CBS Los Angeles CBS Los Angeles | 10h | |
|
|
|
 | msnbcleanforward's YouTube Videos: Tribe: Trump lawyers' GA filing 'obviously designed... |
| ... |
 Trump News TV from Michael_Novakhov (10 sites) Trump News TV from Michael_Novakhov (10 sites) | 10h | |
|
|
|
 | ABC News's YouTube Videos: Photojournalist looks back on capturing 'toll of the war... |
| ... |
 Trump News TV from Michael_Novakhov (10 sites) Trump News TV from Michael_Novakhov (10 sites) | 10h | |
|
|
|
 | ABC News's YouTube Videos: Former museum guard's journey to find comfort in the beauty... |
| ... |
 Trump News TV from Michael_Novakhov (10 sites) Trump News TV from Michael_Novakhov (10 sites) | 10h | |
|
|
|
 | South Africa arrests 87 before planned antigovernment protest |
| Security forces say 87 people were arrested before a planned protest by South Africa's third-largest... |
 Al Jazeera English Al Jazeera English | 10h | |
|
|
|
 | Paris protests continue against new retirement age |
| (21 Mar 2023) Groups of angry demonstrators took to Paris' streets in the wake of the adoption by parliament... |
 Associated Press Associated Press | 10h | |
|
|
|
 | 'Committed to saying no: Albanese on Coalition's 'denial' of climate change |
| Prime Minister Anthony Albanese says the Coalition is "committed to saying no" after a "decade of denial"... |
 SkyNewsAustralia SkyNewsAustralia | 10h | |
|
|
|
 | 'He's at it again': Albanese targets Dutton after Question Time interjection |
| Prime Minister Anthony Albanese targeted Opposition Leader Peter Dutton for his interjections during... |
 SkyNewsAustralia SkyNewsAustralia | 10h | |
|
|
|
 | Trump is "poison" for the Republicans |
| #shorts The Australian's Foreign Editor Greg Sheridan says Donald Trump has been 'absolute poison' for... |
 SkyNewsAustralia SkyNewsAustralia | 10h | |
|
|
|
 | Gwyneth Paltrow 'doesn't look great' on her 'starvation diet' |
| #shorts Sky News contributor Esther Krakue says Gwyneth Paltrow 'couldn't eat more than 600 calories'... |
 SkyNewsAustralia SkyNewsAustralia | 10h | |
|
|
|
 | Host mocks trans woman's exaggerated story |
| #shorts Sky news host Rita Panahi has mocked a trans woman's unbelievable story which said a man was... |
 SkyNewsAustralia SkyNewsAustralia | 10h | |
|
|
|
 | 'Woke' children's Netflix series is 'already cancelled' |
| #shorts Sky News host Rita Panahi says a Netflix series which focused on a non-binary character has 'already... |
 SkyNewsAustralia SkyNewsAustralia | 10h | |
|
|
|
 | Premier Perrottet campaigns in Goulburn ahead of state election |
| NSW Premier Dominic Perrottet has been out on the campaign trail making coffees and talking to voters... |
 SkyNewsAustralia SkyNewsAustralia | 10h | |
|
|
|
 | Government placing 'downward pressure' on inflation: Albanese |
| Prime Minister Anthony Albanese says the Labor government is placing "downward pressure" on inflation... |
 SkyNewsAustralia SkyNewsAustralia | 10h | |
|
|
|
 | Sydney ranked second least affordable city in the world |
| Sydney's housing market has been ranked the second least affordable in the world, according to the Demographia... |
 SkyNewsAustralia SkyNewsAustralia | 10h | |
|
|
|
 | Изменение климата изменит Европу навсегда. Как именно? |
| Каким будет климат в разных регионах Европы через 50 лет ЧИТАТЬ ДАЛЕЕ : https://ru.euronews.com/2023/03/21/cube-biodiversity-changes-europe... |
 euronews (на русском) euronews (на русском) | 10h | |
|
|
|
 | New Miami Beach curfew voted down as city faces spring break violence |
| Gunfire broke out during Miami Beach spring break and Saint Patrick's Day celebrations killing at least... |
| |
|
|
|
 | After arrest warrant for Putin, Russia opens case against ICC |
| Russia has opened its own criminal investigation into the International Criminal Court's (ICC) prosecutor... |
 Al Jazeera English Al Jazeera English | 10h | |
|
|
|
 | The importance of allies in 2023 #gzeroworld #shorts |
| |
 GZERO Media GZERO Media | 10h | |
|
|
|
 | 'Things get better': Elizabeth Smart's sister to Idaho victims' families |
| Mary Katherine Smart, sister of kidnapping victim Elizabeth Smart, gives advice to #Idaho4 victims' families. |
 NewsNation Now NewsNation Now | 10h | |
|
|
|
 | Mystery minion sculptures appearing around regional town |
| Minion sculptures inspired by 'Despicable Me' are mysteriously popping up in this regional town and no... |
 news.com.au news.com.au | 10h | |
|
|
|
 | Alex Jones' Trump arrest conspiracy theory is NUTS |
| -- Infowars conspiracy theorist Alex Jones' conspiracy theory about Donald Trump's potentially forthcoming... |
 David Pakman Show David Pakman Show | 10h | |
|
|
|
 | Bob Hearts Abishola - Attending the Funeral |
| Abishola makes a major blunder at a family service. |
| |
|
|
|
 | Bob Hearts Abishola - I'm Just Sorry I Asked |
| Abishola and Dottie explain some complicated family history. |
| |
|
|
|
 | 'The World's Becoming A More Dangerous Place': McCaul Requests Funding For House... |
| At a House Administration Committee hearing earlier this month, Rep. Michael McCaul (R-TX) and Rep. Gregory... |
 Forbes Under 30 Forbes Under 30 | 10h | |
|
|
|
 | Biden Is 'Putting Our Very Financial System At Risk': Erin Houchin |
| At Sunday's House GOP leadership press briefing, Rep. Erin Houchin (R-IN) slammed President Biden, and... |
 Forbes Under 30 Forbes Under 30 | 10h | |
|
|
|
 | 'Reckless Spending': GOP Lawmaker Hammers Biden And Dems Over Inflation |
| At a House Republican bilingual press briefing on Monday, Rep. Carlos Gimenez (R-FL) spoke about ... |
 Forbes Under 30 Forbes Under 30 | 10h | |
|
|
|
 | GOP Lawmaker Demands Apology From Elizabeth Warren After Exchange With Fed Chair... |
| During a House Financial Services Committee hearing earlier this month, Rep. John Rose (R-TN) questioned... |
 Forbes Under 30 Forbes Under 30 | 10h | |
|
|
|
 | 'It's An Inefficiency That's Happening Across The Country': Pete Sessions Bemoans... |
| Jerome Powell, Chair of the Federal Reserve, testified before the House Financial Services Committee,... |
 Forbes Under 30 Forbes Under 30 | 10h | |
|
|
|
 | Rudy Yakym And Jamie Raskin Tangle Over Amendment To REIN IN Act |
| Earlier this month Reps. Rudy Yakym (R-IN) and Jamie Raskin (D-MD) clashed over the latter's amendment... |
 Forbes Under 30 Forbes Under 30 | 10h | |
|
|
|
 | White House hails effort to release hostage Jeffery Woodke |
| White House National Security spokesperson John Kirby hailed the 'hard, grueling' team effort to secure... |
| |
|
|
|
 | First Republic shares fall on fresh liquidity fears |
| Shares of First Republic Bank slumped after a report the regional bank could raise more money fanned... |
| |
|
|
|
 | Tribe: Trump lawyers' GA filing 'obviously designed to delay' |
| Professor Laurence Tribe joins MSNBC's Lawrence O'Donnell to discuss the "bizarre" filing by Trump's... |
| |
|
|
|
 | Lawrence: Don't worry about violent Trump mob invading Manhattan |
| MSNBC's Lawrence O'Donnell analyzes new the developments in Manhattan District Attorney Alvin Bragg's... |
| |
|
|
|
 | Manhattan grand jury hears from Trump witness |
| Trump ally Robert Costello met with the Manhattan grand jury to undercut Michael Cohen's testimony in... |
| |
|
|
|
 | vozdeamerica's YouTube Videos: El Mundo al Día |
| ... |
 Puerto Rico News Videos from Michael_Novakhov (20 sites) Puerto Rico News Videos from Michael_Novakhov (20 sites) | 10h | |
|
|
|
 | Investors Await Next Rally |
| As investors in collapsed banks lick their wounds, some big fund managers are preparing so they don't... |
 Bloomberg TV Markets and Finance Bloomberg TV Markets and Finance | 10h | |
|
|
|
 | Hong Kong's Family Office Ambitions |
| Hong Kong Secretary for Financial Services & the Treasury Christopher Hui discusses the banking crisis... |
 Bloomberg TV Markets and Finance Bloomberg TV Markets and Finance | 10h | |
|
|
|
 | msnbcleanforward's YouTube Videos: Manhattan grand jury hears from Trump witness |
| ... |
 Trump News TV from Michael_Novakhov (10 sites) Trump News TV from Michael_Novakhov (10 sites) | 11h | |
|
|
|
 | FoxNewsChannel's YouTube Videos: African reporter hits back at Karine Jean-Pierre... |
| ... |
 Trump News TV from Michael_Novakhov (10 sites) Trump News TV from Michael_Novakhov (10 sites) | 11h | |
|
|
|
 | Yet another winter storm predicted to bring heavy rain, feet of snow |
| Evelyn Taft walks us through the latest winter storm that is expected to bring anywhere up to three inches... |
 CBS Los Angeles CBS Los Angeles | 11h | |
|
|
|
 | Three injured in shooting nearly elementary school in South LA |
| Three people are expected to recover after suffering gunshot wounds during a triple-shooting in South... |
 CBS Los Angeles CBS Los Angeles | 11h | |
|
|
|
 | Xi Jinping: China values relationship with Russia | Latest English News |
| Russian President Vladimir Putin said on Monday that China's Ukraine "peace plan" could be discussed... |
| |
|
|
|
 | IMF approves $3 billion bailout for bankrupt Sri Lanka | Latest English News |
| Sri Lanka has secured a $3billion bailout from the International Monetary Fund (IMF) as it faces its... |
| |
|
|
|
 | Miles de personas firman una petición para que esta familia pueda quedarse con su... |
| La familia de Denny Lacoste adoptó a 'Neuty' desde que era bebé y durante dos años lo ha domesticado... |
 Univision Noticias Univision Noticias | 11h | |
|
|
|
 | 'We don't see the burning deck': Assistant Treasurer addresses interest rate rises |
| Assistant Treasurer Stephen Jones says "we don't see there is a burning deck" when he was asked about... |
 SkyNewsAustralia SkyNewsAustralia | 11h | |
|
|
|
 | 'Change of government' did not cause supply chain and inflation woes: Albanese |
| Prime Minister Anthony Albanese says the Opposition would have Australians believe there was no inflation... |
 SkyNewsAustralia SkyNewsAustralia | 11h | |
|
|
|
 | AUKUS about promoting 'stability, security and prosperity' in our region: Albanese |
| Prime Minister Anthony Albanese says AUKUS is about promoting "stability, security and prosperity" in... |
 SkyNewsAustralia SkyNewsAustralia | 11h | |
|
|
|
 | QLD Premier should be 'commended' for rental cap proposal |
| Queensland Council of Social Service CEO Professor Aimee McVeigh says Queensland Premier Annastacia Palaszczuk... |
 SkyNewsAustralia SkyNewsAustralia | 11h | |
|
|
|
 | Doomadgee Aboriginal Shire has been cut off for 'three months' following major flooding |
| Doomadgee Aboriginal Shire Council CEO Troy Fraser says the recent floods in the area have cut them off... |
 SkyNewsAustralia SkyNewsAustralia | 11h | |
|
|
|
 | Inflation is a 'global phenomenon': Anthony Albanese |
| Prime Minister Anthony Albanese says inflation is a "global phenomenon" that has led to an increase in... |
 SkyNewsAustralia SkyNewsAustralia | 11h | |
|
|
|
 | NASA announces upcoming moon mission |
| NASA will announce the crew members for its first moon mission in over 50 years next week. A crewed... |
 SkyNewsAustralia SkyNewsAustralia | 11h | |
|
|
|
 | Progress on climate change action is being 'swallowed up' by China |
| Shadow Climate Change and Energy Minister Ted O'Brien says while Australia and other nations have done... |
 SkyNewsAustralia SkyNewsAustralia | 11h | |
|
|
|
 | Oklahoma police captain asks officer to turn off bodycam during DUI arrest |
| An Oklahoma police captain was caught on video asking an officer several times to turn off his body camera... |
| |
|
|
|
 | Top Story with Tom Llamas - March 20 | NBC News NOW |
| President Emmanuel Macron survives a no-confidence vote putting the new French pension plan into law,... |
| |
|
|
|
 | Girl Scout Troop 6000 gives one-of-a-kind sisterhood to girls in NYC shelter system |
| Girl Scout Troop 6000 was launched in 2017 by a single mother of five who had lost her home and wanted... |
| |
|
|
|
 | First Alert weather: CBS2 11 p.m. forecast |
| CBS2's Lonnie Quinn is calling for a mild Tuesday, with sunshine and a high of 62. |
 CBS New York CBS New York | 11h | |
|
|
|
 | Brooklyn nonprofit struggling financially due to NYC bureaucracy |
| CBS2's Marcia Kramer takes a look at the effects on the Center for Community Alternatives, which has... |
 CBS New York CBS New York | 11h | |
|
|
|
 | Vigil held for victims in Scarsdale car crash |
| Five people, including the 16-year-old unlicensed driver, were killed in the wreck on the Hutchinson... |
 CBS New York CBS New York | 11h | |
|
|
|
 | Investigation continues into deadly multi-vehicle accident in Bensonhurst |
| Mangled car parts littered the area where the crash happened. Witnesses said the car that started the... |
 CBS New York CBS New York | 11h | |
|
|
|
 | New York Young Republican Club rallies for Donald Trump |
| The group gathered peacefully in Lower Manhattan on the same day the NYPD started beefing up security... |
 CBS New York CBS New York | 11h | |
|
|
|
 | Donald Trump says he'll be indicted Tuesday, but nobody knows for sure |
| CBS2's Dick Brennan has the latest on the investigation and what the NYPD is doing to prepare for potential... |
 CBS New York CBS New York | 11h | |
|
|
|
 | Gutfeld: The Hunter Biden investigation just took an interesting turn |
| Fox News host Greg Gutfeld reacts to Hunter Biden suing the shop owner who turned in Hunter's laptop... |
| |
|
|
|
 | If Donald Trump is indicted, what happens next? Will he take a mugshot? What about... |
| Donald Trump announced over the weekend that he expects to be "arrested" this week as a New York grand... |
 FOX 10 Phoenix FOX 10 Phoenix | 11h | |
|
|
|
 | Five-alarm fire engulfs Fountain of Life church in New Jersey | LiveNOW from FOX |
| Fire crews were on scene of a roaring five-alarm fire that they say ripped through the Fountain of Life... |
 FOX 10 Phoenix FOX 10 Phoenix | 11h | |
|
|
|
 | Woman blazes trail as commanding officer of counterterrorism unit |
| Leading NYPD's Counterterrorism division is Assistant Chief Judith Harrison's latest assignment. ... |
 Eyewitness News ABC7NY Eyewitness News ABC7NY | 11h | |
|
|
|
 | Massive fire destroys New Jersey church |
| Firefighters are battling an 8-alarm blaze at the Fountain of Life Center church in Burlington County,... |
 Eyewitness News ABC7NY Eyewitness News ABC7NY | 11h | |
|
|
|
 | 2 dead, 5 injured when car jumps curb, goes onto sidewalk in Brooklyn |
| Two people were killed and five were injured after a car crashed and jumped a curb before going onto... |
 Eyewitness News ABC7NY Eyewitness News ABC7NY | 11h | |
|
|
|
 | Police: Suspect carried dead body in trunk for days | Banfield |
| A man previously arrested on other charges in the Nathan Millard death investigation now faces new charges,... |
 NewsNation Now NewsNation Now | 11h | |
|
|
|
 | Murdaugh attorney blasts rumors linking Buster to teen's death |
| The Murdaugh family attorney explains to Chris Cuomo why Buster released a statement about the death... |
 NewsNation Now NewsNation Now | 11h | |
|
|
|
 | San Francisco official wants more police after pushing to defund | Dan Abrams Live |
| Hillary Ronen, San Francisco supervisor for District 9, wants a bigger police presence in the communities... |
 NewsNation Now NewsNation Now | 11h | |
|
|
|
 | Photojournalist looks back on capturing 'toll of the war on both sides' in Iraq |
| ABC News' Linsey Davis spoke with Pulitzer Prize-winning photojournalist Lynsey Addario about her experience... |
| |
|
|
|
 | Former museum guard's journey to find comfort in the beauty and solitude of art |
| ABC News' Kyra Phillips profiles Patrick Bringley, author of "All the Beauty in the World," a former... |
| |
|
|
|
 | The Neighborhood - Could Be an Animal |
| Tina hears loud noises downstairs and sends Calvin to investigate. |
| |
|
|
|
 | The Neighborhood - No Pressure |
| Tina sends Marty and Malcolm to get food after their fridge is ransacked, and Gemma gives a suggestion... |
| |
|
|
|
 | GOP Lawmaker Confronts FBI Director Wray Detailing Accusations Of 'Targeting Parents' |
| At a House Intelligence Committee hearing earlier this month, Rep. Chris Stewart (R-UT) questioned intelligence... |
 Forbes Under 30 Forbes Under 30 | 11h | |
|
|
|
 | UnivisionNoticias's YouTube Videos: Miles de personas firman una petición para que... |
| ... |
 Puerto Rico News Videos from Michael_Novakhov (20 sites) Puerto Rico News Videos from Michael_Novakhov (20 sites) | 11h | |
|
|
|
 | UnivisionNoticias's YouTube Videos: 🔴 En vivo ViX: Noticias Univision 24/7 Nocturna,... |
| ... |
 Puerto Rico News Videos from Michael_Novakhov (20 sites) Puerto Rico News Videos from Michael_Novakhov (20 sites) | 11h | |
|
|
|
 | Wapa TV's YouTube Videos: Donald Trump asegura que será arrestado en los próximos... |
| ... |
 Puerto Rico News Videos from Michael_Novakhov (20 sites) Puerto Rico News Videos from Michael_Novakhov (20 sites) | 11h | |
|
|
|
 | Timeline: 20 Years Since Start of US War in Iraq | VOA News |
| Two decades ago, after months of rhetoric and international debate, former United States President, George... |
| |
|
|
|
 | Major Kennedy Expressway construction project begins |
| Bronagh Tumulty reports on the latest when it comes to Chicago's next long-term road construction project.... |
| |
|
|
|
 | CBSNewsOnline's YouTube Videos: Analyzing Iraq's future 20 years after U.S.-led invasion... |
| ... |
 Trump News TV from Michael_Novakhov (10 sites) Trump News TV from Michael_Novakhov (10 sites) | 11h | |
|
|
|
 | ABC News's YouTube Videos: Amin Joseph on final season of 'Snowfall': 'Our hearts... |
| ... |
 Trump News TV from Michael_Novakhov (10 sites) Trump News TV from Michael_Novakhov (10 sites) | 11h | |
|
|
|
 | msnbcleanforward's YouTube Videos: 'This is an embarrassing abuse of power': Expert... |
| ... |
 Trump News TV from Michael_Novakhov (10 sites) Trump News TV from Michael_Novakhov (10 sites) | 11h | |
|
|
|
 | ABC News's YouTube Videos: Soldiers look back 20 years after start of Iraq War |
| ... |
 Trump News TV from Michael_Novakhov (10 sites) Trump News TV from Michael_Novakhov (10 sites) | 11h | |
|
|
|
 | CBSNewsOnline's YouTube Videos: China's President Xi Jingping meets with Russian... |
| ... |
 Trump News TV from Michael_Novakhov (10 sites) Trump News TV from Michael_Novakhov (10 sites) | 11h | |
|
|
|
 | ABC News's YouTube Videos: Suspect flees LAPD officers on skateboard | ABC News |
| ... |
 Trump News TV from Michael_Novakhov (10 sites) Trump News TV from Michael_Novakhov (10 sites) | 11h | |
|
|
|
 | Colombia braces for crucial vote on banning bullfights |
| (21 Mar 2023) A 61-year-old matador nicknamed "Little gypsy of America" fell headfirst into the dust... |
 Associated Press Associated Press | 11h | |
|
|
|
 | GOP lawmakers respond to possible Trump indictment |
| House Republicans were attending a retreat in Florida on Monday as a possible indictment of former President... |
| |
|
|
|
 | Analyzing Iraq's future 20 years after U.S.-led invasion began |
| Monday marked 20 years since the U.S.-led ground invasion of Iraq began. CBS News' Charlie D'Agata joined... |
| |
|
|
|
 | 'This is an embarrassing abuse of power': Expert on GOP calls to investigate Trump's... |
| As we await the first of possibly multiple criminal charges against Donald Trump, many Republicans are... |
| |
|
|
|
 | 🔴 En vivo ViX: Noticias Univision 24/7 Nocturna, 20 de marzo del 2023 |
| En @vix ésta y más noticias 24 horas Noticias 24/7 en ViX: https://bit.ly/3LBhvTK #ViX en redes... |
 Univision Noticias Univision Noticias | 11h | |
|
|
|
 | Protests erupt in France as govt adopts new pension law • FRANCE 24 English |
| Protests erupted across France on Monday night, hours after the government adopted deeply unpopular pension... |
 FRANCE 24 English FRANCE 24 English | 11h | |
|
|
|
 | China criticizes International Criminal Court for charges against Putin |
| China has criticised the International Criminal Court for criminal war charges against Russia's president... |
 SkyNewsAustralia SkyNewsAustralia | 11h | |
|
|
|
 | NSW paramedics to leave low risk patients unattended at hospitals |
| New South Wales paramedics are launching a week of industrial action in an effort to prevent ambulance... |
 SkyNewsAustralia SkyNewsAustralia | 11h | |
|
|
|
 | L.A. schools close over employee strike |
| Thousands of employees at Los Angeles Unified Schools will be on strike leaving more than half a million... |
| |
|
|
|
 | Rain in forecast for tri-state area later this week |
| The next two days will feature very nice weather around the tri-state area, but the chance for rain will... |
| |
|
|
|
 | Crews battle massive fire at church in Burlington County, New Jersey |
| Heavy smoke and flames poured out of the Fountain of Life Center Academy Church in Florence Township.... |
 CBS New York CBS New York | 11h | |
|
|
|
 | Search on for suspect who torched 2 NYPD vehicles |
| It happened in the Flatiron District. The vehicles were not in use and no one was hurt. CBS2's Maurice... |
 CBS New York CBS New York | 11h | |
|
|
|
 | Настоящее Время. Америка |
| Прямой эфир ежедневной информационной программы из студии в Вашингтоне |
 Голос Америки Голос Америки | 11h | |
|
|
|
 | African reporter hits back at Karine Jean-Pierre for not calling on him |
| Today News Africa correspondent Simon Ateba explains why he got into a shouting match with White House... |
| |
|
|
|
 | Idaho legislature approves firing squad executions | Banfield |
| Idaho is poised to allow firing squads to execute condemned inmates when the state can't get lethal-injection... |
 NewsNation Now NewsNation Now | 11h | |
|
|
|
 | 'Things get better': Elizabeth Smart's sister on Idaho victims' families | Banfield |
| Mary Katherine Smart was just 9 years old when her sister Elizabeth Smart was kidnapped out of the same... |
 NewsNation Now NewsNation Now | 11h | |
|
|
|
 | 2 dead, 5 injured in Brooklyn car crash: NYPD |
| Two people died and several others were injured in a car crash in Brooklyn on Monday afternoon, authorities... |
| |
|
|
|
 | Adams signs bills to combat lithium-ion battery fires |
| Mayor Eric Adams signed into law Monday a package of bills aimed at regulating lithium-ion batteries,... |
| |
|
|
|
 | How we can avoid irreversible effects of climate change? |
| Extreme weather is becoming increasingly common all over the planet, and the United Nations has delivered... |
 Global News Global News | 11h | |
|
|
|
 | Italian motocross champion uses passion to help others | Focus on Europe |
| Freestyle motocross champion Vanni Oddera puts a smile on disabled and sick children's faces by giving... |
 DW (English) DW (English) | 11h | |
|
|
|
 | El Mundo al Día |
| Los acontecimientos de Estados Unidos, América Latina y el mundo, en 30 minutos. Con corresponsales en... |
 Voz de América Voz de América | 11h | |
|
|
|
 | Amin Joseph on final season of 'Snowfall': 'Our hearts are gonna be ripped out' |
| ABC News' Linsey Davis spoke with actor Amin Joseph on the final season of the hit FX series "Snowfall,"... |
| |
|
|
|
 | Soldiers look back 20 years after start of Iraq War |
| ABC News' Stephanie Ramos looks back on her time serving in Iraq, joining a group of service members... |
| |
|
|
|
 | Catherine Cortez Masto Pushses Jerome Powell Over Affordable Housing Crisis |
| Jerome Powell, the Chairman of the Federal Reserve, was questioned by Senator Catherine Cortez Masto... |
 Forbes Under 30 Forbes Under 30 | 11h | |
|
|
|
 | All Hell Breaks Loose At Press Briefing After Reporter Goes On Tirade Against Karine... |
| On Monday, Karine Jean-Pierre held a White House Press Briefing and was interrupted by heckling and fighting.... |
 Forbes Under 30 Forbes Under 30 | 11h | |
|
|
|
 | 'So Which Is It?': Andy Barr Grills Jerome Powell Over Climate Oriented Policies |
| Jerome Powell, Chair of the Federal Reserve, testified before the House Financial Services Committee,... |
 Forbes Under 30 Forbes Under 30 | 11h | |
|
|
|
 | France protest: Police fire tear gas on protestors | Latest English News |
| Protests continue throughout France as thousands of people marched through the country amidst anger against... |
| |
|
|
|
 | Putin: Open to discuss China's peace-plan | Latest English News |
| Russian President Vladimir Putin said that China's Ukraine peace plan could be discussed and that Moscow... |
| |
|
|
|
 | msnbcleanforward's YouTube Videos: Charles Blow: There's no equivalent to what Trump's... |
| ... |
 Trump News TV from Michael_Novakhov (10 sites) Trump News TV from Michael_Novakhov (10 sites) | 11h | |
|
|
|
 | MidweekPolitics's YouTube Videos: Why do MAGA Trumpists love authoritarianism? |
| ... |
 Trump News TV from Michael_Novakhov (10 sites) Trump News TV from Michael_Novakhov (10 sites) | 11h | |
|
|
|
 | FoxNewsChannel's YouTube Videos: Dr. Mark Hyman: Our concept of disease is wrong |
| ... |
 Trump News TV from Michael_Novakhov (10 sites) Trump News TV from Michael_Novakhov (10 sites) | 11h | |
|
|
|
 | ABC News's YouTube Videos: China's Xi Jinping meets with Putin in Moscow |
| ... |
 Trump News TV from Michael_Novakhov (10 sites) Trump News TV from Michael_Novakhov (10 sites) | 11h | |
|
|
|
 | ABC News's YouTube Videos: Trump claims his arrest is imminent in hush money case |
| ... |
 Trump News TV from Michael_Novakhov (10 sites) Trump News TV from Michael_Novakhov (10 sites) | 11h | |
|
|
|
 | Offenders in custody after 2nd string of robberies in Rivers Casino, Mariano's parking... |
| Courtney Spinelli reports on the latest details from the story. More on the story: https://wgntv.com/news/northwest-suburbs/offenders-in-custody-... |
| |
|
|
|
 | 2 Illinois teens die in sledding accident in Colorado after landing on ice |
| Ray Cortopassi provides the latest details on two Illinois teens' deaths in Colorado. |
| |
|
|
|
 | Donald Trump asegura que será arrestado en los próximos días | LDSD | WapaTV |
| El expresidente de los Estados Unidos, Donald Trump, aseguró que será arrestado el próximo martes 21... |
| |
|
|
|
 | Why do MAGA Trumpists love authoritarianism? |
| 👍 Get 10% off the Füm Journey Pack with code PAKMAN at https://tryfum.com -- Why do modern Republicans,... |
 David Pakman Show David Pakman Show | 12h | |
|
|
|
 | Police searching for hit-and-run driver in fatal Sun Valley crash on Friday |
| The crash happened at 6:15 a.m. Friday morning, when the driver of a white flatbed truck struck a bicyclist... |
 CBS Los Angeles CBS Los Angeles | 12h | |
|
|
|
 | China's President Xi Jinping meets with Russian President Putin in Moscow |
| Russian President Vladimir Putin held his first meeting with a foreign leader since the International... |
| |
|
|
|
 | Charles Blow: There's no equivalent to what Trump's allegedly done vs. other presidents,... |
| The potential indictment of Donald J. Trump over allegations that he illegally paid hush money to adult... |
| |
|
|
|
 | Macron survives no-confidence vote making new French pension plan law |
| French President Macron narrowly survived a no-confidence vote after forcing through a controversial... |
| |
|
|
|
 | Flight attendants push for renewed infant seat policy |
| There's a renewed push from the Association of Flight Attendants for lawmakers to change infant flight... |
| |
|
|
|
 | Stay Tuned NOW with Gadi Schwartz - March 20 | NBC News NOW |
| California braces for its 12th atmospheric river this season amid widespread flooding, a United Nations... |
| |
|
|
|
 | 'Window dressing': China's proposed peace plan to end Ukraine war |
| Lowy Institute senior fellow Richard McGregor says China's proposed peace plan to end the Ukraine war... |
 SkyNewsAustralia SkyNewsAustralia | 12h | |
|
|
|
 | Astronaut turned best-selling author: Chris Hadfield |
| Retired astronaut Chris Hadfield is now a New York Times best-selling author. "It's amazing where... |
 SkyNewsAustralia SkyNewsAustralia | 12h | |
|
|
|
 | Estas son las zonas más afectadas por el sismo en Ecuador #Shorts | Noticias Telemundo |
| Short oficial de Noticias Telemundo. El luto embarga a las comunidades afectadas por el sismo de este... |
 NOTICIAS TELEMUNDO NOTICIAS TELEMUNDO | 12h | |
|
|
|
 | Múltiples distritos escolares demandan a redes sociales #Shorts | Noticias Telemundo |
| Short oficial de Noticias Telemundo. Distritos escolares en estados como California, Washington, Pennsylvania,... |
 NOTICIAS TELEMUNDO NOTICIAS TELEMUNDO | 12h | |
|
|
|
 | Los Ángeles se prepara para unas cuatro pulgadas de lluvia #Shorts | Noticias Telemundo |
| Short oficial de Noticias Telemundo. Miles de residentes del condado Tulare, en el Valle Central de California,... |
 NOTICIAS TELEMUNDO NOTICIAS TELEMUNDO | 12h | |
|
|
|
 | Potential Trump arrest: Complete coverage on legal & political ramifications | LiveNOW... |
| LiveNOW from FOX explores a potential indictment of former president Donald Trump and how it could affect... |
 FOX 10 Phoenix FOX 10 Phoenix | 12h | |
|
|
|
 | Texas school shooting: suspect arrested after killing 1 student, injuring another... |
| One student was killed and another was hurt following a shooting at Lamar High School in Arlington. The... |
 FOX 10 Phoenix FOX 10 Phoenix | 12h | |
|
|
|
 | Dr. Mark Hyman: Our concept of disease is wrong |
| Physician Dr. Mark Hyman provides insight on health and nutrition on 'Tucker Carlson Tonight.' Subscribe... |
| |
|
|
|
 | Should there be live video of Supreme Court arguments? | Dan Abrams Live |
| Sens. Dick Durbin and Chuck Grassley have reintroduced a bill that would compel the Supreme Court to... |
 NewsNation Now NewsNation Now | 12h | |
|
|
|
 | Stephen Smith family attorney: Involvement in case has 'nothing to do' with Buster... |
| The family of Stephen Smith wants a new investigation into his death. Ronnie Richter, an attorney for... |
 NewsNation Now NewsNation Now | 12h | |
|
|
|
 | Trump supporters rally in NYC ahead of possible arrest |
| Members of the New York Young Republican Club gathered in front of the Manhattan District Attorney's... |
| |
|
|
|
 | NYC preparing for possible protests if Trump indicted |
| The NYPD is preparing for any protests that might happen if former President Donald Trump is indicted... |
| |
|
|
|
 | Security fears mount over possible Trump arrest amid New York investigation |
| Former U.S. president Donald Trump says he's expecting to be arrested in a criminal case involving hush... |
 Global News Global News | 12h | |
|
|
|
 | Suspect flees LAPD officers on skateboard | ABC News |
| After a suspect lost control of his pickup truck while being pursued by police in Los Angeles — he took... |
| |
|
|
|
 | China's Xi Jinping meets with Putin in Moscow |
| The three-day summit is President Xi Jinping's first visit to the country since Russia's invasion of... |
| |
|
|
|
 | Stocks close higher as officials seek to stabilize banking turmoil |
| Stocks closed higher on Monday after coordinated action from the Federal Reserve and other leading central... |
| |
|
|
|
 | Breaking down the Trump-Stormy Daniels hush money investigation |
| It was five years ago that the story first broke about hush money payments by a lawyer for then-President... |
| |
|
|
|
 | How Fairleigh Dickinson Did It | Hang Up and Listen Podcast |
| Stefan Fatsis, Josh Levin, are joined by Slate's Alex Kirshner to talk about Fairleigh Dickinson's huge... |
 Slate Video Slate Video | 12h | |
|
|
|
 | Trump Supporters And Detractors Gather Outside Of Manhattan D.A. Alvin Bragg's Office |
| Supporters and detractors of former President Trump gather outside of Manhattan D.A. Alvin Bragg's office.... |
 Forbes Under 30 Forbes Under 30 | 12h | |
|
|
|
 | 'We Saved Small Businesses': Gerry Connolly Touts Pandemic Era Economic Spending |
| During a House Oversight Committee hearing about 'Waste, Fraud, And Abuse' earlier this month, Rep. Gerry... |
 Forbes Under 30 Forbes Under 30 | 12h | |
|
|
|
 | 'Major Relief': Dick Durbin Applauds Eli Lilly's Insulin Price Cap |
| During Senate Floor remarks earlier this month, Sen. Dick Durbin (D-IL) spoke about the price of insulin.... |
 Forbes Under 30 Forbes Under 30 | 12h | |
|
|
|
 | Tim Hortons customer sues for $500K after being burned by hot tea |
| Warning: This video contains disturbing images. Discretion advised. A 73-year-old Ontario woman and... |
 Global News Global News | 12h | |
|
|
|
 | NHL Pride Nights face participation problems |
| While the NHL has been drawing praise for its efforts to be more inclusive by holding Pride Nights, the... |
 Global News Global News | 12h | |
|
|
|
 | Life in Iraq 20 years after U.S. invasion |
| The U.S. invaded Iraq 20 years ago, launching a ferocious bombing campaign in the country once-led by... |
| |
|
|
|
 | msnbcleanforward's YouTube Videos: Women CEOs discuss business, politics and the... |
| ... |
 Trump News TV from Michael_Novakhov (10 sites) Trump News TV from Michael_Novakhov (10 sites) | 12h | |
|
|
|
 | CBSNewsOnline's YouTube Videos: Breaking down the Trump-Stormy Daniels hush money... |
| ... |
 Trump News TV from Michael_Novakhov (10 sites) Trump News TV from Michael_Novakhov (10 sites) | 12h | |
|
|
|
 | CBSNewsOnline's YouTube Videos: NYPD prepares for possible protests as Trump claims... |
| ... |
 Trump News TV from Michael_Novakhov (10 sites) Trump News TV from Michael_Novakhov (10 sites) | 12h | |
|
|
|
 | CBSNewsOnline's YouTube Videos: Republicans react to possibility a Trump indictment... |
| ... |
 Trump News TV from Michael_Novakhov (10 sites) Trump News TV from Michael_Novakhov (10 sites) | 12h | |
|
|
|
 | CBSNewsOnline's YouTube Videos: New York grand jury hears from final witnesses in... |
| ... |
 Trump News TV from Michael_Novakhov (10 sites) Trump News TV from Michael_Novakhov (10 sites) | 12h | |
|
|
|
 | CBSNewsOnline's YouTube Videos: Los Angeles school workers set to go on strike |
| ... |
 Trump News TV from Michael_Novakhov (10 sites) Trump News TV from Michael_Novakhov (10 sites) | 12h | |
|
|
|
 | CBSNewsOnline's YouTube Videos: Senator Mark Warner on Xi-Putin summit |
| ... |
 Trump News TV from Michael_Novakhov (10 sites) Trump News TV from Michael_Novakhov (10 sites) | 12h | |
|
|
|
 | msnbcleanforward's YouTube Videos: Meacham on possible Trump NY indictment: 'We're... |
| ... |
 Trump News TV from Michael_Novakhov (10 sites) Trump News TV from Michael_Novakhov (10 sites) | 12h | |
|
|
|
 | CBSNewsOnline's YouTube Videos: U.N. report warns "humanity is on thin ice"... |
| ... |
 Trump News TV from Michael_Novakhov (10 sites) Trump News TV from Michael_Novakhov (10 sites) | 12h | |
|
|
|
 | Wapa TV's YouTube Videos: Abogados de Bad Bunny responden a la demanda de su exnovia... |
| ... |
 Puerto Rico News Videos from Michael_Novakhov (20 sites) Puerto Rico News Videos from Michael_Novakhov (20 sites) | 12h | |
|
|
|
 | Abogados de Bad Bunny responden a la demanda de su exnovia | LDSD | WapaTV |
| La que fuera novia del artista puertorriqueño Bad Bunny desde el año 2011 hasta el 2016 lo demandó por... |
| |
|
|
|
 | Cast of 'Ted Lasso' raises mental health awareness at White House |
| The cast of 'Ted Lasso' joined White House Press Secretary Karine Jean-Pierre at a daily briefing where... |
| |
|
|
|
 | Meet Manhattan's DA who could soon indict Donald Trump |
| Meet Manhattan's District Attorney Alvin Bragg, the man who might become the first prosecutor to hand... |
| |
|
|
|
 | Women CEOs discuss business, politics and the economy with Symone Sanders-Townsend |
| Three women CEOs including Pamela Wagner, Jo Norris and Radin Rahimzadheh sat down with Symone D. Sanders-Townsend... |
| |
|
|
|
 | Coalition set to support Voice machinery bill despite 'unhappiness' in party room |
| Sky News Political Editor Andrew Clennell reveals the machinery bill setting up the Voice to Parliament... |
 SkyNewsAustralia SkyNewsAustralia | 12h | |
|
|
|
 | 'Mortgage prison': RBA analysis reveals 1 in 5 are trapped |
| InvestSMART Chief Market Strategist Evan Lucas says "mortgage prison" is the idea of purchasing a house... |
 SkyNewsAustralia SkyNewsAustralia | 12h | |
|
|
|
 | NSW will have 'bigger deficits, bigger debt' under Dominic Perrottet and Matt Kean |
| New South Wales Shadow Treasurer Daniel Mookhey says the Parliamentary Budget Office made it clear that... |
 SkyNewsAustralia SkyNewsAustralia | 12h | |
|
|
|
 | First LGBTQI-owned racehorse syndicate clearly a 'money-making' opportunity |
| A racehorse will be riding in pride flag silks after Victorian trainer Archie Alexander launched "Project... |
 SkyNewsAustralia SkyNewsAustralia | 12h | |
|
|
|
 | Former astronaut to speak at Australian Cyber Conference |
| Cyber security advocate and retired astronaut Chris Hadfield will be a keynote speaker at the Australian... |
 SkyNewsAustralia SkyNewsAustralia | 12h | |
|
|
|
 | Cast of Ted Lasso discusses mental health at the White House |
| The cast of the popular television series Ted Lasso attended a daily briefing at the White House on Monday.... |
 SkyNewsAustralia SkyNewsAustralia | 12h | |
|
|
|
 | O'Reilly predicts push for charges against Biden family if Trump is indicted |
| Political payback? Bill O'Reilly tells Chris Cuomo he thinks the House of Representatives will refer... |
 NewsNation Now NewsNation Now | 12h | |
|
|
|
 | Strategist: Possible Trump indictment may 'play to Trump's benefit' | Dan Abrams... |
| Former President Donald Trump claims he will be arrested Tuesday but has not provided any specific proof.... |
 NewsNation Now NewsNation Now | 12h | |
|
|
|
 | Homeless encampments overwhelm Phoenix businesses |
| Rampant homelessness in Phoenix, Arizona, is impacting small business owners who are struggling to stay... |
 NewsNation Now NewsNation Now | 12h | |
|
|
|
 | 16 on FBI terror watch list arrested at border last month | Dan Abrams Live |
| A total of 16 people on the FBI's terror watch list were arrested at the southern border last month.... |
 NewsNation Now NewsNation Now | 12h | |
|
|
|
 | $15M gift to Hostos helps students afford Ivy League |
| A Bronx mother of three is going to have her Ivy League education paid for, all thanks to a new scholarship. |
| |
|
|
|
 | Trump claims his arrest is imminent in hush money case |
| The Manhattan grand jury weighing charges against the former president heard testimony Monday from defense... |
| |
|
|
|
 | NYPD prepares for possible protests as Trump claims arrest is coming |
| Police in New York are setting up metal barricades near the Manhattan courthouse as the investigation... |
| |
|
|
|
 | Republicans react to possibility a Trump indictment could come soon |
| Prominent Republicans are speaking out as the Manhattan district attorney appears to be nearing an indictment... |
| |
|
|
|
 | Melanie Stansbury Hones In On Essential Tools To Mitigate Waste And Fraud Within... |
| During a House Oversight Committee hearing about 'Waste, Fraud, And Abuse' earlier this month, Rep. Melanie... |
 Forbes Under 30 Forbes Under 30 | 12h | |
|
|
|
 | 'Fighting Us Every Step Along The Way': Raskin Fires Back At Perry Over Lowering... |
| In remarks on the House floor earlier this month, Rep. Scott Perry (R-PA) and Rep. Jamie Raskin (D-MD)... |
 Forbes Under 30 Forbes Under 30 | 12h | |
|
|
|
 | Buster Murdaugh speaks out over high school classmate's death |
| Buster Murdaugh, Alex Murdaugh's son, is speaking out over Stephen Smith's death amid renewed attention... |
| |
|
|
|
 | Hallie Jackson NOW - March 20 | NBC News NOW |
| California braces for its 12th atmospheric river this season amid widespread flooding, New York City... |
| |
|
|
|
 | UnivisionNoticias's YouTube Videos: Lucha de la Nación Navajo por derechos sobre... |
| ... |
 Puerto Rico News Videos from Michael_Novakhov (20 sites) Puerto Rico News Videos from Michael_Novakhov (20 sites) | 13h | |
|
|
|
 | UnivisionNoticias's YouTube Videos: "Ninguna víctima es culpable": este luchador... |
| ... |
 Puerto Rico News Videos from Michael_Novakhov (20 sites) Puerto Rico News Videos from Michael_Novakhov (20 sites) | 13h | |
|
|
|
 | Wapa TV's YouTube Videos: Juicio contra Ángel Pérez entra en su etapa crucial esta... |
| ... |
 Puerto Rico News Videos from Michael_Novakhov (20 sites) Puerto Rico News Videos from Michael_Novakhov (20 sites) | 13h | |
|
|
|
 | Wapa TV's YouTube Videos: Factores para lograr una longevidad significativa y saludable... |
| ... |
 Puerto Rico News Videos from Michael_Novakhov (20 sites) Puerto Rico News Videos from Michael_Novakhov (20 sites) | 13h | |
|
|
|
 | UnivisionNoticias's YouTube Videos: Reunión entre Putin y Xi Jinping: EEUU advierte... |
| ... |
 Puerto Rico News Videos from Michael_Novakhov (20 sites) Puerto Rico News Videos from Michael_Novakhov (20 sites) | 13h | |
|
|
|
 | UnivisionNoticias's YouTube Videos: Familiares de víctimas de la masacre en Uvalde... |
| ... |
 Puerto Rico News Videos from Michael_Novakhov (20 sites) Puerto Rico News Videos from Michael_Novakhov (20 sites) | 13h | |
|
|
|
 | Juicio contra Ángel Pérez entra en su etapa crucial esta semana | LDSD | WapaTV |
| Esta semana marca un momento clave en el juicio del exalcalde de Guaynabo, Ángel Pérez, ya que la Fiscalía... |
| |
|
|
|
 | KCAL News reporter Michele Gile recognized by Orange County for National Women's... |
| A big congratulations to KCAL News reporter Michele Gile! The accomplished newswoman was recognized for... |
 CBS Los Angeles CBS Los Angeles | 13h | |
|
|
|
 | Brief pursuit with DUI suspect ends in crash in city of Commerce |
| Desmond Shaw was over the scene of a crash stemming from a police pursuit in the city of Commerce on... |
 CBS Los Angeles CBS Los Angeles | 13h | |
|
|
|
 | New York grand jury hears from final witnesses in Trump investigation |
| Former President Donald Trump is facing the possibility of an indictment by the Manhattan district attorney... |
| |
|
|
|
 | Los Angeles public school workers set to go on strike |
| Unless a deal can be made, Los Angeles public schools will be shut down Tuesday as workers are set to... |
| |
|
|
|
 | Sen. Mark Warner on Xi-Putin summit in Russia |
| Chinese President Xi Jinping visited Moscow for a summit with Russian President Vladimir Putin. Sen.... |
| |
|
|
|
 | U.N. report warns "humanity is on thin ice" and must act to avert climate... |
| The world must take action to "defuse the climate time bomb," the United Nations secretary-general said... |
| |
|
|
|
 | Meacham on possible Trump NY indictment: 'We're at the beginning of this drama' |
| "I believe firmly that this generation will be judged by our success or our failure at standing up to... |
| |
|
|
|
 | Lucha de la Nación Navajo por derechos sobre el agua del río Colorado llega hasta... |
| Frente a la Corte Suprema la tribu Navajo presentó argumentos sobre la falta de agua en sus comunidades.... |
 Univision Noticias Univision Noticias | 13h | |
|
|
|
 | "Ninguna víctima es culpable": este luchador mexicano combate contra el bullying... |
| El Tacubo es un luchador profesional de Ciudad de México que asegura es un sobreviviente de diferentes... |
 Univision Noticias Univision Noticias | 13h | |
|
|
|
 | Global National: March 20, 2023 | What Xi and Putin's talks on deeper ties could... |
| Chinese President Xi Jinping is in Moscow, getting some face time with his friend Russian President Vladimir... |
 Global News Global News | 13h | |
|
|
|
 | Murdaugh attorney blasts 'vile' rumors linking Buster to teen's death | CUOMO |
| As Alex Murdaugh sits in prison serving two consecutive life sentences for killing his wife Maggie and... |
 NewsNation Now NewsNation Now | 13h | |
|
|
|
 | Trump denied 'fair shot' in media coverage? Cuomo, O'Reilly debate | CUOMO |
| Former President Donald Trump frequently complains that the media only reports negative stories about... |
 NewsNation Now NewsNation Now | 13h | |
|
|
|
 | How the NYPD is preparing for a possible Trump indictment |
| CNN's Shimon Prokupecz and former FBI deputy director Andrew McCabe discuss the steps law enforcement... |
| |
|
|
|
 | Update from Ukraine | China made drones cut Ruzzian supplies in Crimea | Prygozhyn... |
| 🔥 Support Pilot Blog on Patreon! https://www.patreon.com/PilotBlog 🔥 Donate here: https://donatello.to/DenyDay... |
 Denys Davydov Denys Davydov | 13h | |
|
|
|
 | Instalan barricadas fuera de la Torre Trump en NYC | El Minuto (Spanish) |
| Todos los ojos están puestos en Manhattan esta semana por la posibilidad de que Donald Trump pueda ser... |
 NBC New York NBC New York | 13h | |
|
|
|
 | Barricades Set Up Outside Trump Tower as NYC Readies for Protests | El Minuto (English) |
| All eyes are on Manhattan this week for the possibility that Donald Trump could be indicted by a grand... |
 NBC New York NBC New York | 13h | |
|
|
|
 | Schiff: GOP targeting Manhattan DA is right from 'autocratic playbook' |
| Rep. Adam Schiff on House Republicans targeting the DA as Trump braces for an indictment: "The cost to... |
| |
|
|
|
 | msnbcleanforward's YouTube Videos: Schiff: GOP targeting Manhattan DA is right from... |
| ... |
 Trump News TV from Michael_Novakhov (10 sites) Trump News TV from Michael_Novakhov (10 sites) | 13h | |
|
|
|
 | CBSNewsOnline's YouTube Videos: 3/20: CBS News Prime Time |
| ... |
 Trump News TV from Michael_Novakhov (10 sites) Trump News TV from Michael_Novakhov (10 sites) | 13h | |
|
|
|
 | MidweekPolitics's YouTube Videos: Trump says he'll be arrested, world braces for... |
| ... |
 Trump News TV from Michael_Novakhov (10 sites) Trump News TV from Michael_Novakhov (10 sites) | 13h | |
|
|
|
 | msnbcleanforward's YouTube Videos: Trump grand jury may make final decision on Wednesday,... |
| ... |
 Trump News TV from Michael_Novakhov (10 sites) Trump News TV from Michael_Novakhov (10 sites) | 13h | |
|
|
|
 | Lindsey Graham Directly Responds To Heckler Calling Him 'Warmonger' |
| At an appearance on Saturday, Sen. Lindsey Graham (R-SC) dealt with a heckler calling him a "warmonger."... |
 Forbes Under 30 Forbes Under 30 | 13h | |
|
|
|
 | 'A Concerning Prospect': Bill Hagerty Doubts The Fed's Adherence To Legislative Requirements |
| Jerome Powell, the Chairman of the Federal Reserve, was questioned by Senator Bill Hagerty (R-TN) while... |
 Forbes Under 30 Forbes Under 30 | 13h | |
|
|
|
 | 'Listen To Me': Dem Lawmaker Warns Powell The US Is On The Verge Of Making A 'Terrible... |
| During a House Financial Services committee hearing earlier this month, Rep. David Scott (D-GA) questioned... |
 Forbes Under 30 Forbes Under 30 | 13h | |
|
|
|
 | 'People Are Voting With Their Feet': Mario Diaz-Balart Lawmaker Discusses People... |
| At a House Republican bilingual press briefing on Monday, Rep. Mario Diaz-Balart (R-FL) spoke about Florida.... |
 Forbes Under 30 Forbes Under 30 | 13h | |
|
|
|
 | US prepares for likely historic arrest of former president Trump • FRANCE 24 English |
| America readied itself Monday ahead of the possible historic indictment of Donald Trump over a hush-money... |
 FRANCE 24 English FRANCE 24 English | 13h | |
|
|
|
 | Trump says he'll be arrested, world braces for chaos 3/20/23 TDPS Podcast |
| ♨️ Use code PAKMAN15 for 15% off the Infrared Sauna Blanket at https://boncharge.com/pakman NEW SHOW:... |
 David Pakman Show David Pakman Show | 13h | |
|
|
|
 | Wall Street ends higher as bank contagion fears ease |
| U.S. stocks ended higher after a deal to rescue Credit Suisse and central bank efforts to bolster confidence... |
| |
|
|
|
 | Vaccine makers prep bird flu shots for humans |
| Hundreds of millions of bird flu shots for humans could be ready to go within months if a new strain... |
| |
|
|
|
 | French President Emmanuel Macron survives a no confidence vote |
| The French government barely survived a no-confidence vote in the National Assembly in a relief to President... |
| |
|
|
|
 | Factores para lograr una longevidad significativa y saludable | Viva La Tarde | WapaTV |
| El doctor Jaime Claudio nos contó sobre un estudio que identificó cuáles son los factores clave para... |
| |
|
|
|
 | Conéctate a Filtro 360 |
| El profesor G-Padilla te pone al día sobre lo que está pasando en la NBA |
 primerahoravideos primerahoravideos | 13h | |
|
|
|
 | Xi Jinping's meeting with Putin, 20 years since Iraq War and more | Prime Time with... |
| John Dickerson reports on Vladimir Putin's meeting with Xi Jinping, the war in Iraq 20 years later, and... |
| |
|
|
|
 | Elementary teacher shot by six-year-old student speaks out about challenges faced |
| Elementary teacher shot by six-year-old student speaks out about challenges faced In an exclusive interview... |
| |
|
|
|
 | Nightly News Full Broadcast - March 20 |
| Trump predicts he'll be arrested, calls for protests; Chinese President Xi visits Russia, calls Putin... |
| |
|
|
|
 | Shazam, The Magic Flute and more | The Lot |
| We talk to Zachary Levi from "Shazam", stars from "The Magic Flute" and "Unprisoned" + what's new in... |
 CBS Los Angeles CBS Los Angeles | 13h | |
|
|
|
 | LAUSD providing family resources during employee strike |
| With nearly 60,000 LAUSD employees partaking in a three-day strike this week, the Los Angeles Unified... |
 CBS Los Angeles CBS Los Angeles | 13h | |
|
|
|
 | Reunión entre Putin y Xi Jinping: EEUU advierte que impondrá sanciones si hay ayuda... |
| Vladimir Putin recibió en Moscú a su homólogo chino, Xi Jinping, en lo que es considerado por muchos... |
 Univision Noticias Univision Noticias | 13h | |
|
|
|
 | Familiares de víctimas de la masacre en Uvalde reaccionan a nuevas revelaciones de... |
| Una investigación del Texas Tribune basada en las cámaras corporales de los agentes que respondieron... |
 Univision Noticias Univision Noticias | 13h | |
|
|
|
 | Buster Murdaugh breaks silence over teen's mystery death |
| Buster Murdaugh – the surviving son of convicted murderer Alex Murdaugh- has broken his silence over... |
 SkyNewsAustralia SkyNewsAustralia | 13h | |
|
|
|
 | White House briefing descends into chaos with Ted Lasso stars |
| Monday's White House press briefing descended into chaos after a reporter began shouting at Press Secretary... |
 SkyNewsAustralia SkyNewsAustralia | 13h | |
|
|
|
 | NSW will see 'more privatisation' under Dominic Perrottet |
| NSW Shadow Water and Housing Minister Rose Jackson says it is clear under the NSW Liberal government,... |
 SkyNewsAustralia SkyNewsAustralia | 13h | |
|
|
|
 | Legendary Australian actor Terry Norris dies aged 92 |
| Legendary Australian character actor Terry Norris has died aged 92. Mr Norris was known for his... |
 SkyNewsAustralia SkyNewsAustralia | 13h | |
|
|
|
 | The Greens and crossbenchers threatening to block Housing Australia Future Fund |
| The Greens and crossbenchers are threatening to block Labor's $10 billion Housing Australia Future Fund... |
 SkyNewsAustralia SkyNewsAustralia | 13h | |
|
|
|
 | It is 'really important' for the safeguard mechanism reform legislation to pass |
| Independent MP for Warringah Zali Steggall says it is "really important" that we pass the legislation... |
 SkyNewsAustralia SkyNewsAustralia | 13h | |
|
|
|
 | Labor MPs breaking ranks on AUKUS 'shatters consensus' within the party |
| Three Labor MPs breaking ranks and voicing their concerns about the AUKUS deal "shatters consensus" within... |
 SkyNewsAustralia SkyNewsAustralia | 13h | |
|
|
|
 | 'Thank-you for the work': Amazon to lay-off 9,000 more employees |
| Amazon has confirmed it will lay-off 9,000 employees after shedding around 18,000 staff in January amid... |
 SkyNewsAustralia SkyNewsAustralia | 13h | |
|
|
|
 | White House urges China to press Putin to withdraw troops from Ukraine |
| The White House says President Xi Jinping needs to be more forceful with his "dear friend" President... |
 SkyNewsAustralia SkyNewsAustralia | 13h | |
|
|
|
 | France protests: Police charge demonstrators, make arrests hours after pension bill... |
| Police in Paris charged at demonstrators and made arrests on Monday night as protesters took to the streets... |
 Global News Global News | 13h | |
|
|
|
 | Political payback if Trump indicted? O'Reilly says yes | CUOMO |
| If former President Donald Trump is indicted, author and journalist Bill O'Reilly makes a "stunning prediction"... |
 NewsNation Now NewsNation Now | 13h | |
|
|
|
 | The war that shattered American credibility #gzeroworld #shorts |
| |
 GZERO Media GZERO Media | 13h | |
|
|
|
 | Moose on the Loose: St. John's hires Rick Pitino |
| St. John's has hired Hall of Fame basketball coach Rick Pitino. PIX11's Marc Malusis shares his thoughts... |
| |
|
|
|
 | Outcry over understaffing across Chicago area nursing homes: 'Families deserve better' |
| Nursing home workers are sounding the alarm on what they say is a matter of public safety: dangerously... |
| |
|
|
|
 | Tucker: This is an abuse of power |
| Fox News host Tucker Carlson calls out the possible indictment of former President Trump over alleged... |
| |
|
|
|
 | Trump grand jury may make final decision on Wednesday, says Dienst |
| "Wednesday could be a day that we learn much more about a decision or progress in this investigation.... |
| |



No comments:
Post a Comment